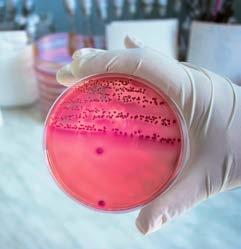

ICH BIN KLINIKUM NÜRNBERG.

























02 | Editorial 004 - 005 03 | Grußworte 006 - 011 04 | Interview Vorstand 012 - 017 05 | Geschichtlicher Rückblick 018 - 029 06 | Meilensteine 1994 - 2022 030 - 031 07 | Krankenhaus im Grünen 032 - 037 08 | Krankenhausfusion 038 - 039 09 | Wir sind Universität 040 - 043 10 | In der Pandemie 044 - 047 11 | Beste Medizin für Alle 048 - 049 12 | Unsere Kliniken 050 - 052 13 | Unsere Institute 053 14 | Das Klinikum als Vorreiter 054 - 073 15 | Medizin wird digital 074 - 075 16 | Gut ambulant versorgt 076 - 079 17 | 125 Jahre Pflege 080 - 083 18 | Profis in der Pflege 084 - 085 19 | Begegnung der Kulturen 086 - 089 20 | Bildung und Wissenschaft 090 - 099 21 | Klinikum im Wandel 100 - 103 22 | Stifter und Förderer 104 - 111 23 | Wir begleiten im Ehrenamt 112 - 115 24 | Gewachsene Architektur 116 - 121 25 | Bauen für die Zukunft 122 - 123 26 | Service als Auftrag 124 - 127 27 | Das verbinde ich mit dem Klinikum 128 - 135 28 | Das gibts nur am Klinikum 136 - 141 29 | Impressum 142
Liebe Leserin, lieber Leser, vor 125 Jahren – da hatte Wilhelm Conrad Röntgen gerade die Röntgenstrahlen entdeckt Dass es verschiedene Blutgruppen gibt, war noch unbekannt Und die bahnbrechende Entdeckung des Antibiotikums sollte noch knapp 30 Jahre dauern: Unter diesen Rahmenbedingungen ist 1897 das städtische Krankenhaus an der Flurstraße in Nürnberg eröffnet worden Eine weitsichtige Entscheidung
125 Jahre später kann das Klinikum Nürnberg auf eine bewegte, aber auch sehr erfolgreiche Geschichte zurückblicken Mit seinen 42 Kliniken, Abteilungen und Instituten, knapp 7000 Beschäftigten und über 2200 Betten gehört es heute zu den größten kommunalen Krankenhäusern in Deutschland Wie leistungsfähig das Klinikum Nürnberg ist, hat es gerade jetzt, während der Pandemie, eindrucksvoll unter Beweis gestellt
125 Jahre – das ist ein guter Zeitpunkt, um innezuhalten und Sie in diesem Jubiläumsheft auf eine Reise mitzunehmen: von den Anfängen im Nürnberger Stadtteil St Johannis über die Überführung in ein Kommunalunternehmen, den Bau des Klinikums Nürnberg Süd bis zur Entwicklung einer universitären Medizin in Kooperation mit der Paracelsus Medizinischen Privatuniversität Salzburg Wir werfen auch einen Blick in die Zukunft, an der im Wortsinn gebaut wird
Wir stellen Ihnen außerdem Mitarbeiterinnen und Mitarbeiter vor, die Rückgrat und Stütze unseres Hauses sind Ohne ihre große Kompetenz und Leidenschaft wäre unser Haus nicht das, was es heute ist Das gilt auch für die stete Unterstützung der Stadt Nürnberg, seiner Oberbürgermeister und des Stadtrats, die sich immer zu „ihrem“ Klinikum Nürnberg bekannt haben, wie auch der Freistaat mit seiner jahrzehntelangen Förderung Dafür herzlichen Dank!
1897
Peter Schuh, Vorstand Personal und Patientenversorgung, Prof Dr med Achim Jockwig, Vorstandsvorsitzender und Vorstand Medizin und Strategie, und Dr Andreas Becke, Vorstand Infrastruktur und Finanzen (v l n r ), leiten die Geschicke des Klinikums Nürnberg
Dank gilt auch den großen Förderern des Klinikums, allen voran Dr Elisabeth Birkner und der SchöllerStiftung
Als Maximalversorger wollen wir auch weiterhin allen Patientinnen und Patienten Spitzenmedizin auf höchstem Niveau bieten Die Zufriedenheit der Menschen, die sich uns anvertrauen, ist unser Antrieb
Wir wünschen Ihnen viel Freude beim Lesen und beim Entdecken neuer Seiten des Klinikums
Prof Dr med Achim Jockwig Dr Andreas Becke Peter Schuh


Das neue Klinikum bestand aus 30 Gebäuden mit 760 Betten 160 Mitarbeiterinnen und Mitarbeiter kümmerten sich um die Patienten In seiner 125-jährigen Geschichte hat sich das Klinikum zu einem der größten kommunalen Krankenhäuser der Maximalversorgung in Deutschland entwickelt
Marcus König Oberbürgermeister von Nürnberg125 Geburtstage sind in der Krankenhauslandschaft eher selten Daher gratuliere ich dem städtischen Klinikum Nürnberg ganz herzlich zu diesem Jubiläum
Die Erfolgsgeschichte begann mit einer wegweisenden kommunalpolitischen Entscheidung 1890: dem Neubau eines Krankenhauses in Pavillonbauweise Dies ermöglichte hohe Flexibilität in einer wachsenden Stadt Mit diesem Beschluss begann eine neue Ära für das Nürnberger Gesundheitswesen
Die Eröffnung des „Städtischen Krankenhauses“ an der Flurstraße fand am 5 September 1897 statt
An den Standorten im Norden und seit 1994 auch im Süden sind mittlerweile – Tochtergesellschaften und die Auszubildenden mitgerechnet – 8700 Mitarbeiterinnen und Mitarbeiter beschäftigt Die Zahl der Betten hat sich fast verdreifacht
Als Stadt – und ich persönlich als Oberbürgermeister – bekennen wir uns zu dem seit 1998 selbstständigen gemeinnützigen Kommunalunternehmen Hier wird Spitzenmedizin in allen Disziplinen für alle Menschen aus der Metropolregion und darüber hinaus geboten Den Mitarbeiterinnen und Mitarbeitern danke ich – besonders in der Zeit der Corona-Pandemie – für ihren außerordentlichen Einsatz Ich bin sicher, wir werden diese Erfolgsgeschichte weiterschreiben



Stadt und der gesamten Metropolregion eine medizinische Maximalversorgung Medizinische Forschung und Lehre haben dort einen attraktiven Standort, die Krankenhäuser Nürnberger Land ergänzen die Versorgung in der Region
Als Nürnberg Ende des 19 Jahrhunderts beschloss, ein neues, modernes Städtisches Krankenhaus zu bauen, war das eine mutige und zukunftsweisende Entscheidung Die äußerst erfolgreiche Entwicklung der letzten 125 Jahre hat dies immer wieder bestätigt Das Haus war beim medizinischen Fortschritt und den Erfordernissen einer modernen Organisation von Anfang an ganz vorn dabei Heute ist das Klinikum Nürnberg mit rund 2200 Betten und mehr als 7000 Beschäftigten eines der größten städtischen Krankenhäuser Europas Mit seinen zahlreichen Fachabteilungen bietet es der
Nürnberg ist zu Recht stolz darauf, eine so herausragende medizinische Einrichtung in der Stadt zu haben Das Klinikum steht für High-TechMedizin und Menschlichkeit Doch es geht nicht allein um Spitzenmedizin, entscheidend ist eine insgesamt optimale Betreuung der Patientinnen und Patienten Exzellent ausgebildetes, motiviertes und freundliches Personal ist ausschlaggebend für den Erfolg der Klinik Für ihr Engagement verdienen die Beschäftigten Dank und Anerkennung, besonders in Zeiten der Pandemie
Dem Klinikum Nürnberg herzlichen Glückwunsch zum Jubiläum und weiterhin eine erfolgreiche Arbeit!
Das Klinikum Nürnberg feiert in diesen Tagen seinen 125-jährigen Geburtstag Als Bayerischer Gesundheits- und Pflegeminister gratuliere ich ganz herzlich!

Als das Städtische Krankenhaus an der Flurstraße am 5 September 1897 seine Zimmer und Operationssäle öffnete, war es eines der modernsten und großzügigsten Krankenhäuser seiner Zeit Heute kann die Stadt voller Stolz auch auf eines der größten kommunalen Krankenhäuser Europas blicken In einer Bauzeit von nicht einmal vier Jahren waren über 30 Einzelgebäude mit 760 Betten entstanden Nürnberg, dessen Einwohnerzahl sich um die Jahrhundertwende innerhalb kürzester Zeit verdoppelte, legte damit den Grundstein für eine herausragende medizinische Versorgung seiner Bürgerinnen und Bürger
gesamtgesellschaftlichen Verantwortung, hilfsbedürftigen Patientinnen und Patienten Zuwendung und Unterstützung zukommen zu lassen, fühlt sich die Stadt seit jeher besonders verpflichtet Wie kaum eine andere Kommune nimmt sie sich dieser Aufgabe bis heute in vorbildlicher Weise an So wurde das Klinikum Nürnberg zu einer der führenden medizinischen Einrichtungen bundesweit und genießt national wie international sehr hohes Ansehen Als Krankenhaus der Maximalversorgung ist Nürnberg nicht nur der zentrale Pfeiler für die akutstationäre Versorgung in der Region, sondern bietet auch eine große Bandbreite hochspezialisierter Leistungen, die seine Ausnahmestellung belegen Der Freistaat Bayern ist stolz auf diesen Leuchtturm in der bayerischen Medizinlandschaft!
Dem Klinikum und seiner Leitung wünsche ich auch in Zukunft eine stets glückliche Hand Allen Mitarbeiterinnen und Mitarbeitern sage ich ein herzliches Vergelt’s Gott für ihre aufopferungsvolle Arbeit und ihr großartiges Engagement im Dienste der Patientinnen und Patienten


Markus Blume MdL Bayerischer Staatsminister für Wissenschaft und Kunst


Schon 1897 arbeiteten die Nürnberger Städteplaner tatkräftig daran, das Leben in der Metropole zu verbessern – auch wenn manch eingefleischter Fußballfan dies bestreiten mag und darauf verweist, dass erst drei Jahre später mit der Gründung des Clubs die Lebensqualität deutlich zunahm So wurde zum Beispiel die Elektrifizierung der Straßenbahn vorangetrieben und das städtische Krankenhaus an der Flurstraße nahm seinen Betrieb auf
Auch heute ist der Standort im Norden Nürnbergs unverzichtbar für die medizinische Versorgung der Metropolregion – natürlich verstärkt durch
das Südklinikum: Mittlerweile zählt das Klinikum Nürnberg zu den größten kommunalen Krankenhäusern Europas Darüber hinaus ist es durch die Zusammenarbeit im Bereich der Hochschulmedizin eng mit dem Universitätsklinikum Erlangen und der TH Nürnberg verbunden und leistet in Kooperation mit der Salzburger Paracelsus Universität einen wichtigen Beitrag zur Ausbildung von jungen Medizinerinnen und Medizinern in Bayern
Zum 125 Jubiläum gratuliere ich dem Klinikum Nürnberg herzlich und freue mich mit Ihnen über die Erfolgsgeschichte dieses Hauses Ich wünsche dem Klinikum bei seiner künftigen Entwicklung alles Gute und bin mir sicher, dass die Patientinnen und Patienten weiterhin in besten Händen sind!

Referentin

Doch nicht nur für die Patientinnen und Patienten ist das Klinikum Nürnberg heute eine unverzichtbare Größe, sondern für die gesamte Krankenhauslandschaft in der Region und in ganz Bayern Diese Bedeutung zeigen auch die Zahlen: Rund 115 000 stationäre und 188 000 ambulante Patientinnen und Patienten werden in nicht-pandemischen Zeit im Klinikum Nürnberg im Jahr versorgt
Das Klinikum Nürnberg blickt in diesem Jahr auf seine 125-jährige Geschichte zurück Herzlichen Glückwunsch zu diesem besonderen Jahrestag
Seit 125 Jahren liegt Ihnen die Versorgung der Menschen auf hohem medizinischen, pflegerischen und menschlichen Niveau am Herzen Es freut mich sehr, dass wir so den Menschen in der Region eine medizinische Versorgung mit höchstem Anspruch bieten können
Von Beginn an baute das Klinikum sein Leistungsspektrum stetig aus Heute bilden 42 Kliniken, medizinische Institute und Abteilungen eine Einheit mit vielfältigen interdisziplinären Zentren

Ihr Jubiläum fällt jedoch in die Zeit der Pandemie Und gerade Corona hat die Bedeutung eines gut funktionierenden Gesundheitssystems noch einmal deutlich gemacht Das Klinikum Nürnberg ist bei der Bewältigung der Pandemie eine tragende Säule
Für diese erfolgreiche Arbeit des Klinikums Nürnberg spielen die Mitarbeiterinnen und Mitarbeiter eine entscheidende Rolle So ruht der Erfolg auf ihrer guten Zusammenarbeit, von den Servicebereichen bis zur Vorstandsebene
Ich danke Ihnen für Ihren Einsatz und wünsche Ihnen weiterhin viel Erfolg für Ihre Arbeit zum Wohle der Ihnen anvertrauten Patientinnen und Patienten


125 Jahre Klinikum Nürnberg
Prof Jockwig, wo steht das Klinikum Nürnberg 125 Jahre nach seiner Gründung?
Diese Zeitspanne ist zum Glück nicht mit der Lebenszeit eines Menschen vergleichbar Das Klinikum Nürnberg ist weder alt noch gebrechlich, sondern sehr agil und in vielen Bereichen an der Spitze der medizinischen Entwicklung Es hat eine sehr bewegte und mit der NS-Zeit auch eine sehr dunkle Zeit hinter sich Nach dem Zweiten Weltkrieg hat es sich zu einem großen ehrwürdigen Stadtkrankenhaus entwickelt Die Umwandlung in ein Kommunalunternehmen vor 25 Jahren war ein entscheidender Meilenstein auf dem Weg zu größerer Eigenständigkeit Ich erlebe das Klinikum heute als Innovationstreiber Ziel ist es, unsere universitäre Struktur aus Forschung, Lehre und Hochleistungsmedizin konsequent auszubauen
Sie haben die Struktur angesprochen: Das Klinikum Nürnberg muss als städtische Tochter keine Aktionärsinteressen bedienen Inwieweit profitieren die Patient*innen davon?
Das Gute ist, wir müssen zwar wirtschaftlich, aber nicht gewinnorientiert arbeiten Wir können uns ganz auf unseren Auftrag der kommunalen Daseinsvorsorge konzentrieren Wir können die Frage in den Mittelpunkt stellen: Was ist das Richtige und Beste für die uns anvertrauten Patient*innen? Was ist die richtige medizinische Indikation? Wir können alle Menschen diskriminierungsfrei behandeln – unabhängig davon, ob durch die Behandlung so viel erlöst wird, wie diese kostet, weil eben Patienten- und Mitarbeiterwohl und nicht das Aktionärswohl im Vordergrund stehen Dieser wichtige Punkt der Daseinsvorsorge kommt in der Krankenhausfinanzierung leider zu kurz, weil die Finanzierung ausschließlich von der Patienten- und Behandlungszahl abhängt Das ist so, als ob man die Feuerwehr ausschließlich nach der Zahl der gelöschten Brände bezahlen würde
Prof Dr med Achim Jockwig ist seit September 2017 Vorstandsvorsitzender des Klinikums Nürnberg, der 57-Jährige verantwortet als Vorstand auch die Bereiche Medizin und Strategie

Vor seinem Wechsel nach Nürnberg war der Facharzt für Innere Medizin und Gesundheitsökonom Vizepräsident der privaten, staatlich anerkannten Hochschule Fresenius und Geschäftsführender Direktor der Carl Remigius Medical School in Idstein bei Wiesbaden
Davor wiederum leitete Jockwig als Geschäftsführer die Geschicke des AMEOS Klinikums Halberstadt und des AMEOS Klinikums Anklam-Ueckermünde Er war Betriebsleiter im Klinikum der Stadt Hanau und als Arzt und im Management im Klinikum Darmstadt tätig Der gebürtige Hesse ist verheiratet und hat zwei Töchter
Das Klinikum Nürnberg ist ein Maximalversorger: Jeder wird erstklassig versorgt Beim 100-jährigen Jubiläum skizzierte der damalige Ärztliche Direktor das daraus resultierende Dilemma: Das Klinikum dürfe und wolle niemanden abweisen, es müsse die hochqualifizierte Behandlung aller sicherstellen Menschlichkeit müsse mit Hightech verbunden werden – bei begrenzten Ressourcen Wie groß ist die Zwickmühle heute?
Das Dilemma hat sich sogar verstärkt, weil es damals durch die Krankenhaus-Budgetierung noch eine finanzielle Grundsicherung
gab, die es im aktuellen marktwirtschaftlichen Finanzierungssystem nicht gibt In der jetzigen Finanzierung spielen der Versorgungs- und Sicherstellungsauftrag, die Versorgungsstufe und die Trägerschaft keine Rolle; auch nicht, ob man gemeinnützig oder gewinnorientiert arbeitet In dieser Systematik hat der breit aufgestellte kommunale Maximalversorger einen deutlichen Nachteil gegenüber Fachkliniken oder spezialisierten Versorgern, die Skaleneffekte durch Spezialisierung und Risikoselektion erzielen können
2003 wurden die Fallpauschalen eingeführt – ein Paradigmenwechsel in der Krankenhausfinanzierung 2020 wurden die Pflegepersonalkosten aus dem DRG-System ausgegliedert, stattdessen wurden klinikindividuelle Pflegebudgets geschaffen Wie wirkt sich das auf das Klinikum Nürnberg aus?
Die Einführung der Fallpauschalen, der DRGs, war nicht per se schlecht In Deutschland wurden die DRGs aber zu einem Einzelfall-Vergütungsinstrument umgewandelt – das heißt, es gibt keine Grundsicherung der
Ein Nachteil ist, dass der Skill-Mix nicht berücksichtigt wird Man muss den Krankenhäusern zugestehen, dass sie Personal mit unterschiedlichen Qualifikationen einsetzen Diese Teamleistung kommt in der Finanzierung zu kurz
Teamleistung – ein gutes Stichwort Der Trend geht seit geraumer Zeit zu medizinischen Zentren Ist die interdisziplinäre Zusammenarbeit die Zukunft?
Vorhaltekosten und keine Budgetabsicherung Das setzt Fehlanreize; nämlich die, in die Fallmenge zu gehen und das Leistungsspektrum zu erweitern, insbesondere bei gewinnorientierten Krankenhäusern Doch Medizin sollte nicht Ware, der Arzt nicht Verkäufer werden
Bei der Pflege wurde gegengesteuert Die Pflege wird nun unabhängig davon finanziert, wie viele Patientinnen und Patienten behandelt werden Das ist ein guter Schritt
Die Zukunft, das ist eine Mischung aus Spezialisierung auf der einen Seite und einer interprofessionellen und interdisziplinären Zusammenarbeit auf der anderen Seite Wir ringen im gemeinsamen Fachaustausch um die beste Lösung für unsere Patient*innen Auch bei unseren großen Zukunftsprojekten steht die intensive Zusammenarbeit verschiedener Fachbereiche im Vordergrund: Der Baubeginn unseres neuen großen Kinderklinikums mit Geburtshilfe steht unmittelbar bevor, dicht gefolgt vom neuen Zentrum für seelische Gesundheit Das sind echte Meilensteine für das Klinikum Nürnberg Außerdem planen wir an unserem Standort Süd ein großes neues Notfallzentrum
Wir müssen alles dafür tun, dass der Hochleistungsbereich in der Pflege wieder so attraktiv wird, wie er es schon einmal war.

Das 125-jährige Jubiläum fällt in eine Pandemie Die Corona-Krise wäre ohne intakte Krankenhaus-Landschaft nicht zu bewältigen Glauben Sie, dass diese Botschaft flächendeckend durchgedrungen ist?
Ich hoffe es Wir haben das in Deutschland sehr gut hinbekommen Die Intensivkapazitäten waren immer mal an der Grenze, die Grenze wurde aber nie überschritten Je größer die Krise wurde, desto reibungsloser hat die Zusammenarbeit zwischen den Krankenhäusern und den unterschiedlichen Trägern funktioniert Was die Pandemie auch offengelegt hat: Wir müssen dringend mehr Intensivpflegekräfte qualifizieren Wir müssen alles dafür tun, dass dieser Hochleistungsbereich in der Pflege wieder so attraktiv wird, wie er es schon einmal war
Dabei ist das Klinikum Nürnberg ja auch Ausbilder, Weiterbildungsträger und Forschungs- und Lehrkrankenhaus
Ja, das Klinikum Nürnberg hat sich schon immer um die Mitarbeiter-Qualifizierung gekümmert, das gehört zur Philosophie des Hauses: Die Pflegeschule, das heutige Centrum für Pflegeberufe, ist über 100 Jahre alt, unser Fort- und Weiterbildungszentrum cekib ist über 50 Auch die Entwicklung neuer Berufsfelder zeichnet das Klinikum aus Zuletzt haben wir mit der TH Nürnberg das Studium der Hebammenwissenschaften und des Digitalen Gesundheitsmanagements auf den Weg gebracht;
nicht zu vergessen das Medizinstudium, das wir an unserer Medical School, unserem Nürnberger Universitätscampus, für 250 Studierende gemeinsam mit der Paracelsus Medizinischen Privatuniversität Salzburg anbieten Das hilft uns, ein stabiles Fundament mit sehr gut qualifiziertem Personal aufzubauen Allerdings wird uns der Austritt der Babyboomer-Generation in den Ruhestand vor Herausforderungen stellen Deshalb werden wir weiter versuchen, auch ausländische Mitarbeiter*innen für uns zu gewinnen
Zum Abschluss eine ganz persönliche Frage: Warum arbeiten Sie gerne im Klinikum Nürnberg?
Es ist eine ausgesprochen herausfordernde und spannende Aufgabe, ein so großes Krankenhaus mit so unterschiedlichen Menschen, Expert*innen und so großem Know-how zu führen und seine Zukunft mit zu gestalten Das Klinikum Nürnberg gehört zu den Spitzenhäusern in der deutschen Krankenhauslandschaft, mit einer besonderen Rolle als zentrales Versorgungskrankenhaus der Metropolregion Nürnberg Was gibt es Schöneres, als für diese Institution arbeiten zu dürfen? Es ist ein großer Anspruch und auch eine Ehre Ich wünsche dem Klinikum und allen Mitarbeiter*innen, dass wir diesen Weg gemeinsam erfolgreich weitergehen
Interview: Sabine Stoll
Seit 125 Jahren ist das ehemals Städtische Krankenhaus der verlässliche Gesundheitsversorger für die Menschen in Nürnberg und der Region
Seit 2020 lenkt ein dreiköpfiger Vorstand das Klinikum:
Prof Dr med Achim Jockwig



Vorstandsvorsitzender Vorstand Medizin und Strategie
Peter Schuh
Vorstand Personal und Patientenversorgung
Dr Andreas Becke
Vorstand Infrastruktur und Finanzen
Das Klinikum als Konzern
Klinikum Nürnberg (100%)
Krankenhäuser Nürnberger Land GmbH (100%)
· Krankenhaus Altdorf
· Krankenhaus Lauf
Klinikum Nürnberg Service GmbH (100%)
ABC Ambulantes BehandlungsCentrum GmbH (100%)
KNMS Klinikum Nürnberg Medical School GmbH (100%)
Schaukel gGmbH Kinderbetreuung (100%)
A R Z Ambulantes Rehabilitationszentrum Nürnberg gGmbH (50%)
SAPV Spezialisierte Ambulante Palliative Versorgung GmbH (35%)
Von der Medizin über die Pflege bis hin zur Rolle als großer Arbeitgeber, Ausbildungsbetrieb, Forschungsund Lehreinrichtung: Das Klinikum Nürnberg ist im Jahr 2022 ein zentraler Eckpfeiler in der Gesundheitsund Krankenversorgung der Stadt Nürnberg und der Metropolregion Vor 125 Jahren begann die reiche Geschichte des Hauses als Krankenhaus im Nürnberger Norden Prosperierende wie auch wechselvolle Jahre und Jahrzehnte folgten Medizinische Expertise und bauliches Wachstum gingen dabei stets Hand in Hand Zum 125 Geburtstag blickt Bernd Windsheimer, Geschäftsführer des Nürnberger Vereins Geschichte Für Alle e V , zurück 1897

Nürnbergs erstes Krankenhaus eröffnete 1845 Bis dahin war in Nürnberg das HeiligGeist-Spital die zentrale Einrichtung für die Versorgung von Armen, Alten und Kranken Nicht die Heilung des Körpers, sondern die der „Seele“ stand im Mittelpunkt
Da eine weitere Vergrößerung nicht möglich war, stand bald außer Frage, dass ein größerer Neubau notwendig würde Die städtischen Kollegien beauftragten Klinikdirektor Gottlieb Merkel und den Architekten Heinrich Wallraff mit einer Besichtigungsreise zu
Das Haus in der Sandstraße mit seinen anfangs knapp 270 Betten in 79 Zimmern war der erste große Neubau außerhalb der Stadtmauern Behandelt wurden hier Dienstboten, Gesellen und Arme, für die dies im Gegensatz zum Bürgertum nicht zuhause möglich war Im Zeitalter der Industrialisierung zwangen das rapide Bevölkerungswachstum und Epidemien wie die Cholera oder die Grippe zur stetigen Ausweitung der Kapazität des alten Krankenhauses Die Bettenzahl stieg durch Anbauten im ehemaligen Klinikgarten auf 380
Rechts: Das neue Krankenhaus an der Flurstraße, 1897 Oben: Das alte Krankenhaus, im Vordergrund Klinikdirektor Gottfried Merkel mit Ärzten und Pflegeschaft

vorbildhaften Krankenanstalten in Deutschland Die Entscheidung fiel für eine Krankenanstalt im Pavillonsystem nach dem Vorbild von Hamburg-Eppendorf

Die neue Krankenstadt im Stadtteil St. Johannis
Als Standort für den Neubau entschied man sich für ein Grundstück am Rande der nordwestlichen Vorstadt St Johannis Hier stand bereits das Genesungshaus, eine kleine Zweigstelle des alten Krankenhauses
Nach nur zweieinhalbjähriger Bauzeit konnte Nürnbergs neue Krankenanstalt am 5 September 1897 feierlich eingeweiht werden Auf einer mehr als zehn Hektar großen Fläche waren, aufgelockert durch Grünanlagen, 30 Gebäude, darunter 18 Krankenbauten mit 760 Betten sowie 100 Betten für das in der Anstalt wohnende Personal, entstanden
Mit der durch diese Bauweise ermöglichten guten Durchlüftung wollte man die Verbreitung von Infektionskrankheiten durch „verseuchte Luft“ verhindern Das von einer 2,5 Meter hohen Mauer umgebene Grundstück bot ausreichend Platz für zukünftig notwendig werdende Erweiterungen
Trotz großzügiger Planung herrschte bereits im Jahr 1900 wieder Platzmangel; durch Aufstockungen und die Einglasung von Liegehallen gewann man Platz für weitere Betten Bis zum Ersten Weltkrieg stieg die Bettenzahl mit der Errichtung weiterer Krankenbauten auf über 1300
Die Spanische Grippe wütete auch in Nürnberg und füllte die Krankensäle Gottfried Merkel (rechts) ist Vater des neuen Städtischen Krankenhauses Unten rechts die neue Frauenklinik 1930
Mit den Bauten 36 und 37 hatte die Stadt erstmals auch vor Ort Behandlungskapazitäten für tuberkulosekranke Männer und Frauen Die „Schwindsucht“, wie die Tbc umgangssprachlich genannt wurde, galt als Volkskrankheit und stand bereits seit den 1890er-Jahren im Brennpunkt der deutschen Gesundheitspolitik Jährlich starben 150 000 Menschen an der Krankheit, darunter viele junge Erwachsene

Zwischenkriegszeit und Reformjahre: Die Weimarer Republik
Trotz der wirtschaftlichen Krisenjahre am Beginn und Ende der Weimarer Republik gelangen der Stadt Nürnberg in den 1920ern wegweisende Neubauten und grundlegende Verbesserungen im medizinischen und pflegerischen Bereich

Seit 1919 übernahm die Stadt das privat betriebene Wöchnerinnenheim Es wurde deutlich erweitert und behelfsmäßig im Krankenbau des neuen Sebastianspitals untergebracht Ebenfalls zur besseren medizinischen Versorgung von Nürnbergs Frauen trug eine 1923 eingerichtete gynäkologische Station mit 75 Betten bei
Das mit Abstand größte Projekt dieser Jahre war jedoch der Neubau der Frauenklinik mit 252 Betten und einem angeschlossenen Säuglings- und Kleinkinderheim mit 116 Betten an der Rieterstraße, die im Dezember 1930 eröffneten
Als der Stadtrat 1925 in der Ägide des Gesundheits- und Wohlfahrtsreferenten Hermann Heimerich den Neubau beschlossen hatte, fanden bereits ein Drittel aller Geburten Nürnbergs im behelfsmäßigen Wöchnerinnenheim im Sebastianspital statt, das aus allen Nähten platzte Mit dem Beschluss verabschiedete sich die Stadt für viele Jahrzehnte von den bereits eingeleiteten Planungen für den Bau eines zweiten Krankenhauses mit über 1 000 Betten

Genesenenhaus, später Wöchnerinnenheim Rieterstraße, 1927 Näherei, 1905


Während des Ersten Weltkriegs wurde im Städtischen Krankenhaus ein großes Reservelazarett für kranke und verwundete Soldaten mit über 500 Betten eingerichtet Im letzten Kriegsjahr 1918 kam als weitere Herausforderung eine weltweit grassierende Pandemie hinzu: die Spanische Grippe Allein in der zweiten Jahreshälfte starben im Klinikum mehr als tausend Erwachsene und über 320 Kinder und Jugendliche an dieser Krankheit
1920er-Jahre
Ende der 1920er-Jahre verzeichnete das Krankenhaus einen absoluten Höchststand an Patienten Schon im Jahr darauf spiegelten sich die Folgen der Weltwirtschaftskrise jedoch in stark gesunkenen Einweisungen deutlich wider Die Belegungszahlen blieben bis weit in die NS-Zeit hinein auf diesem niedrigen Niveau Erst 1942/43 wurde wieder der Stand der späten zwanziger Jahre erreicht

Neubau der Psychiatrie „Bau 21“, 1927 Balkon der Säuglingsklinik, 1930 (rechts)


Die Belegung mit Patient*innen auf niedrigem Niveau und die „ausmerzende“ nationalsozialistische Gesundheitspolitik machten weitere Neubauten in den Jahren 1933 bis 1945 unnötig Nur noch schwere Erkrankungen wurden im Klinikum behandelt, da Einweisungen auf diese Fälle begrenzt oder zu lange hinausgeschoben wurden Bezeichnenderweise waren die einzigen Neubauten dieser Jahre der in den Jahren 1941/43 errichtete Hoch- und Tiefbunker sowie fünf Krankenbaracken für Zwangsarbeiter, die man in der abgelegenen nordwestlichen Ecke versteckt hatte
Bereits Ende März 1933 waren die am Krankenhaus tätigen jüdischen Ärzt*innen entlassen beziehungsweise zum Rücktritt gezwungen worden (siehe hierzu auch den Beitrag zu Prof Ernst Nathan) Im Dezember 1936 wurde der Chefarzt der Zweiten Inneren Medizin, Konrad Bingold, in den zwangsweisen Ruhestand versetzt Er hatte sich geweigert, sich von seiner jüdischen Ehefrau scheiden zu lassen Ab Ende 1937 durften keine jüdischen Patient*innen mehr aufgenommen und behandelt werden
Prof Konrad Bingold, Leiter der 1 Medizinischen Klinik, wurde im Dezember 1936 entlassen, da seine Ehefrau jüdischer Herkunft war

1936
Im Hochbunker wurde nach dem Luftangriff 1944 der Notbetrieb der Frauen- und Säuglingsklinik aufrechterhalten

Literatur und Autor: Bernd Windsheimer
Quelle:100 Jahre Klinikum Nürnberg Die Geschichte des Nürnberger Gesundheitswesens im 19 und 20 Jahrhundert, Nürnberg 1997
Im Bereich der Pflege scheiterte die angestrebte Ersetzung der Neuendettelsauer Schwestern durch ideologisch geschulte NS-Schwestern weitgehend Nur an der Zweiten Medizin und der Frauenklinik wurden die „Braunen“ Schwestern eingesetzt In der Frauen- und Säuglingsklinik waren in diesen Jahren Geburtenrekord und Zwangssterilisationen zwei Seiten einer Medaille Während 1935 so viele Geburten wie nie verzeichnet wurden und das Regime darin einen Erfolg der Geburtenförderungspolitik für „erbgesunde deutsche Familien“ sah, standen
dem die Zwangssterilisationen der vom Regime als „minderwertig und erbkrank“ definierten Menschen gegenüber Zwischen 1934 und 1937 führte Klinikleiter Hans Gänssbauer bei 490 Frauen derartige Eingriffe durch, es starben sieben Frauen
Der Luftangriff vom 1 August 1943 zerstörte große Teile des Krankenhauses 1200 Betten waren nicht mehr nutzbar
1945
Die zerstörte Frauenklinik nach dem verheerenden Luftangriff auf Nürnberg am 2 Januar 1945


Prof. Dr. Ernst Nathan (23. Mai 1889 – 1. November 1981)

„seiner“ Klinik erklärte er sich trotz der Umstände bereit, noch seinen Nachfolger einzuarbeiten
Der renommierte Arzt und Wissenschaftler hatte als junger Arzt in Frankfurt am Institut von Paul Ehrlich sowie der universitären Hautklinik gearbeitet und sich 1922 habilitiert Im September 1923 war er zum Chefarzt der Abteilung für Haut- und Geschlechtskrankheiten ans Städtische Krankenhaus nach Nürnberg berufen worden
Nürnberg ehrt mit der Benennung der Prof -Ernst-Nathan-Straße den ehemaligen Chefarzt seines Städtischen Krankenhauses, der 1933 von den Nationalsozialisten entlassen worden war Die Straßenbezeichnung erinnert aber auch an alle jüdischen Ärztinnen und Ärzte in Nürnberg, die aus rassistischen, antisemitischen Gründen entlassen oder denen später die Approbation entzogen wurde

Prof Dr Ernst Nathan war Ende März 1933 gezwungen worden, seinen „Urlaub“ ohne Ruhegehalt sofort anzutreten, noch vor Inkrafttreten des „Gesetzes zur Wiederherstellung des Berufsbeamtentums“, das dem Unrecht einen legalen Anstrich geben sollte Aus Verbundenheit mit
Ernst Nathan praktizierte nach seiner Zwangsentlassung bis zum Approbationsentzug für alle jüdischen Ärzt*innen durch das Regime 1938 in seiner Wohnung Im März 1939 gelang es ihm mit seiner Familie nach New York zu emigrieren
Prof Dr Ernst Nathan starb 1981 nach jahrzehntelanger ärztlicher Tätigkeit in New York
Saal der Frauenklinik in den 1930er-Jahren

der schlechten Lebensbedingungen und Versorgungssituation Krankheiten grassierten und viele Patient*innen Hilfe im Klinikum suchten Bereits 1947 standen nach der provisorischen Instandsetzung vieler Klinikgebäude mit nahezu 2 000 so viele Betten wie noch nie zur Verfügung Der 1936 zwangspensionierte Konrad Bingold wurde von den Amerikanern 1945 als Unbelasteter zum neuen Klinikdirektor ernannt

Nach Kriegsende im April 1945 schien das Städtische Krankenhaus am Ende zu sein: Die Gebäude waren zu 70 Prozent zerstört und die
Bis Ende der 1950er-Jahre verdoppelte sich die jährliche Patientenzahl, die Zahl der Pflegetage stieg auf 800.000 an.
Belegung auf einen absoluten Tiefststand von 112 Patienten gesunken Die Amerikaner hatten Krankenhausdirektor Erwin Kreuter, der langjähriges SS- und Parteimitglied gewesen war, verhaftet und im Lager Langwasser interniert
Doch der bauliche und personelle Wiederaufbau vollzog sich notgedrungen sehr schnell, da aufgrund
Bis Ende der 1950er-Jahre verdoppelte sich die jährliche Patientenzahl, die Zahl der Pflegetage stieg auf 800 000 an Da die Neuendettelsauer Schwestern den Personalbedarf nicht mehr vollständig abdecken konnten, kamen anfangs Rot-KreuzSchwestern und später immer mehr freie Schwestern hinzu 1957 errichtete man für das Pflegepersonal ein elfstöckiges Schwesternwohnheim mit 286 Einzelzimmern Im gleichen Jahr erfolgte die Grundsteinlegung für den 1961 eingeweihten Y-Bau, den ersten Klinik-Großbau, der mit der alten Pavillonstruktur brach Für ihn mussten die alten Krankenbauten 16, 17 und 18 sowie das alte Kesselhaus mit seinem 56 Meter hohen Schornstein weichen Der Wiederaufbau des Krankenhauses galt nun als abgeschlossen, die kriegszerstörten Krankenbauten waren neu errichtet und die Bettenzahl hatte mit nahezu 2500 einen absoluten Höchststand erreicht
Auf dem Weg zum größten kommunalen Krankenhaus Deutschlands
Die wichtigste Entwicklung der 1960er- und 1970er-Jahre war sicherlich die zunehmende Spezialisierung der Medizin: Die durch das rapide Wachstum entstandenen Großkliniken der Inneren Medizin oder Chirurgie wurden nach und nach in kleinere Einheiten mit speziellen Schwerpunkten aufgeteilt
Die 1960er- und 1970er-Jahre waren geprägt von einem Schwestern- und Ärztemangel, wobei allein in den Siebzigern die Zahl der Mitarbeiterinnen und Mitarbeiter um 40 Prozent zunahm Eine Zäsur stellte der Abzug der letzten 35 Neuendettelsauer Schwestern im Jahr 1964 dar 1970 wurden erstmals alle Krankenpflegeschulen zentral in der ehemaligen Pflege- und Krippenanstalt der Neuendettelsauer Schwestern in der Heimerichstraße untergebracht
In vielen Bereichen war das Klinikum Nürnberg, wie es seit 1978 offiziell hieß, deutschlandweit Vorreiter: 1976 erhielt Nürnberg ein in seiner Größe und Leistungsfähigkeit einmaliges Radiologisches Institut, 1977 wurde eine 5 (Innere) Medizin mit onkologischem Schwerpunkt eingerichtet, 1978 folgte die erste psychosomatische Klinik und 1979 wurde die Neurologie selbstständig Aber auch bei der Ernennung von Patientenvertretern im Jahr 1977 war Nürnberg bundesweit führend Das Klinikum Nürnberg mit seinen inzwischen über 2700 Betten galt nun als größtes kommunales Krankenhaus Deutschlands

Die Geschichte des Klinikums Nürnberg ist reich an Wandlungen und Umbrüchen Gute und schlechte Zeiten, kleine und große Katastrophen haben dank Menschen, die mit Weitsicht, unternehmerischen Ideen und großem medizinischem und pflegerischem Know-how die Zeichen der Zeit erkannt und genutzt haben, das Krankenhaus zu dem gemacht, was es heute ist
Dabei waren die vergangenen gut 25 Jahre nicht weniger bewegt, als die 100 Jahre zuvor, die unser Geschichtsrückblick bilanziert
Im folgenden Kapitel heben wir prägende Meilensteine der jüngeren Geschichte hervor, die das Klinikum entscheidend vorangebracht haben, besondere Ereignisse und Entscheidungen und ihre Auswirkungen auf das Haus und die Gesundheitsversorgung der Metropolregion Im Fokus stehen die Ideen, Gedanken und Macher*innen dahinter

Bereits 1979 hatte Nürnberg den bis in die 1920er-Jahre zurückgehenden Plan eines zweiten städtischen Krankenhauses wieder aufgegriffen und die Grundsatzentscheidung für den Bau eines Südkrankenhauses mit tausend Betten in der höchsten Versorgungsstufe getroffen Bis zur Eröffnung sollten allerdings noch fünfzehn Jahre ins Land gehen: Am 1 April 1994 eröffnet das Südklinikum in Langwasser mit über 1000 Betten und zehn Operationssälen

nach achtjähriger Bauzeit – das bis dahin kostspieligste Gebäude in der Stadtgeschichte Der von Wald umgebene, große und gut gegliederte, Baukörper war von den Architekten als kleine Stadt mit einem zentralen Platz sowie Wegen mit Läden, Cafes und anderen Einrichtungen, konzipiert worden, in der sich täglich etwa 4000 Menschen aufhalten – Patient*innen, Personal und Besucher*innen 14 Kliniken mit 23 Stationen fanden ihre neue Heimat im Klinikum Süd, darunter zum Beispiel eine neu eingerichtet Herzchirurgie Das hohe Niveau in der Ausstattung der Krankenzimmer, in denen jeder Patient über eine eigene Nasszelle verfügt, setzen bis heute Maßstäbe
Seit der Eröffnung kamen auch im Süden neue Einrichtungen hinzu Erwähnt seien hier nur das 2004 eröffnete neue Zentrum für ambulante Rehabilitation 2016 gingen, ebenfalls in einem Neubau, zwei psychiatrische Tageskliniken für Kinder und Erwachsene in Betrieb









Zwei Männer, zwei Persönlichkeiten, ein gemeinsames Ziel
Zwei Männer haben das Klinikum Nürnberg in der jüngeren Vergangenheit ganz entscheidend geprägt: Dr Alfred Estelmann und Klaus Wambach Beide leiteten das Klinikum Nürnberg exakt zehn Jahre lang: Klaus Wambach von 1997 bis 2007, Dr Alfred Estelmann von 2007 bis 2017


Beide Vorstände gelten als überzeugte „Kommunale“, die den Auftrag zur Daseinsvorsorge sehr ernst nahmen und sich der Rückendeckung und des Vertrauens der Stadt Nürnberg sicher sein konnten Sie arbeiteten unermüdlich dafür, zwischen Menschlichkeit in der Medizin auf der einen und Effizienz auf der anderen Seite die richtige Balance zu finden Beide brachten unter finanziell schwierigen Rahmenbedingungen entscheidende Strukturveränderungen und Innovationen voran, von denen das Klinikum Nürnberg bis heute profitiert
Klaus Wambach wandelte im Auftrag des Stadtrats das damals Städtische Krankenhaus 1998 in ein selbstständiges Kommunalunternehmen um Mit dieser Transformation ist es dem Klinikum Nürnberg gelungen, die Weichen für ein zukunftsorientiertes Krankenhaus- und Klinikmanagement zu legen Es war das erste Krankenhaus in Bayern, das in ein Kommunalunternehmen umgewandelt wurde Gemeinsam mit den Beschäftigten hat Wambach für diese Rechtsform gekämpft, weil sie ein klares Bekenntnis der Stadt zu ihrem Klinikum bedeutet, da es bei dieser keine verkäuflichen Anteile gibt
Wambach gilt zudem als Architekt der kooperativen Klinikleitung Er installierte ein Führungskonzept, bei dem Ärztliche Leitung und Pflegedienstleitung Seite an Seite zusammenarbeiten Weitere Meilensteine waren das Bekenntnis zur Geschichte des Klinikums mit der Umbenennung der Prof Ernst-Nathan-Str , der Ausbau der beruflichen Aus- und Weiterbildung, die Eröffnung der Palliativstation und des Zentrums für ambulante Rehabilitation (A R Z ), der Neubau des Chirurgischen Zentrums und der
Kauf der Krankenhäuser des Landkreises Nürnberger Land Nach seinem Ausscheiden gründete er die Stiftung Klinikum Nürnberg
Dr. Alfred Estelmann kannte das Klinikum Nürnberg bereits aus dem Effeff, als er 2007 zum Vorstand aufrückte Der Mediziner und Ökonom hatte nach seiner Tätigkeit als Assistenzarzt der Kinderklinik und mehreren Jahren in der Datenverarbeitung unter Vorstand Klaus Wambach das Ressort „Medizinische Dienste“ geleitet und war dann zum Vertreter des Vorstands bestimmt worden Er war Geschäftsführer der Krankenhäuser Nürnberger Land, als diese 2006 vom Klinikum Nürnberg – begleitet von großem medialen Interesse – übernommen wurden „Seine Lehrjahre“, wie der für seine Akribie und Bodenhaftung bekannte Chef des Klinikums später gern sagte
Meilenstein mit Dr Estelmann als Vorstand waren unter anderem die Gründung der Paracelsus Medizinischen Privatuniversität (PMU) In seine Ära fallen auch der Abschluss der grundlegenden Erneuerung des Standorts Nord, die Bündelung des medizinischen Angebots in medizinischen Zentren wie dem 2011 eröffneten Herz-Gefäß-Zentrum am Standort Süd Für ihn waren eine gut begründete Medizin und die solide Versorgung der Menschen Voraussetzung für wirtschaftlichen Erfolg Deshalb war es ihm besonders wichtig, quasi als Vermächtnis in den Grundstein des neuen Eingangsgebäudes zum Standort Nord, des Dr Theo-Schöller-Hauses, den Nürnberger Kodex zu legen Und nicht zuletzt setzte er sich dafür ein, die Attraktivität des Klinikums Nürnberg als familienfreundlicher Arbeitgeber zu steigern
Sabine StollDr Alfred Estelmann und Klaus Wambach genossen bei den Beschäftigten des Klinikums Nürnberg großes Ansehen Kommunikation auf Augenhöhe zeichnete sie aus Sie
konnten bei ihren Entscheidungen auf die verlässliche und engagierte Unterstützung der Klinikumsleitung bauen Das Klinikum Nürnberg ist ihnen zu großem Dank verpflichtet
Das Klinikum wird Kommunalunternehmen
Im Mai 1997 traf der Nürnberger Stadtrat nach längeren, kontroversen Debatten mit großer Mehrheit eine wegweisende Entscheidung Das städtische Krankenhaus, bis dahin als Eigenbetrieb geführt, wird ab 1999 in ein selbstständiges
Ein Kommunalunternehmen kann auf dem Markt freier auftreten als ein Eigenbetrieb.
Kommunalunternehmen umgewandelt - als erstes großes Krankenhaus in Bayern Das große Ziel des „Abnabelungsprozesses“: in Eigenverantwortung auf kürzeren Wegen wirtschaftlich handeln und für die Patient*innen trotz der immer knapper werdenden Mittel im Gesundheitswesen eine Versorgung auf höchstem Niveau zu gewährleisten
Dr Günther Beckstein erinnert sich noch gut „Als ich bayerischer Innen-

minister geworden war, wurde gerade viel privatisiert In zahlreichen Gesprächen, die ich damals geführt habe, hatten sich insbesondere Gewerkschaftsvertreter heftig gegen einen solchen Schritt gewehrt, weil befürchtet wurde, dass dann nicht mehr das öffentlich-rechtliche Tarifrecht gegolten hätte“, erzählt Beckstein Andere Tarife wären zum Beispiel in einer GmbH bezahlt worden, die rein privatrechtlich orientiert und zudem auf eine Gewinnerzielung ausgerichtet ist
Ein Eigenbetrieb - wie es das Nürnberger städtische Krankenhaus war - kann aber Gemeinden teuer zu stehen kommen, denn als Träger müssen sie zahlen, wenn das eigene Unternehmen in finanzielle Schieflage gerät, und zwar ohne jede Haftungsbegrenzung Ein Grund für Kommunen, über andere Rechtsformen nachzudenken, die die Freiheiten der privaten Wirtschaft ermöglichen, aber der Haftung Grenzen setzen
Beckstein wollte eine Lösung: „Ich habe meinen Mitarbeitern gesagt, wir bräuchten etwas, das in der Mitte liegt Eine Rechtspersönlichkeit, die immer noch öffentlich-rechtlich ist, die damit dem Tarifrecht unterliegt und auch die Ansprüche erfüllt, also zum Beispiel dem Wohle der Gesundheit dient und nicht in erster Linie auf Gewinn aus ist “
Mit dieser Idee hat der gelernte Jurist das Kommunalunternehmen „erfunden“ Seine Mitarbeiter arbeiteten dazu ein Gesetz aus, das im Juli 1995 in Kraft trat und später mit einer Verordnung ergänzt wurde „Wir in Bayern waren die ersten, die so etwas gemacht haben Nach und nach griffen weitere Bundesländer die Idee auf Ein Kommunalunternehmen kann auf dem Markt freier auftreten als ein Eigenbetrieb “
Wirtschaft standen manche dem Kommunalunternehmen kritisch gegenüber – sie hätten eine richtige Privatisierung bevorzugt“, sagt Beckstein Schreibt ein Kommunalunternehmen rote Zahlen, muss die Kommune den Verlust nicht zwingend ausgleichen „Es ist aber zweckmäßig, weil ein stark überschuldetes Unternehmen nicht mehr handlungsfähig ist“, so Beckstein
Nachdem sich der Nürnberger Stadtrat für diese neue Rechtsform entschieden hatte, setzte Klaus Wambach als Gründungsvorstand die Umwandlung um Die große Mehrheit der Beschäftigten stand hinter dem Modell, auch weil die Tarife oder die Altersversorgung durch die Zusatzkasse des öffentlichen Dienstes erhalten blieben Alle Mitarbeiter*innen wurden unter den gleichen Bedingungen in das neue Unternehmen übernommen
Das Modell wurde auch vom Städte- und Gemeindetag sehr begrüßt „Das war hilfreich, denn aus der 1998
Karin WinklerZwei moderne Krankenhausstandorte im Nürnberger Land und ein Haus der Maximalversorgung als starker Partner an der Seite: Seit 2006 gehören die Krankenhäuser Nürnberger Land zum Klinikum Nürnberg Für die 170 000 Bürgerinnen und Bürger im Landkreis Nürnberger Land wurde durch die deutschlandweit einmalige Fusion die wohnortnahe medizinische Versorgung auf höchstem medizinischem und pflegerischen Niveau gesichert
Der Verkauf der Krankenhäuser Nürnberger Land durch den Landkreis an das Klinikum Nürnberg war 2006 eine kleine Sensation: Noch nie zuvor hatte ein kommunales Krankenhaus ein anderes Krankenhaus übernommen Der Landkreis wollte mit dem Verkauf die Weichen für die langfristige Sicherung der medizinischen Gesundheitsversorgung Nach längeren Verhandlungen stimmte das Kartellamt der Fusion schließlich zu
Seitdem das Klinikum Nürnberg als Muttergesellschaft für die Krankenhäuser Nürnberger Land verantwortlich zeichnet, sind über 15 Jahre vergangenen Seither hat sich vieles getan: Viele medizinische Dienstleister und die Verwaltung der Krankenhäuser in Lauf und Altdorf sind mittlerweile ans Klinikum angebunden Aber auch medizinische Fachbereiche folgen der Strategie der Integration in den Unternehmensverbund

So wurde die Anästhesie der Krankenhäuser Nürnberger Land 2018 in die Anästhesie des Klinikums vollständig integriert Die Allgemein- und Viszeralchirurgie sind mit der Allgemein-, Viszeral- und Thoraxchirurgie des Klinikums 2020 zu einem Zentrum zusammengeführt worden Auch zukünftig wird die Strategie des „Zusammenwachsens“ fortgeführt, da sie für die Versorgung der Bürger*innen im Nürnberger Land viele Vorteile bietet Mit den weiteren Fachabteilungen Innere Medizin, Unfallchirurgie und orthopädische Chirurgie, Gynäkologie und Geburtshilfe, Anästhesie und Intensivmedizin, Urologie und Physikalische Therapie steht ihnen eine breite wohnortnahe medizinische Versorgung offen
700 Mitarbeiterinnen und Mitarbeiter an den Standorten Altdorf und Lauf versorgen heute über 30 000 stationäre und ambu-
Die Krankenhäuser Nürnberger Land blicken auf eine lange Tradition zurück Das Krankenhaus Altdorf wurde als Distriktkrankenhaus 1894 gegründet und mehrmals erweitert und saniert Das Krankenhaus Lauf wurde als moderner Neubau im Jahre 1962 auf der grünen Wiese am Fuße des Laufer Kunigundenbergs errichtet Ursprünglich gab es im Landkreis noch das Krankenhaus Schnaittach, das seit 2003 nicht mehr in Betrieb ist, und das Krankenhaus Hersbruck, das 2019 geschlossen wurde 2011 wurde das Ärztehaus „Ärzte Campus“ eröffnet
lante Patient*innen im Jahr Seit 2019 sind die Krankenhäuser Nürnberger Land zudem Lehrkrankenhäuser der Paracelsus Medizinischen Privatuniversität Zum Unternehmen gehört außerdem eine Krankenhausdienstleistungsgesellschaft, die für den Reinigungsdienst verantwortlich ist
Seit 2006 investiert das Klinikum Nürnberg kontinuierlich in die Infrastruktur der Krankenhäuser in Lauf und Altdorf Nach einem neuen Bettenhaus wird das Krankenhaus Lauf in einem weiteren Bauabschnitt um 48 Betten erweitert, die aus Hersbruck nach Lauf verlagert werden Zwei OP-Säle werden neu errichtet, sodass zukünftig in Lauf fünf OP-Säle zur Verfügung stehen Die Notaufnahme wird neu gebaut Außerdem wird der Altbau generalsaniert Er wird zukünftig eine Funktionseinheit der Inneren Medizin und Dienstzimmer für Pflege und Ärzte enthalten


Freude und Stolz herrschte im November 2014 bei der Inaugurationsfeier von Paracelsus Medizinischer Privatuniversität und Klinikum Nürnberg im historischen Rathaussaal der Stadt Nürnberg Man kennt sich, man mag sich, man vertraut einander, die Salzburger und Nürnberger Verantwortlichen, die ein mutiges Projekt auf den Weg gebracht hatten: einen neuen Standort in Nürnberg, an dem im August 2014 die ersten 50 Studierenden das Studium der Humanmedizin begonnen haben
Das Klinikum Nürnberg und die Paracelsus Universität haben in Kooperation mit der Technischen Hochschule Nürnberg in mehrjähriger Vorbereitung die Strukturen und Voraussetzungen geschaffen, junge angehende Ärztinnen und Ärzte auf hohem Niveau auf das Berufsleben vorzubereiten

Strategisch wichtig und richtig
Von Anfang an sei ihm bewusst gewesen, dass ein Vorhaben wie die Etablierung eines Nürnberger Studiengangs Humanmedizin zum Politikum werden und nicht nur Freunde finden würde, räumte Oberbürgermeister Dr Ulrich Maly in seiner Festrede ein Überzeugt hätten ihn – sowie den Verwaltungsrat des Klinikums und den Stadtrat –letztlich die Besonderheiten des Studiums, die Chancen für die Nachwuchsförderung am Klinikum Nürnberg und die dort herrschenden günstigen Rahmenbedingungen Zudem sei die Paracelsus Uni seit 2003 in Österreich fest etabliert und erfolgreich tätig „Die Kooperation ist strategisch wichtig und richtig!“ Damit werde nicht nur die medizinische Qualität des Klinikums auf höchstem Niveau gesichert, sondern auch der Hochschulstandort Nürnberg beflügelt, bekräftigte Maly
Stärkung und Weiterentwicklung der Krankenversorgung
Dr Stephan Kolb, Leiter des Bereichs Bildung und Wissenschaft und Geschäftsführer der Klinikum Nürnberg Medical School GmbH


Mit diesem Schritt haben wir das Klinikum Nürnberg mit kommunalem Spirit konsequent zu einem universitären Klinikum weiterentwickelt.
„Das Klinikum Nürnberg ist ein großes, anerkanntes Klinikum mit allen notwendigen Spezialitäten, einer hohen Anzahl von habilitierten Chefärzten und einer beachtlichen Wissenschaftsleistung “ Für den Salzburger Universitätsrektor Prof Dr Herbert Resch waren die Entschlossenheit der gesamten Klinikumsleitung – einschließlich der Chefärzte – ausschlaggebend, die vielversprechende Kooperation umzusetzen „Wir wünschen uns eine gegenseitige Stärkung in Lehre, Forschung und Patientenversorgung, die der Bevölkerung zugutekommt “ In diesem Sinne zeigte sich auch das damals für die Medizin zuständige Mitglied der Klinikumsleitung, Prof Dr Dr Günter Niklewski, überzeugt, dass die Anwesenheit der Studierenden sich positiv auf die Kultur des Klinikums auswirken werde, „nicht nur weil sie uns in die Pflicht nehmen, viel intensiver über das tägliche Tun nachzudenken“
Mit dem Universitätsstandort setzte das kommunale Klinikum Nürnberg erneut einen weithin beachteten –auch unternehmerisch innovativen – Akzent Schon 2006 hatte das Klinikum mit dem Kauf der Krankenhäuser Nürnberger Land bundesweit für Aufmerksamkeit gesorgt „Es sind auch jetzt wieder die langfristigen strategischen Ziele, die zu solchen auf den ersten Blick ungewöhnlichen Vorhaben führen“, bestätigt der damalige Klinikumsvorstand Dr Alfred Estelmann
Mit der PMU erweiterte sich auch der formelle Status der Kliniken und Institute des Klinikums – sie wurden im Rahmen ihrer Aufgaben in Forschung und Lehre auch zu universitären akademischen Institutionen
So wurden im Rahmen der Inaugurationsfeier 2014 zunächst 23 Chefärzte zu Universitätsprofessoren der Paracelsus Universität berufen
Die Gründung der Nürnberger PMU sollte eine Erfolgsgeschichte werden Der Abschluss des ersten Jahrgangs war der erste Beleg dafür: Von 50 Studierenden des Pionierjahrgangs 2014 absolvierten im Jahr 2019 insgesamt 38 das Studium in der Regelstudienzeit von fünf Jahren, nur drei schieden gänzlich aus, neun verlängerten Jeder zweite Absolvent startete im Klinikum Nürnberg Die „Bayern-Quote“ lag bei 65 Prozent, d h 25 der Alumni begannen in einer Klinik in Bayern

Die Kooperation ist auch inhaltlich ein Erfolg Viele der im Jahr 2014 vom Wissenschaftsrat (WR) geforderten Weiterentwicklungen des Medizinstudiums werden in der Nürnberger Ärzteausbildung bereits praktiziert In diesem Sinne wurde Vertretern aus
Nürnberg 2015 in einer persönlichen Anhörung beim WR bestätigt, dass der Nürnberger Standort auch die Weiterentwicklung des staatlichen Medizinstudiums innovativ bereichere Die Stellungnahme des WR zur nicht-staatlichen Medizinerausbildung in Deutschland aus dem Jahr 2016 bestätigt dies

In seiner Studie „Durch Kooperation zum Standortprofil“ zu erfolgreichen Hochschulkooperationen in Deutschland hebt der Stifterverband für die Deutsche Wissenschaft 2017 die Nürnberger Ärzteausbildung als Kooperation von Klinikum Nürnberg, TH Nürnberg und Paracelsus Universität als eines von 12 bundesweiten Vorzeige-Projekten hervor
 Dr Stephan Kolb
Dr Stephan Kolb
Lebendiges Studentenleben am Campus Nürnberg der Paracelsus Medizinischen Privatuniversität
Der erste Abschlussjahrgang von Studierenden freut sich 2019 über das erfolgreich bestandene Examen der Humanmedizin
Der 125-jährige Geburtstag des Klinikums Nürnberg fällt in eine Pandemie – ausgerechnet Die CoronaKrise hat aufs Drastischste gezeigt, wie elementar eine intakte Krankenhaus-Landschaft ist Im Klinikum Nürnberg und in den Krankenhäusern Nürnberger Land wurden seit Beginn der Pandemie rund 5300 Patientinnen und Patienten mit COVID-19 aufgenommen (Stand: März 2022), davon Hunderte auf den Intensivstationen Das Klinikum Nürnberg gehört damit deutschlandweit zu den Häusern, die die meisten Patientinnen und Patienten mit COVID-19 behandelt haben Seinem Auftrag als Maximalversorger ist das kommunale Krankenhaus in hohem Maße nachgekommen
5300 Patientinnen und Patienten – hinter dieser Zahl stehen 5300 Einzelschicksale; Schicksale ganzer Familien, die wegen der Ansteckungsgefahr aus der Distanz mit
den Erkrankten gelitten, um sie gebangt oder geweint haben, wenn selbst die modernste Intensivmedizin nicht mehr gegen das Virus angekommen ist Die Pandemie brachte ungeheure Zumutungen für Patientinnen und Patienten sowie deren Angehörige mit sich Sie hat gerade auch das medizinische Personal auf eine extreme Belastungsprobe gestellt

Am 2 März 2020 kam der erste Patient mit COVID-19 ins Klinikum Nürnberg Der Krisenstab konstituierte sich, in Hochphasen trat er drei Mal pro Woche zusammen Nach einem Stufenkonzept wurden Corona-Stationen und Intensivplätze geschaffen: ein steter Spagat zwischen personellen und medizinischen Ressourcen auf der einen und der wachsenden Zahl schwerkranker COVID-Patient*innen auf der anderen Seite Zwei Mal musste der Pandemie-Alarmfall ausgerufen werden, um deutlich zu machen, dass selbst eines der größten kommunalen Krankenhäuser Deutschlands an seiner Belastungsgrenze angekommen ist Um die Behandlung der Vielzahl von Corona-Patienten und

Oberarzt Prof Dr med Stefan John, Leiter der Abteilung interdisziplinäre Intensivmedizin

Wir müssen jeden Tag erneut überlegen, wie viele Betten noch zur Verfügung stehen und wie viele Mitarbeiter wir haben. Das ist ein täglicher Kampf und bringt das gesamte Team an die Belastungsgrenze.
-Patientinnen sicherstellen zu können, galt bayernweit zeitweise die Anordnung, nicht dringliche, verschiebbare Eingriffe und stationäre Aufenthalte auf einen späteren Zeitpunkt zu terminieren Auch am Klinikum Nürnberg mussten OP-Säle geschlossen werden, das frei werdende Klinik-Personal konnte so auf den Corona-Stationen eingesetzt werden
Die sich in Wellen aufbauende Pandemie entwickelte sich zu einer großen Belastungsprobe für die Beschäftigten des Klinikums Nürnberg und der Krankenhäuser Nürnberger Land
Will man der Corona-Krise etwas Positives abgewinnen, dann die Erkenntnis, dass Strukturen und Prozesse funktionieren „Unsere Häuser haben diese nie dagewesene Herausforderung sehr gut bestanden Die Kliniken haben sich untereinander eng abgestimmt Der direkte Draht, den wir von der Patientenversorgung bis zum Vorstand pflegen, kam uns sehr zugute“, resümiert Prof Dr med Achim Jockwig, Vorstandsvorsitzender des Klinikums Nürnberg
Er zieht eine positive Bilanz: „Unsere Mitarbeiterinnen und Mitarbeiter haben auch in schwierigen Situationen einen kühlen Kopf bewahrt Sie haben interdisziplinär, zwischen allen Standorten und Berufsgruppen erfolgreich zusammengearbeitet Sie sind über ihre Grenzen hinausgegangen und haben all ihre Kompetenz und Professionalität in die Waagschale geworfen Das ist eine großartige Leistung “
Jede Welle hatte bislang ihren eigenen Charakter War anfangs die Sorge groß, dass Schutzmaterial und Beatmungsplätze knapp werden könnten, war später das Personal der limitierende Faktor Waren in den
mit dem Corona-Virus zu infizieren, brachte die Möglichkeit, sich impfen zu lassen, eine Riesenerleichterung Für Beschäftigte, die trotzdem erkrankten und länger an den Folgen der Infektion litten, wurde eine PostCOVID-Sprechstunde etabliert Mitarbeiterinnen und Mitarbeiter, die psychisch an ihre Grenzen kamen, konnten sich beim psychosozialen Kriseninterventionsteam des Klinikums Nürnberg Hilfe suchen
ersten Wellen die Intensivstationen regelmäßig am Limit, verlagerte sich das Geschehen mit der Omikron-Variante auf die Normalstationen
Waren es am Anfang vor allem hochbetagte und ältere Patientinnen und Patienten, die Hilfe brauchten, kamen zu einem späteren Zeitpunkt auch jüngere Schwerkranke ins Klinikum Waren die Mitarbeiterinnen und Mitarbeiter zunächst in großer Sorge, sich selbst und ihre Familien

Das Klinikum Nürnberg hat mit seinen Tochtergesellschaften und den Krankenhäusern Nürnberger Land eine große Anpassungsleistung vollbracht Die Beschäftigten haben enorme Flexibilität bewiesen: Pflege, Ärztinnen und Ärzte, Therapeutinnen und Therapeuten, Mitarbeiterinnen und Mitarbeiter in den Laboren, der Hygiene, Servicekräfte genauso wie die Verwaltung, um nur beispielhaft einige zu nennen Auch die Bildungseinrichtungen passten sich an und stellten auf digitales Lehren und Lernen um „Nur im Team konnten wir die Pandemie so gut bewältigen“, so der Vorstandsvorsitzende Prof Jockwig „Und nur im Team können wir schaffen, was möglicherweise noch auf uns zukommt “
Sabine Stoll
Dieses Virus bleibt auf dieser Welt. Es wird nicht wieder gehen.

Prof Dr med Joachim Ficker, Chefarzt Klinik für Innere Medizin 3



Diese Pandemie ist die größte medizinische Katastrophe unserer Generation.
Oberarzt Dr med Matthias Baumgärtel, Intensivstation
Kein Tag, an dem wir abends nicht völlig platt ins Bett fallen.
Katrin Emmrich, Teamleitung Intensivpflege
125 Jahre Klinikum
Eine gute Krankenversorgung und beste Medizin für alle Menschen in Nürnberg - das war die Idee, mit der vor 125 Jahren Gottfried Merkel ein Krankenhaus im Norden der Stadt errichten ließ
Heute ist das Klinikum Nürnberg ein Krankenhaus der Maximalversorgung, das den Menschen in Nürnberg und der Metropolregion eine Behandlung der unterschiedlichsten Krankheitsbilder auf höchstem medizinischem Niveau ermöglicht
Mehr als 1000 top ausgebildete Ärztinnen und Ärzte und 2500 Pflegekräfte kümmern sich um die gesundheitlichen Anliegen der Bevölkerung – vom Säugling bis zum Hochbetagten Das Klinikum Nürnberg behandelt jeden Patienten, rund um die Uhr, an 365 Tagen im Jahr


Unsere 42 Kliniken, Institute und Abteilungen decken die komplette Bandbreite der modernen Medizin ab: Von der Augenheilkunde über die Gastroenterologie bis zur Urologie sind alle medizinischen Fachgebiete vertreten
Auch im Bereich der Kindermedizin und der Psychiatrie sind wir stark Die in unseren Kliniken angewandten Diagnostik- und Therapieverfahren sind beste Standards in der Krankenversorgung
Prof. Dr. med. Hermann Bail Klinik für Orthopädie und Unfallchirurgie


Dr. med. Karl Bodenschatz Klinik für Kinderchirurgie und Kinderurologie
Prof. Dr. med. Cosima Brucker Klinik für Frauenheilkunde und Geburtshilfe

Prof. Dr. med. Alexander Dechêne Klinik für Innere Medizin 6, Gastroenterologie
Prof. Dr. Dr. med. Alexander Eckert Klinik für Mund-, Kiefer- und Gesichtschirurgie

Prof. Dr. med. Frank Erbguth Klinik für Neurologie (bis März 2022)



Prof. Dr. med. Joachim Ficker Klinik für Innere Medizin 3, Pneumologie
Prof. Dr. med. Theodor Fischlein Klinik für Herzchirurgie

Prof. Dr. med. Christoph Fusch


Klinik für Neugeborene, Kinder und Jugendliche
Prof. Dr. med. Markus Gosch Klinik für Innere Medizin 2, Geriatrie


Dr. med. Gerhard Groß
Unfallchirurgie und Orthopädische Chirurgie Krankenhaus Lauf
Prof. Dr. med. Thomas Hillemacher
Klinik für Psychiatrie und Psychotherapie
Dr. med. Valentin Klant Gynäkologie und Geburtshilfe Krankenhaus Lauf
Prof. Dr. med. Stefan Knop Klinik für Innere Medizin 5, Onkologie/Hämatologie
Prof. Dr. med. Jens Kubitz Klinik für Anästhesieologie und Intensivmedizin
Prof. Dr. med. Jan Liman Klinik für Neurologie (ab April 2022)


Dr. med. Ulrich Linnemann Klinik für Allgemein-, Viszeral- und Thoraxchirurgie
Dr. med. Patrick Nonell

Klinik für Psychiatrie, Psychosomatik und Psychotherapie Kinder und Jugend
Prof. Dr. med. Sascha Pahernik Klinik für Urologie




Prof. Dr. med. Matthias Pauschinger Klinik für Innere Medizin 8, Schwerpunkt Kardiologie

Prof. Dr. med. Bert Reichert

Klinik für Plastische, Wiederherstellende und Handchirurgie
Dr. med. Susanne Rudisch Allgemein- und Viszeralchirurgie Krankenhaus Lauf
Prof. Dr. med. Josef Schmidbauer
Klinik für Augenheilkunde
Prof. Dr. med. Erwin Schultz


Klinik für Dermatologie
Prof. Dr. med. HansHerbert Steiner Klinik für Neurochirurgie




Prof. Dr. med. Maximilian Traxdorf Klinik für Hals-Nasen-Ohrenheilkunde
Prof. Dr. med. Roland Veelken Klinik für Innere Medizin 4, Nephrologie


Prof. Dr. med. Eric Verhoeven Klinik für Gefäßchirurgie
Dr. med. Adrian Vizireanu Chefarzt Innere Medizin Krankenhaus Altdorf
Prof. Dr. med. Christiane Waller


Klinik für Psychosomatische Medizin und Psychotherapie
PD Dr. med. Dane Wildner Innere Medizin Krankenhaus Lauf
In Zusammenarbeit mit unseren Instituten und der Paracelsus Medizinischen Privatuniversität gibt das Klinikum Nürnberg auch im Bereich Forschung und Lehre regelmäßig
Impulse Wir sind Partner vieler renomierter Gesundheitseinrichtungen und eigenständiger Labore in der Metropolregion Nürnberg
Dr. rer. biol. hum. Josefin Ammon Institut für Medizinische Physik
Prof. Dr. med. Thomas Bertsch Institut für Laboratoriumsmedizin und Transfusionsmedizin

Prof. Dr. med. Michael Lell Institut für Radiologie, Neuroradiologie und Nuklearmedizin


Prof. Dr. med. Thomas Papadopoulos Institut für Pathologie

Dr. rer. physiol. Annette Sattler Apotheke des Klinikums Nürnberg

Prof. Dr. med. Jörg Steinmann Institut für Klinikhygiene, Mikrobiologie und Infektiologie


In vielen Entscheidungen der vergangenen 125 Jahre war das Klinikum Nürnberg Vorreiter Oftmals haben die Entscheider vorausschauend erkannt, welche gesellschaftlichen Entwicklungen neue Formen der medizinischen Behandlung notwendig machen In anderen wichtigen Themen wie der Digitalisierung der Medizin wollen und werden wir uns in den nächsten Jahren noch erheblich weiterentwickeln Es bleibt spannend, auch in Zukunft

In den 1950er-Jahren verbesserten sich die Lebensbedingungen der Menschen. Krankheiten wie TBC traten in den Hintergrund, neue entstanden. Das Klinikum reagierte mit einer Spezialisierung des medizinischen Angebots.

Antibiotic Stewardship, kurz ABS: Dieser Fachbegriff beschreibt ein Konzept, um Antibiotika bei der Bekämpfung von Infektionskrankheiten verantwortungsvoll und zielgerichtet einzusetzen Einerseits profitieren davon die Patient*innen, andererseits führt der optimierte Einsatz zu weniger Resistenzen Am Klinikum Nürnberg kümmert sich ein multidisziplinäres Team aus Mikrobiolog*innen, ABS-Expert*innen/Infektiolog*innen und Apotheker*innen um die Umsetzung dieses Programmes seit 2011 - insbesondere für Patienten auf den Intensivstationen
Dabei hat die Behandlung schwerer Infektionskrankheiten im Klinikum schon eine lange Tradition „In den Archiven der Rockefeller Universität von New York, in Sleepy Hollow, befindet sich der Nachlass des berühmten deutschen Nobelpreisträgers Paul Ehrlich Im Logbuch sei-
nes Instituts habe ich die Eintragung gefunden, dass im Juli 1910 ein großes Paket des erst drei Monate vorher der Medizinwelt vorgestellten Syphilismittels Salvarsan nach Nürnberg ging“, erzählt der renommierte Pharmakologe Prof Dr Fritz Sörgel, Leiter des Instituts für Biomedizinische und Pharmazeutische Forschung in Heroldsberg
Ziemlich genau 100 Jahre später, im Jahr 2011, begann in Nürnberg die Überprüfung, welche Mengen von Antibiotika beim Patienten überhaupt dort ankommen, wo man sie im Körper des Patienten haben will „Erst in den letzten beiden Jahrzehnten wurden Messmethoden verfügbar, mit denen man die etwa 80 wichtigsten Antibiotika, Pilzmittel und antiviralen Medikamente messen kann, die bei der Behandlung schwerer Infektionen wie Sepsis, Lungenentzündung oder einer schweren Harnwegsinfektion eingesetzt werden“, erklärt Sörgel

Infektionserkrankungen sind weltweit für 1/4 aller Todesfälle verantwortlich Sie werden durch Bakterien, Viren, Pilze und Parasiten hervorgerufen und haben durch veränderte Eigenschaften der Infektionserreger und Resistenzen wieder eine besondere Bedeutung erlangt
In der Praxis funktioniert das so: Ärztinnen und Ärzte auf den Intensivstationen besprechen, bei welchen Patient*innen die Antibiotika-Gaben genauer untersucht werden sollen Den Betroffenen wird Blut abgenommen, das anschließend im Heroldsberger Institut analysiert wird Innerhalb von vier Stunden erfahren die behandelnden Ärzte, wie hoch die Konzentration des ausgewählten Antibiotikums gegen den Erreger im Blut und im Gewebe des Patienten ist, und wie lange es im Körper des Patienten verbleibt „In dringenden Fällen schaffen wir dieses sogenannte Therapeutic Drug Monitoring auch in 45 Minuten“, meint Sörgel
Das älteste Bakterium ist 250 Millionen Jahre alt
Im Mund eines Menschen leben 1010 Bakterien
Ein erwachsener Mensch beheimatet rund 38 Billionen Bakterien
Da sich gerade bei Intensivpatienten der Zustand manchmal fast stündlich verändert, ist die Anwendung von Antibiotika hier äußerst schwierig und komplex Ein Maximalversorger wie das Klinikum benötigt diese Expertise für das Frühgeborene mit 380 Gramm Körpergewicht genauso wie für den schwerstgewichtigen Patienten mit 318 Kilo „Das Klinikum ist zum Vorreiter für diese schnelle, umfassende Überprüfung geworden In den meisten deutschen Kliniken stehen höchstens zehn Substanzen für eine schnelle Messung zur Verfügung“, sagt Sörgel

Für den verantwortungsvollen, zielgerichteten Einsatz von Antibiotika braucht es einen Fachmann, der den Gebrauch und Verbrauch dieser Arzneimittel an einer Klinik erfasst und bewertet Dieser „Antibotic Steward“ muss sich in zertifizierten Kursen qualifiziert haben
Am Klinikum Nürnberg hat diese Aufgabe Dr med Rainer Höhl, Oberarzt am Institut für Klinikhygiene, Medizinische Mikrobiologie und Klinische Infektiologie übernommen, der inzwischen zu den erfahrensten Antibiotic-Stewards in ganz Deutschland zählt Er gibt sein Wissen nicht nur an die Ärzt*innen des Klinikums weiter, sondern auch an Mediziner anderer Krankenhäuser
Antibiotic Stewardship ist aber nur ein Baustein im Leistungsspektrum des Instituts für Klinikhygiene, Medizinische Mikrobiologie und Klinische Infektiologie Ein solches Institut bieten fast nur universitäre Maximalversorger
Die Mitarbeitenden müssen immer wissen, was sie in welcher Situation zu tun haben, um hygienisch richtig zu handeln.
„Das Besondere bei uns ist, dass Prävention, Diagnostik und Therapie von Infektionskrankheiten in einer Hand liegen und wir deshalb ohne Schnittstellenverluste arbeiten können An anderen Krankenhäusern gibt es oft nur Teilinstitute“, erklärt Prof Dr med Jörg Steinmann, Chefarzt des Instituts für Klinikhygiene, Medizinische Mikrobiologie und Klinische Infektiologie am Klinikum Nürnberg
Bei der Prävention von Infektionskrankheiten kümmert sich im Institut speziell ausgebildetes Hygienefachpersonal darum, dass im Klinikum sämtliche Hygiene-Regeln nach dem aktuellen Stand der Wissenschaft umgesetzt und eingehalten werden - seien es Vorgaben vom Robert Koch-Institut oder der Bayerischen Medizinhygieneverordnung Dazu werden Mitarbeitende geschult oder Pflegekräfte und Ärzt*innen als Hygienebeauftragte ausgebildet, die dann eine übernehmen
„Die Mitarbeitenden müssen immer wissen, was sie in welcher Situation zu tun haben, um hygienisch richtig zu handeln“, verdeutlicht Steinmann Auch Wasseruntersuchungen zum Beispiel auf Legionellen oder die Kontrolle der Lüftung in den Operationssälen gehören zu den Aufgaben des Instituts, das auch über HygieneIngenieure verfügt

Das seit den 1920erJahren bestehende Hygieneinstitut leistet einen wesentlichen Beitrag zur Entdeckung von Infektionskrankheiten
Damit die Infektionskrankheit eines Patienten zügig und gezielt behandelt werden kann, ist ein schneller, qualitativ hochwertiger Befund das Hauptziel der Arbeit im diagnostischen Bereich Die Experten weisen Bakterien, Viren, Pilze oder Parasiten mit mikrobiologischen, serologischen und molekularbiologisch Untersuchungen nach Auch in der Corona-Pandemie spielt das Institut eine wichtige Rolle, am Tag werden dort bis zu 1000 PCR-Tests bei Patienten wie Mitarbeitenden gemacht und ausgewertet Das Ergebnis liegt häufig noch am selben Tag vor


Wer eine Fernreise plant und sich keine unliebsamen „Urlaubsmitbringsel“ einhandeln möchte, kann – rechtzeitig vorher - die Reise- und Impfberatung am Hygiene-Institut nutzen Seit Jahrzehnten ist die Abteilung des Klinikums auch als Gelbfieber-Impfstelle zugelassen

Infusionen, Injektionen, Salben, Cremes, Tabletten, Kapseln, Zäpfchen, Ernährungsinfusionen für Babys oder Zytostatika, also Medikamente, die für die Chemotherapie von Krebspatienten benötigt werden – all das kann die Apotheke am Klinikum Nürnberg selbst herstellen Sie zählt zu den größten Kranken-
Es ist ein Segen, dass wir Präparate in unserer Apotheke selbst herstellen können.
hausapotheken in ganz Deutschland Was immer die vielen Abteilungen an den beiden Standorten des Klinikums in Nürnberg oder auch die Krankenhäuser in Lauf oder Altdorf brauchen, die eigene Apotheke übernimmt die Versorgung
Zwar machen Fertigarzneimittel aus der Industrie den Löwenteil aus –sowohl mengenmäßig als auch von den Kosten her Aber die Eigenherstellung sichert die Versorgung der Patient*innen oft ganz besonders ab „Zeitweise waren während der Corona-Pandemie zum Beispiel Medikamente für Beatmungspatienten ausverkauft“, berichtet Dr Annette Sattler, die Leitende Apothekerin Denn was Laien nicht bedenken, wenn sie Bilder von Corona-Intensivstationen sehen: Es braucht nicht nur Beatmungsgeräte, Sauerstoff und Personal, sondern eben auch Medikamente, um die Patienten ins künstliche Koma legen zu können Und die gab es nicht mehr „Es war ein Segen, dass wir diese Präparate in unserer Apotheke selbst herstellen konnten“, meint Sattler

Die alte Apotheke ist heute Teil des Krankenhausmuseums am Klinikum Nürnberg Standort Nord

Das Know-how und die technische Ausstattung, um die Gesamtpalette der Eigenherstellung abdecken zu können, haben viele Krankenhausapotheken im Gegensatz zum Klinikum Nürnberg nicht mehr Am Standort in Johannis gibt es zum Beispiel ein spezielles Reinraumlabor, in dem Infusionen und Injektionen für die Chemotherapie hergestellt werden - ganz individuell für jeden einzelnen Patienten Und im Südklinikum werden in einem Reinraum Ernährungsinfusionen für Säuglinge oder auch andere Spritzen und Infusionen in der erforderlichen Kinderdosierung hergestellt Auch Medikamente, die von den Pharmaherstellern vom Markt genommen worden sind, weil sie nicht mehr als lukrativ erachtet werden, können von den Apothekern im Südklinikum „nachgebaut“ werden, um Patienten optimal zu versorgen

185 Liter Desinfektionsmittel stellt die Apotheke pro Tag dem Klinikum zur Verfügung
2021 hat die Apotheke 441 Blutegel und über 10 000 Fliegenlarven der Goldfliege ausgegeben Sie sind ein offiziell zugelassenes Arzneimittel
Die Apotheke liefert jedes Jahr 450 000 Bestellungen an die Kliniken
Auch eine pharmazeutische Betreuung bietet die Apotheke Die Stationen können elektronisch für Patienten, die an mehreren Erkrankungen gleichzeitig leiden und deshalb viele unterschiedliche Medikamente einnehmen, sogenannte Arzneimittel-Konsile anfordern Die Apotheker prüfen dann, ob der Verordnungsplan „passt“, also die Arzneien nicht zu unerwünschten Wechselwirkungen führen Sattler: „Dieser Bereich wächst stetig Um diesen Service wirklich flächendeckend bieten zu können, reicht unser Personal aber derzeit nicht aus “
Einfach QR-Code scannen und hinter die Kulissen schauen
Es war ein Paukenschlag, als der Bericht zur Ethik am Nürnberger Klinikum 1999 an die Öffentlichkeit gelangte Der Hamburger Medizinethiker Prof Karl-Heinz Wehkamp hatte mit knapp 400 Mitarbeiterinnen und Mitarbeitern gesprochen und sich von ihnen schildern lassen, wie sie ihre Arbeitswelt erleben, welche Kritikpunkte und Verbesserungsvorschläge sie haben Diese „Nabelschau“ offenbarte Konflikte, die hauptsächlich im Umgang der Beschäftigten untereinander begründet waren – beklagt wurden etwa unfaire Kritik, fehlende Wertschätzung oder mangelhafte Kommunikation
Die Wellen schlugen hoch, doch letztlich machte das Dossier nur eine Polarisierung deutlich, die durch den zunehmenden wirtschaftlichen Druck im Gesundheitswesen an allen Krankenhäusern aufgebrochen war Banal ausgedrückt: Die „Guten“, sprich Ärzt*innen und Pflegende, die für die Menschlichkeit in der Patientenversorgung kämpfen, stehen den „Bösen“ aus der Verwaltung gegenüber, die nur eine ausgeglichene Bilanz im Auge haben
„Die Medizin muss ökonomischer und die Ökonomie humaner werden Das kann nur in einem Klima von Respekt und Toleranz gelingen“, schlussfolgerte Medizinethiker Wehkamp und schlug vor, mit allen Mitarbeitenden des Klinikums gemeinsam eine Diskussion darüber

zu führen, welche Werte für ihre Arbeit am Patienten, aber auch im Umgang miteinander richtungsweisend sind

So entstand in der Folge der Ethik-Codeeine Richtschnur für das gesamte Handeln im Klinikum, ein Verhaltenskodex für alle Mitarbeitenden, eine Grundlage für faire Streitkultur Damit war das Klinikum Nürnberg das erste große Krankenhaus in Deutschland, das schriftlich niedergelegt hatte, wie Konflikte vermieden und bewältigt werden sollten Das Ethik-Projekt wurde für viele Krankenhäuser zum Vorbild
„Der Ethik-Code hat sich im Lauf der Jahre nicht zum Papiertiger entwickelt, er wird nach wie vor gelebt“, meint Prof Dr med Frank Erbguth, langjähriger Chefarzt am Klinikum und bis zu seinem Ruhestand Vorsitzender des Ethik-Forums, das seit 2002 als die „Ethik-Zentrale“ des Klinikums gilt Das Forum tagt viermal im Jahr und ist mit unterschiedlichen Vertreter*innen aus dem Klinikum, aber auch „Externen“ wie Juristen, Theologen oder Repräsentanten von Krankenkassen besetzt Das Gremium erarbeitet
Der Ethik-Code ist ein fester Bestandteil des Handelns am Klinikum Nürnberg. Er wird gelebt und weiterentwickelt.
Stellungnahmen oder Entscheidungshilfen, wenn es zum Beispiel um die Frage geht, ob Beschneidungen vorgenommen werden sollen „Dazu gab es 2012 einen Bundestagsbeschluss Insofern haben wir hier keine Entscheidung getroffen, sondern eine ordnende Kommentierung vorgenommen“, meint Erbguth
Auch in der Diskussion darüber, ob ein Streik Leben gefährdet, hat das Ethik-Forum ein Positionspapier erarbeitet
Die Zentrale Mobile Ethikberatung (ZME) ist ebenfalls beim Forum angesiedelt Hier geht um Konflikte: Wenn zum Beispiel Angehörige möchten, dass die Beatmung eines Patienten fortgesetzt wird, Mediziner aber davon abraten „Die Entscheidung trifft der behandelnde Arzt und nicht die ZME Aber wir erleben immer wieder, dass dem Konflikt ein Kommunikationsproblem zugrunde liegt und die ZME durch ihre ordnende Funktion oft zu einer einvernehmlichen Lösung führt“, so Erbguth Er würde sich wünschen, dass die Mobile Ethikberatung häufiger eingeschaltet wird
In Gesprächsrunden tauschen sich EthikInteressierte am Klinikum regelmäßig über Themen aus Schließlich kümmert sich das Ethik-Forum auch noch um das Thema Patientenverfügung und Vorsorgevollmacht
Dank der modernen Medizin stehen bei Herz-Gefäß-Erkrankungen heute auch älteren und hochbetagten Patientinnen und Patienten gute Verfahren in Diagnostik und Therapie zur Verfügung Weil diese aufeinander abgestimmt sein müssen, arbeiten am 2011 eröffneten HerzGefäß-Zentrum (HGZ) des Klinikums Nürnberg Expertinnen und Experten der Kardiologie, Herzchirurgie, Gefäßchirurgie, Radiologie und Nuklearmedizin Hand in Hand

„Die Diagnose zu einem möglichst frühen Zeitpunkt ist entscheidend, um schleichende Erkrankungsprozesse am Herz und an den Gefäßen zu erkennen und durch eine gezielte Therapie möglicherweise noch aufzuhalten zu können“, betont Prof Dr med Matthias Pauschinger, ärztliche Leitung der Klinik für Innere Medizin 8, Schwerpunkt Kardiologie
Rund 22 000 Patientinnen und Patienten mit unterschiedlichen Herzund Gefäßerkrankungen werden am Herz-Gefäß-Zentrum jährlich untersucht und stationär behandelt, Tendenz steigend „Die Menschen werden immer älter Damit steigt auch die Wahrscheinlichkeit, dass das Herz irgendwann nicht mehr so mitmacht oder Gefäße sich verengen oder verschließen“, ergänzt Prof Dr med Theodor Fischlein, Chefarzt der Herzchirurgie „Die gute Botschaft ist: Wir können hier am Klinikum Nürnberg auch hochbetagte Menschen noch mit sehr guten Ergebnissen behandeln oder auch operieren“, sagt sein Kollege Prof Dr med Eric Verhoeven von der Klinik für Gefäßchirurgie Die Abklärung und Planung von Eingriffen am Herzen und den großen Gefäßen erfolgt in vielen Fällen nicht-invasiv mittels Computer- oder Magnetresonanztomographie (CT, MRT) oder mithilfe nuklearmedizinischer Verfahren (SPECT) durch das Institut für Radiologie von Prof Dr med Michael Lell
Ist ein größerer Eingriff notwendig, der mehrere Fachbereiche betrifft, besprechen die Expert*innen des HGZ diesen gemeinsam Ziel ist immer eine möglichst geringe Belastung des Körpers und ein möglichst langfristiger Erfolg für den Patienten So können z B Herzklappen oder Gefäßprothesen heute über einen Katheter mit modernsten bildgebenden Verfahren implantiert werden
Auch bei Aorten- und Mitralklappen wählen die Experten wenn möglich die schonendste Variante und führen den Eingriff minimalinvasiv durch
Bei komplexen Fällen stehen Ärzt*innen der Fachrichtungen Seite an Seite am OP-Tisch Die beiden mit allen technischen Möglichkeiten ausgestattete Hybrid-OPs des HGZ bieten die besten Voraussetzungen auch für schwierige Eingriffe

Ergänzt wird die hohe Fachkompetenz durch die Klinik für Psychosomatische Medizin und Psychotherapie von Prof Dr med Christiane Waller am Klinikum Nürnberg Nord, die als eine der wenigen Kliniken in Deutschland Patientinnen und Patienten ein psychokardiologisches Angebot macht

Depressionen können jeden treffen, sie haben viele Gesichter und sie sind behandelbar: Mit diesen drei Kernbotschaften klärt der Verein „Nürnberger Bündnis gegen Depression“ seit gut 20 Jahren über diese Volkskrankheit auf
Niemand kann etwas dafür, wenn er an einer Depression erkrankt.
Schätzungsweise vier Millionen Menschen leiden in Deutschland an einer Depression Sie befinden sich in einem anhaltenden emotionalen Tief, aus dem sie oft alleine nicht mehr herausfinden Dazu kommt, dass Betroffene manchmal mit wenig verständnisvollen Reaktionen aus ihrem Umfeld konfrontiert werden „Stell dich nicht so an“ oder „Reiß dich zusammen“ heißt es, wenn sie in ihrem Alltag nicht mehr wie gewohnt funktionieren „Solche Kommentare sind Unsinn, denn Depressionen sind eine Krankheit wie viele andere auch Niemand kann etwas dafür, wenn er daran erkrankt“, erklärt Evelyn Kretzschmar, lokale Koordinatorin beim Bündnis gegen Depression
Aufklärung zu leisten und die Öffentlichkeit mehr für das Thema zu sensibilisieren war ein Grund dafür, dass die Münchner Maximilians-Universität ein bundesweit einmaliges Studienprojekt initiierte, das 2001 in Nürnberg an den Start ging
Einer der Gründungsväter war Prof Dr Dr Günter Niklewski, ehemaliger Chefarzt der Klinik für Psychiatrie und Psychotherapie am Klinikum Nürnberg Zwei Jahre später wurde ein gemeinnütziger Trägerverein mit Mitgliedern aus unterschiedlichen Professionen und Einrichtungen in der Region gegründet Das Klinikum unterstützt bis heute den Verein, der auf dem Gelände des Südklinikums angesiedelt ist
„Wir sind keine Beratungsstelle“, stellt Kretzschmar klar Der Verein organisiert öffentliche Veranstaltungen oder Fortbildungen, gibt Informationsflyer heraus, die auch in unterschiedlichen Sprachen erscheinen, oder verweist auf bereits bestehende Beratungs- und Hilfsangebote
Wie wichtig diese Arbeit ist, zeigt auch die Tatsache, dass psychische Erkrankungen und insbesondere Depressionen häufig Ursache von Suiziden sind „Wer sich aber professionelle Hilfe sucht, bekommt die Krankheit mit Medikamenten oder Psychotherapie zumindest gut in Griff“, meint Kretzschmar
Den Erfolg der Aufklärungsarbeit konnte das Bündnis gegen Depression gleich nach dem ersten Jahr seines Bestehens sehen: Die Zahl der Menschen, die ihrem Leben selbst eine Ende setzten, nahm in Nürnberg um 25 Prozent ab

Das Klinikum Nürnberg zählt zu den größten Notfallversorgern in Deutschland Im Schnitt werden in den beiden Notaufnahmen im Klinikum Nord und im Klinikum Süd insgesamt 115 000 Patientinnen und Patienten pro Jahr versorgt Je nach Diagnose können Ärztinnen und Ärzte aus mehr als 20 Fachabteilungen zugezogen werden – jeden Tag rund um die Uhr


Bei schweren Unfällen steht ein interdisziplinäres Team im Schockraum bereit.
„Vor Corona haben wir am Tag 250 Patienten hier am Standort in Langwasser versorgt“, berichtet Oberarzt Dr med Steffen Popp, Leiter der Zentralen Notaufnahme am Klinikum Süd In seinem Bereich kümmern sich Kernteams mit Internisten, Neurologen, Unfallchirurgen und geschulten Pflegefachkräften um die Notfallpatienten Je nach Diagnose werden – wenn notwendig – noch andere Fachabteilungen hinzugezogen Wie etwa bei einem sogenannten Schockraum-Patienten „Wenn uns zum Beispiel ein Schwerverletzter nach einem Verkehrsunfall angekündigt wird, dann stehen im Schockraum bei seinem Eintreffen schon Kollegen aus den Bereichen Anästhesie, Radiologie und Unfallchirurgie parat “
Und falls das Unfallopfer noch eine Hirnblutung oder eine massive Gefäßverletzung hat, dann sind auf kürzestem Weg auch noch Fachleute aus der Neurochirurgie oder der Gefäßchirurgie mit am Tisch Genauso werden Patient*innen mit schweren Herzinfarkten oder akuten Schlaganfällen in einem zweiten Schockraum interdisziplinär versorgt
Die Notaufnahmen des Klinikums Nürnberg versorgen Patient*innen aus der gesamten Region Vom Knochenbruch bis zum Unfallopfer
Ansonsten nimmt in der Notaufnahme speziell geschultes Pflegepersonal eine Ersteinschätzung darüber vor, wie kritisch der Zustand eines gerade angekommenen Patienten ist Nach exakt festgelegten Kriterien gibt es dabei fünf Stufen – Schweregrad 1 bedeutet dabei oberste Priorität Popp: „Seit zwei Jahren nimmt die Zahl der kritisch kranken Patienten mit Schweregrad 1 oder 2 bei uns wieder deutlich zu “ 2020 wurden am Südklinikum insgesamt 28 000 solcher Schwerst- und
Schwerkranken versorgt „Dieser Trend geht eindeutig in eine von uns gewünschte Richtung, denn genau für diese kritischen Patienten sind wir als Maximalversorger die richtige Anlaufstelle“, meint Popp Zum Glück kommen immer weniger Patienten wegen eines wenig dringlichen gesundheitlichen Problems in die Notaufnahme Diese Patienten finden dann Hilfe in den Bereitschaftspraxen, die an beiden Standorten in nächster Nähe zu finden sind

Mit 17 Messplatz-Betten ist das Schlaflabor am schlafmedizinischen Zentrum des Klinikums das größte in Bayern „Wir können hier Patient*innen mit allem schlafmedizinischen Krankheitsbildern behandeln, die es gibt“, erklärt Oberärztin Dr med Dora Triché, die Leiterin des Schlaflabors
Besonders häufig sind schlafbezogene Atmungsstörungen wie etwa die sogenannte obstruktive Schlafapnoe Die Betroffenen bekommen – meist ohne es selbst zu bemerken beim Schlafen schlecht Luft und haben kurze Atemaussetzer Schnarchen an sich ist harmlos, aber wenn es dabei zu Atempausen kommt und die Schlafenden nicht mehr genug Sauerstoff bekommen , kann dies erhebliche gesundheitliche Folgen haben Die Betroffenen wachen häufig in der Nacht ganz kurz auf, jedes Mal fährt dabei der Organismus hoch, Blutdruck und Puls steigen und der Körper schüttet Stresshormone aus Dies erhöht das Risiko zum Beispiel für Herz-Kreislauferkrankungen, sorgt aber auch für Tagesmüdigkeit, Konzentrationsprobleme oder gar Depressionen

„Wir können den Patienten mit allen aktuellen, modernen Therapieformen helfen, von einer ÜberdruckAtemmaske über Aufbiss-Schienen
bis hin zu speziellen Schrittmachern, die den Zungennerv stimulieren und so die Schlafapnoe beheben können“, erklärt Triché Auch Schlafwandler finden Hilfe „Allerdings liegt hier der Schwerpunkt unserer Arbeit mehr auf Diagnose und Beratung Wir erklären zum Beispiel, wie der Patient sein Schlafumfeld sicherer machen kann, um zum Beispiel nicht aus dem Fenster oder vom Balkon zu stürzen“, so die Oberärztin
Die Patient*innen werden in der Regel von niedergelassenen Ärzten ins Schlaflabor eingewiesen und bleiben im Durchschnitt zwei bis drei Nächte Allerdings muss mit einer mehrwöchigen Wartezeit bis zu einem Termin im Schlaflabor gerechnet werden
Das Zentrum für Verbrennungsbehandlung
„Wir wollen gemeinsam das Beste herausholen, was man sich beim Thema Brandverletzungen vorstellen kann,“ fasst Prof Dr med Bert Reichert, Chefarzt der Klinik für Plastische, Wiederherstellende und Handchirurgie am Klinikum Nürnberg, kurz und knapp das Konzept des Zentrums für Verbrennungsbehandlung zusammen

Ein interdisziplinäres Team aus plastischen Chirurgen, Anästhesisten, Kinderchirurgen, Pflegekräften, Psychologen sowie Ergo- und Physiotherapeuten kümmert sich dort um Menschen, die Verletzungen durch Feuer, Verbrühungen, Explosionen oder auch Chemikalien und Elektrizität erlitten haben In einem eigenen Operationssaal und auf einer spezialisierten Intensivstation können selbst Schwerstbrandverletzte optimal versorgt werden „Es gibt in ganz Nordbayern niemanden, der bei Verletzungen durch Hitzeschäden so ausgestattet und erfahren ist, wie wir hier im Südklinikum“, so Reichert
Doch dem Chefarzt liegt vor allem eine Botschaft am Herzen: Das Zentrum steht nicht nur Menschen mit lebensbedrohlichen Verletzungen offen Es können und sollen auch Patient*innen mit kleineren Hitzeschäden die Expertise der Spezialisten dort nutzen „Wenn zum Beispiel eine Wärmflasche ausläuft und Verbrühungen am Unterschenkel entstehen, dann sollten die Betroffenen nicht selbst mit Hausmitteln herumhantieren, denn das geht meistens schief“, warnt der Mediziner
Reichert verweist in diesem Zusammenhang besonders auf Kleinkinder „Ihre Haut ist extrem empfindlich Schon eine umgekippte Tasse heißer Tee kann zu schwerwiegenden, sogar lebensbedrohlichen Verbrühungen und großflächigen Narben etwa am Oberkörper führen “
Ein wichtiger Baustein der Zentrumsarbeit ist deshalb Prävention und Aufklärung Dr med Karl Bodenschatz, Chefarzt der Kinderchirurgie und Sprecher des Zentrums für Verbrennungsbehandlung, wird nicht müde, bei Veranstaltungen und mit Informationskampagnen besonders jungen Eltern die möglichen Gefahren für ihre Kinder bewusst zu machen
Mit Spezialsprechstunden steht das Zentrum für Verbrennungsverletzungen Betroffenen auch nach der Akutbehandlung als Anlaufstelle offen
Ein Krankenhausaufenthalt ist für niemanden eine angenehme Sache Für Senior*innen bedeutet er oft eine Herausforderung Ältere Menschen leiden häufig nicht nur an einer Erkrankung, sondern an mehreren gleichzeitig Wieder andere sind in ihrer Mobilität oder in ihren geistigen Fähigkeiten eingeschränkt Und auch Ängste oder Depressionen können dazu führen, dass Senioren ihren Alltag vielleicht nicht mehr so gut bewältigen können „Genau für solche Patienten ist unser Zentrum für Altersmedizin geschaffen worden“, erklärt Prof Dr med Markus Gosch, Chefarzt der Geriatrie und Sprecher des Zentrums

Wir wollen die Selbstständigkeit der Senioren längstmöglich erhalten.
Das Besondere an dem bundesweit einmaligen Versorgungskonzept: Ärztinnen und Ärzte aus der Geriatrie, der Neurologie und der Psychiatrie kümmern sich zusammen mit speziell geschulten Pflegekräften und Experten aus anderen Berufsgruppen um die Patienten Die Ärzte kommen ins Zentrum für Altersmedizin, das im Dr Theo-Schöller-Haus, dem Empfangsgebäude des Nordklinikums, untergebracht ist Das Gros der Patientinnen und Patienten gehört der Altersgruppe 75 plus an „Der fitte 80-Jährige, der zum Beispiel nur ein kardiologisches Problem hat, braucht uns nicht Unser Therapieangebot richtet sich an Menschen, die Erkrankungen aus verschiedenen Bereichen haben und bereits Einbußen in ihrem Alltag erlebt haben“, so Gosch
Um abzuklären, wie den Senioren am besten geholfen werden kann, braucht es nicht immer einen stationären Aufenthalt Deshalb gibt es auch eine Tagesklinik, in der verschiedene Therapien eingesetzt werden Die Besucher werden morgens von zu Hause abgeholt und nachmittags zurückgebracht „Für Frühstück und Abendessen oder auch am Wochenende sind sie auf sich allein gestellt Das ist gewollt, denn so bleiben diese häuslichen Tätigkeiten erhalten“, so Gosch Nicht wenigen hilft dieses „Trainingsprogramm“, einen Umzug ins Pflegeheim zu vermeiden

Digitalisierung ist aktuell eines der großen Themen unserer Gesellschaft, viele Erwartungen sind damit verbunden Im Vergleich mit anderen Branchen hat das Gesundheitswesen einen besonders hohen Nachholbedarf Man denke nur an die Ausstattung der Gesundheitsämter, die ihre Kommunikation unlängst noch mit Faxgeräten erbringen mussten – mit vielen ungünstigen Folgen während der Pandemie

Menschen der älteren Generation, die zu Beginn ihres Berufslebens bestenfalls auf Taschenrechner zurückgreifen konnten, ansonsten aber gänzlich chiplos unterwegs waren, sehen dies mit einem gewissen Staunen: Ende der 1980er-Jahre war die Möglichkeit, Dokumente per Fax versenden zu können, ein gefühlter Quantensprung Und als es die ersten PCs gab, konnte eine besorgte Stationsschwester auch einmal auf den Gedanken kommen, die Maus lieber auf die Tischplatte zu kleben, sie würde doch sonst bestimmt herunterfallen
Computer und Daten sind allgegenwärtig Vielerorts haben sie entscheidende Vorteile im Vergleich mit der traditionellen Handhabung von Informationen auf Papier Oder auf Röntgenfilm: Schnell haben wir uns daran gewöhnt, digitalisierte Darstellungen bildgebender Untersuchungen nahezu unbegrenzt und jederzeit aufrufen zu können Im Hintergrund arbeiten vernetzte Systeme, um medizinische Daten aktuell und sicher bereitzustellen Gerade auch auf diesem Weg, hin zu einer digitalen Patientenakte, möchte das Klinikum Nürnberg in den nächsten Jahren vorankommen
Von der Digitalisierung erhoffen wir uns auch eine Verbesserung von Prozessen, sie sollen beispielsweise zu mehr Effektivität und Sicherheit führen Patientinnen und Patienten sollen zeitgemäß, über das Internet, mit unserem Haus kommunizieren können, zum Beispiel, um Termine zu vereinbaren
Sicherheit ist in erster Linie Patientensicherheit Die automatische Überprüfbarkeit maschinell verarbeitbarer Informationen auf einer Blutkonserve wird das Risiko von Zwischenfällen weiter senken Einfach verfügbare Apps, sogenannte Digitale Gesundheitsanwendungen (DiGAs), helfen bereits jetzt, therapeutische Entscheidungen noch besser treffen zu können, zum Beispiel, weil sie auf Wechselwirkungen zwischen Medikamenten oder Kontraindikationen hinweisen können
In der Zukunft sollen Behandlungen noch individueller werden, man spricht von der Personalisierten Medizin Erst durch die Digitalisierung, die die Möglichkeit eröffnet, große Datenmengen zu erheben, zu bearbeiten und auszuwerten, können die dafür erforderlichen Erkenntnisse entstehen und nutzbar gemacht werden
Ein besonders spannendes Gebiet ist „künstliche Intelligenz“, bei der medizinische Entscheidungsstrukturen nachgebildet werden Schon seit Längerem werden auch am Klinikum Nürnberg Methoden dieser Art angewendet Darüber hinaus werden neue Anwendungsmöglichkeiten im Rahmen wissenschaftlicher Studien erarbeitet, beispielsweise in der Hautklinik
Mit dem Krankenhauszukunftsgesetz stellt die Bundesregierung Mittel zur Verfügung,
die die Nutzung digitaler Werkzeuge und Instrumente in den Krankenhäusern beschleunigen sollen Krankenhausinformationssysteme und Softwarelösungen sollen besser zusammengeführt werden, klinische Prozesse wirksam durch Informationstechnik unterstützt, Daten von Medizingeräten integriert, telemedizinische Netzwerke weiterentwickelt und Partizipationsmöglichkeiten für Patienten verbessert werden

Bei all dem dürfen wir nicht vergessen, dass verantwortungsvoll vorgegangen werden muss: Patient*innen müssen darauf vertrauen können, dass ihre Daten zuverlässig vor Missbrauch und Diebstahl geschützt sind
Ein für viele bislang beispielloser Vorgang in dieser Hinsicht war es, den elektronischen Heilberufsausweis zu beantragen Aber seien wir ehrlich: Telematik bedeutet, dass die Daten den geschützten Raum eines Krankenhauses verlassen Gezielte Schutzmaßnahmen sind daher nachvollziehbar erforderlich Es muss klar sein, dass sich jeder auf die erforderliche Diskretion und Schweigepflicht verlassen können muss
Prof Dr med Bert Reichert
Die Ambulantisierung im Gesundheitswesen schreitet in Deutschland seit Jahren voran Immer mehr medizinische Behandlungen können - oder müssen laut Gesetzgeber sogar – heute außerhalb der stationären Struktur eines Klinikums erbracht werden Dies soll in den Krankenhäusern und Kliniken Kapazitäten für Patientinnen und Patienten schaffen, die einer stationären Behandlung aufgrund komplexer Erkrankungen dringend bedürfen Das stellt die Krankenhäuser vor große Herausforderungen Es schafft aber auch Potenziale
Das Klinikum Nürnberg hat dieser Entwicklung schon frühzeitig Rechnung getragen Seit Beginn der 2000er-Jahre macht es seinen Patientinnen und Patienten wohnortnahe Angebote im Bereich der Ambulanten Versorgung und schafft damit qualifizierte Bindeglieder zwischen stationärer und ambulanter Versorgung
Die A.R.Z.- Ambulantes Rehabilitationszentrum Nürnberg gGmbH
Einen entscheidenden Schritt ging das Klinikum Nürnberg Anfang der 2000er Jahre, als es sich entschied, seinen Patientinnen und Patienten gemeinsam mit der Landesversicherungsanstalt Oberfranken und Mittelfranken (heute Deutsche Rentenversicherung Nordbayern) Leistungen zur Rehabilitation im ambulanten Sektor anzubieten
Mit dem Ambulanten Rehabilitationszentrum in der Rosenberger Straße in Nürnberg bekamen Patient*innen erstmals auch in den Fachbereichen Neurologie und Kardiologie die Möglichkeit, wohnortnah eine Reha anzutreten – ein Novum in Nürnberg Die 2002 gegründete A R Z - Ambulantes Rehabilitationszentrum Nürnberg GmbH hat mit ihrem Angebot längst einen festen Platz in der medizinischen und rehabilitativen Versorgung der Region Auf der Grundlage eines ganzheitlichen Rehabilitationskonzepts werden Patientinnen und Patienten
nach einer Operation oder schweren Erkrankung befähigt, wieder aktiv am Leben teilzuhaben Dafür steht ein hochqualifiziertes, multiprofessionelles Team aus Rehabilitationsmediziner*innen sowie Therapeutinnen und Therapeuten bereit

Neben der ambulanten Rehabilitation in den Fachbereichen Orthopädie/Unfallchirurgie, Neurologie und Kardiologie für Versicherte aller Kostenträger bietet die A R Z - gGmbH intensivierte Rehabilitationsnachsorge (IRENA), erweiterte Ambulante Physiotherapie für die Berufsgenossenschaften (EAP) sowie Einzel- und Gruppenbehandlungen auf Heilmittelverordnung für Physiotherapie, Ergotherapie und Logopädie an
Beate Neuffer
Von einer engen Verzahnung zwischen stationärer und ambulanter Versorgung profitieren alle Patient*innen.

Die Ambulanten BehandlungsCentren
2006 hat das Klinikum Nürnberg sein erstes Medizinisches Versorgungszentrum am Standort Nürnberg Nord eröffnet Es steht Patientinnen und Patienten unabhängig vom Versicherungsstatus offen und ist ein wichtiges Bindeglied zwischen ambulanter und stationärer Versorgung In den vergangenen 15 Jahren sind weitere Medizinische
Dem vertrauensvollen Austausch mit Hausärzten und Facharztpraxen kommt auch deshalb eine solch bedeutende Rolle zu, da das Klinikum Nürnberg als Maximalversorger nicht in Konkurrenz zu Haus- und Facharztpraxen treten, sondern mit seiner Expertise - wann immer sinnvoll und gewünscht - auch im ambulanten Bereich einen Beitrag zur bestmöglichen Patientenversorgung leisten möchte
Durch die optimale Vernetzung und das enge Zusammenwirken zwischen der ambulanten Versorgung und einem möglicherweise notwendigen stationären Aufenthalt profitieren Patientinnen und Patienten von einer - zwischen den verschiedenen Leistungserbringern abgestimmten - medizinischen Versorgung auf höchstem Niveau
Versorgungszentren in der Stadt Nürnberg sowie im Nürnberger Land mit identischem Konzept hinzugekommen, die ein gemeinsames Merkmal verbindet: Patientinnen und Patienten erhalten stets eine hochkompetente, fachübergreifende Versorgung aus einer Hand
Hier wie dort arbeiten Fachärzt*innen aus unterschiedlichen medizinischen Abteilungen übergreifend und in enger Abstimmung mit den niedergelassenen Kolleginnen und Kollegen zusammen
Die Ambulanten BehandlungsCentren des Klinikums Nürnberg decken nahezu alle Fachbereiche ab Diese reichen von der Anästhesie/Schmerztherapie über die Augenheilkunde, die Chirurgie/Orthopädie, Gynäkologie/Geburtshilfe, Hals-, Nasen-, Ohrenheilkunde, Haut- und Geschlechtskrankheiten, die Kinderkardiologie/Kinderneurologie/Kinderchirurgie, Mund-, Kiefer-, Gesichtschirurgie, Neurologie, Nuklearmedizin und Neurochirurgie bis hin zu allen wichtigen Disziplinen der Inneren Medizin Auch die Physikalisch-Rehabilitative Medizin, Psychotherapie und Psychiatrie, Radiologie (MRT, CT, Mammographie), Sportmedizin/Sportorthopädie sowie Urologie und Zahnmedizin sind vertreten
 Alexander Pazicky
Alexander Pazicky
Ein Krankenhaus ohne Pflege ist nicht denkbar, sie ist das Herzstück der Versorgung der Patientinnen und Patienten Am Klinikum Nürnberg sind es über 2500 Menschen, die sich tagtäglich darum kümmern, dass Kranke rund um die Uhr auf höchstem Niveau medizinisch und pflegerisch versorgt werden Die interprofessionelle Teamarbeit zum Wohle der Patient*innen ist ganz entscheidend


Das Pflegebild hat sich in den vergangenen Dekaden stark gewandelt
Die Rot-Kreuz-Schwestern (links) waren über viele Jahrzehnte Garanten für gute Pflege am Klinikum Nürnberg
Dabei hat sich kaum ein Berufsbild über die Jahrzehnte so enorm und facettenreich entwickelt wie der Pflegeberuf Der zunehmende Professionalisierungsgrad hat dazu beigetragen Pflege- und Behandlungsstandards weiterzuentwickeln und den Pflegeberuf in Management, Wissenschaft und Pädagogik zu akademisieren
Längst hat sich zudem ein breiter Skill- und Qualifikationsmix etabliert Neben Pflegenden mit langjähriger Berufserfahrung, generalistisch ausgebildeten Pflegenden und Pflegenden mit akademischem Abschluss sind auch Altenpflegefachkräfte, Pflegefachhelfer und medizinische Fachangestellte am Klinikum Nürnberg tätig
Die Pflege am Klinikum ist hochprofessionell. Teamarbeit und ein gutes Betriebsklima sind uns wichtig. Davon profitiert der Patient.
Peter Schuh, Vorstand Personal und Pflege
Als Maximalversorger bietet das Klinikum Nürnberg heute mehr als 2500 Mitarbeitenden das komplette Spektrum des Pflegeberufs und damit alle Voraussetzungen für einen sicheren, modernen und wertvollen Arbeitsplatz in der Pflege Die bislang gute Personalausstattung als öffentlicher Krankenhausträger macht das Klinikum Nürnberg als Arbeitgeber attraktiv Menschen, die

sich für den Pflegeberuf interessieren, finden hier vielfältige Möglichkeiten, sich aus-, fort- und weiterzubilden
Die Pflege am Klinikum Nürnberg beruht auf einer hohen Pflegekompetenz Das Konzept der Bereichspflege hat in den vergangenen Jahren den Blick auf den Patienten fokussiert Er wird heute ganzheitlich gepflegt und betreut Um die hohe Pflegequalität zu sichern, wurde vor vier Jahren ein Qualitätszirkel, das PFLEGEFORUM, ins Leben gerufen Mitarbeitende aus allen klinischen Bereichen beschäftigen sich intensiv mit pflegeinhaltlichen Themen und erstellen für alle Bereiche gültige Verfahrensregelungen, deren Umsetzung einem Monitoring unterliegt Das erhöht die Patientensicherheit und -zufriedenheit entscheidend
Für die zukünftige Nachbesetzung der Führungskräfte wurde ein Führungskräfte-Trainee-Programm implementiert Mitarbeitende erhalten die Möglichkeit, sich intensiv mit den Themen „Führung“ und „Management“ auseinanderzusetzen Sie hospitieren in verschiedenen Abteilungen und zentralen Diensten und bekommen dadurch einen ganzheitlichen Blick auf das Unternehmen Klinikum Nürnberg
Soziale Kompetenz und Beziehungsarbeit am und mit dem Patienten werden aber weiterhin ein maßgeblicher Bestandteil der Pflege sein, der nicht digitalisiert werden kann Und genau das macht Pflege so wertvoll Sie zeichnet sich dadurch aus, dass sie den Blick auf den ganzen Menschen richtet Diese Betrachtungsweise vollzieht sich in allen Perspektiven der Pflegearbeit: in der Förderung, im Erhalt und in der Übernahme der alltäglichen Lebensaktivitäten eines Menschen in allen Lebensphasen Weil Pflege diese Komplexität und Vielschichtigkeit hat und die Anforderungen an die Pflegenden hoch sind, kann sie nicht einfach durch Robotik ersetzt werden Pflege ist und bleibt Beziehungsarbeit
Hinzu kommen die Entwicklungen Richtung Krankenhauszukunftsgesetz, das die Pflegearbeit digital stark verändern wird Neben digitalen Dokumentationsmedien werden zukünftig mehr innovative Technologien im Pflegealltag zum Einsatz kommen, die aktiv dazu beitragen, dass die Pflegenden von Tätigkeiten entlastet werden
Gerade die Corona-Pandemie hat deutlich gemacht, dass der Pflegeberuf ein sinnstiftender und zugleich auch ein krisenfester Beruf mit vielen Entwicklungsmöglichkeiten ist Pflege am Klinikum Nürnberg hat nicht nur zu Pandemiezeiten hervorragende Arbeit geleistet, sondern nachweislich schon satte 125 Jahre Darauf sowie auf die hohe Pflegequalität und -kompetenz am Klinikum können wir stolz sein


Ärzteschaft und Pflege arbeiten am Klinikum Nürnberg Hand in Hand
Die kooperative Klinikleitung bewährt sich seit vielen Jahren Auf über 100 Stationen versorgen 2500
Pflegende rund um die Uhr Patientinnen und Patienten Pflegerisch geleitet werden die Kliniken und Stationen von aktuell 13 Führungskräften aus der Pflege
Jutta Ballwieser


Pflegedienstleitung Klinikum Nürnberg Süd, PDL-Bereich 1
Nadine Heym
Pflegerische Koordinatorin Klinikum Nürnberg Süd
Hanspeter Ender
Pflegedienstleitung Klinikum Nürnberg Nord, PDL-Bereich 4a
Sven Keitel

Pflegedienstleitung Klinikum Nürnberg Nord, PDL-Bereich 7
Julian Gruner



Pflegedienstleitung Klinikum Nürnberg Süd, PDL-Bereich 9
Meike Kettler
Pflegedienstleitung Klinikum Nürnberg Nord, PDL-Bereich 5
Sigrid Löffler





Pflegedienstleitung Zentral-OP
Judith Peltner
Pflegedienstleitung Klinikum Nürnberg Süd, PDL-Bereich 2
Martina Mächtlinger
Pflegedienstleitung
Klinikum Nürnberg Süd, PDL-Bereich 3
Andrea Nätscher

Pflegerische Koordinatorin Klinikum Nürnberg Nord
Tanja Vaheri
Pflegedienstleitung Klinikum Nürnberg Nord, PDL-Bereich 6
Jullia Rögner
Pflegedienstleitung Krankenhäuser Nürnberger Land
Uwe Stadelmeyer
Pflegedienstleitung Klinikum Nürnberg, PDL-Bereich 8

Kaum ein Bereich am Klinikum Nürnberg ist so multikulturell wie die Pflege, und das seit Jahrzehnten Mitarbeitende aus über 150 verschiedenen Ländern arbeiten zusammen mit deutschen Pflegekräften Schulter an Schulter Rund die Hälfte der insgesamt 2500 Pflegekräfte im Haus hat einen Migrationshintergrund – und spiegelt damit auch die multikulturelle Viel-
falt Nürnbergs wider Manche wurden schon in Deutschland geboren, manche kamen vor Jahren aus anderen Ländern ans Klinikum und sind längst „eingebürgert“– andere, wie 16 junge Frauen aus Indien, sind erst ein paar Wochen in Franken und lernen das große Haus und seinen pflegerischen Geist gerade erst kennen Das Miteinander bringt Herausforderungen mit sich – es ist aber auch ein Gewinn

Erst seit 2019 werden Pflegefachkräfte aus anderen Ländern für die Pflege am Klinikum Nürnberg gezielt angeworben Nicht nur der Mangel an Fachkräften hat diesen Schritt notwendig gemacht Ab 2025 werden zahlreiche Pflegekräfte aus der Generation der sogenannten „Babyboomer“ in Rente gehen Allein mit Qualifizierungsmaßnahmen und dem Nachwuchs aus dem eigenen Haus wird die Lücke nicht zu füllen sein
Dabei ist das Klinikum bemüht, Fachkräfte nur aus Staaten zu holen, die keinen Mangel an qualifiziertem Pflegepersonal haben wie z B Indien Rund 50 Pflegemitarbeitende, alle bestens ausgebildet, zum Teil sogar mit Hochschulabschluss, sind seit 2020 aus diesem Land ans Klinikum Nürnberg gekommen Ein weiterer Teil der bisher

150 angeworbenen ausländischen Pflegekräfte stammt aus Serbien, Albanien, NordMazedonien und den Philippinen Ende 2022 erwartet das Klinikum die ersten Mitarbeitenden aus Brasilien In den kommenden Jahren sollen rund 100 aus anderen Ländern jährlich dazu stoßen
Die ausländischen Pflegefachkräfte und Pflegefachhelfer*innen werden vom International Department von Beginn betreut und begleitet Von der Vermittlung von Wohnraum über behördliche Formalitäten bis hin zu Gesundheitsthemen und das Angebot von Deutschkursen kümmert sich das Team um die Neuen
Seit 2020 sind 150 Mitarbeitende aus anderen Ländern und Kulturkreisen ans Klinikum gekommen
Vor allem die Sprache ist ein wichtiges Thema: Gute Deutschkenntnisse sind die Brücke zu den Patientinnen und Patienten, aber auch zu den Kolleginnen und Kollegen auf den Stationen und deshalb im Alltag von essenzieller Bedeutung Zwar ist das bestandene B2-Sprachniveau zwingend Voraussetzung, damit ausländische Pflegefachkräfte das Auswahlverfahren bestehen und am Klinikum Nürnberg arbeiten können Doch die Praxis des Klinikalltags erfordert von ihnen dann noch deutlich mehr und bessere Deutschkenntnisse
Bei der Zusammensetzung unserer Pflegeteams achten wir auf eine gute Mischung aus erfahrenen, langjährigen Fachkräften und jungen, frisch ausgebildeten Mitarbeiterinnen und Mitarbeitern.
Pflegedienstleitungen und Stationsleitungen der Kliniken nehmen die Neuen deshalb von Beginn eng an die Hand Gelernt wird im Tandem mit einem langjährigen Kollegen oder Kollegin und nach einem festen Ausbildungsplan Dabei geht es nicht nur um die fachliche Pflege – diese wird in den Herkunftsländern oft gar nicht so unterschiedlich praktiziert Vielmehr gehört es in
vielen Kulturen zum Selbstverständnis, dass Angehörige beispielsweise die Grundpflege übernehmen Diese ist deshalb nicht Teil der dortigen Ausbildung – und muss den Neuen am Klinikum erst vermittelt werden Das erfordert Geduld und Verständnis auf beiden Seiten
Café International, gemeinsame Kochabende mit internationalen Gerichten, Stationsfeiern, Stadtführungen: Bevor die Pandemie das soziale Leben beschnitt, gab es am Klinikum einen vielfältigen Austausch der Kulturen, der im Kleinen oft mehr Verständnis füreinander schuf, als geplante Integrationsmaßnahmen
Fachlich sind für die Verantwortlichen in der Pflege die unterschiedlichen kulturellen Hintergründe ihrer Mitarbeitenden längst ein wichtiger Pfeiler, um die aus verschiedensten Ländern stammenden Patientinnen und Patienten kultursensibel zu pflegen Und wenn es nur darum geht, ihnen während des Aufenthaltes am Klinikum Nürnberg in der Landessprache Orientierung zu geben oder einen kleinen Wunsch zu erfüllen
Isabel Krieger
Nach Deutschland bin ich schon 1996 der Liebe wegen gekommen 2009 habe ich am cfp die Krankenpflegerausbildung gemacht Seit acht Jahren arbeite ich auf meiner Station 22/4 – und fühle mich sehr wohl

„Deutsche Sprache, schwere Sprache - aber ich lerne jeden Tag ein bisschen mehr – auch fränkisch! In meiner Abteilung kann ich immer Kollegen fragen, wenn ich etwas nicht verstehe – das hilft sehr“

„Alle hatten Geduld mit mir, obwohl meine Deutschkenntnisse, als ich Anfang 2020 aus Albanien ans Klinikum kam, noch nicht sehr gut waren Doch das Team hat mich toll unterstützt Mir gefällt es hier!“


„Ich bin seit Herbst 2021 am Klinikum und wurde sehr offen aufgenommen Innerhalb kurzer Zeit konnte ich schon sehr viel lernen Jetzt unterstütze ich die neuen Mitarbeiterinnen aus Indien, die hierher kommen “
„Ich war auf der Suche nach einem schönen Ort in Europa zum Arbeiten –und da habe ich Nürnberg entdeckt und es hat mir gefallen So viel Mittelalter! Über eine Agentur bin ich dann ans Klinikum gekommen und finde es ziemlich cool hier “
„Ich habe das Klinikum Nürnberg im Internet entdeckt, da stand, dass es ein guter Platz zum Arbeiten ist Also habe ich mich beworben – und nun bin ich seit Frühjahr 2021 hier und habe es nicht bereut “

Es ist nicht nur eines der größten Krankenhäuser Deutschlands, das Klinikum Nürnberg blickt im Bereich Bildung und Wissenschaft auch auf eine ungewöhnlich innovative und unternehmerische Geschichte zurück – als Bildungsträger, Forschungsstätte und inzwischen auch als universitäres Haus Jahr für Jahr bereitet das Klinikum Nürnberg in seinen Bildungsinstitutionen über 1000 Auszubildende und Studierende auf ihren künftigen Beruf im Gesundheitswesen vor Die große Mehrheit von ihnen wird später im Klinikum selbst, in den Krankenhäusern in Lauf und Altdorf im Nürnberger Land oder in anderen Häusern in der Metropolregion Nürnberg bzw im gesamten Freistaat tätig Damit leistet das Klinikum einen wichtigen Beitrag der Nachwuchssicherung in Bayern – weit über den eigenen Bedarf hinaus
Mehr noch: Der Bereich Bildung und Wissenschaft leistet rund um die Ausbildung der Gesundheitsberufe auch eine weithin beachtete Pionierarbeit In Projekten der interprofessionellen Lehre werden künftige Ärztinnen und Ärzte wie Pflegende schon frühzeitig in gemeinsamen Lehrveranstaltungen unterrichtet, um später von Anfang an gut zusammenarbeiten zu können

interprofessionellen Lehre
Rund 50 Berufsgruppen sind im Klinikum tätig, allein 30 davon in der direkten Patientenversorgung Sie alle gilt es nur nicht für die eigene Profession bestmöglich aus- und weiterzubilden, sondern auch für die spätere Arbeit im Team
In diesem Sinne fordern Sachverständigenräte, Fachgesellschaften und Berufsverbände seit Langem das gemeinsame Lernen bereits in der Ausbildung International vielfach etabliert sind inzwischen auch in Deutschland erste interprofessionelle Lehrangebote entstanden Sie konzentrieren sich meist auf Einzelthemen, finden oft singulär und am Ende der Ausbildung statt und sind kaum Bestandteil mehrjähriger interprofessioneller Curricula – vermutlich wegen der anspruchsvollen inhaltlichen und logistischen Herausforderungen, aber auch mangels systematischer institutioneller Vernetzungen

Genau hier setzt das Nürnberger Projekt an, das seit 2016 das bundesweit erste interprofessionelle Curriculum in der Ausbildung von Medizin und Pflege umsetzt und wissenschaftlich evaluiert Nach Konsultationen mit nationalen wie internationalen Expert*innen entwickelte die Nürnberger Projektgruppe aus Klinikum, Centrum für Pflegeberufe, PMU Nürnberg und Evangelischer Hochschule ein kompetenzbasiertes interprofessionelles Curriculum mit sechs passenden Themen: Umgang mit Fehlern, Notfallversorgung, Ethik & Werte, Wundmanagement, Fallbesprechungen und das Überbringen schlechter Nachrichten
Über einen Zeitraum von drei Jahren wird es an halb- und ganztägigen Lehrveranstaltungen unterrichtet und umfasst rund 40 Stunden Die Kohorten starten jeweils im 4 Quartal – wenige Wochen nach ihrem Ausbildungsbeginn
Ein solches gemeinsames Curriculum ist bislang bundesweit einmalig Bis 2020 haben es rund 1000 Teilnehmende absolviert, unterrichtet von 50 Lehrenden und zehn Schauspielpatient*innen Seit 2019 mündet es als freiwillige Option für Medizinstudierende und Pflegeschüler im jeweils letzten Ausbildungsjahr in eine vierwöchige Arbeit auf der Nürnberger Interprofessionellen Ausbildungsstation NIPSTA, wo sie weitgehend eigenverantwortlich gemeinsame Patient*innen betreuen – ein Transferprojekt der Chirurgischen Universitätsklinik Heidelberg, gefördert von der Robert Bosch Stiftung
Stephan Kolbcfp: 100 Jahre Erfahrung, Kompetenz und frische Ideen
Das Centrum für Pflegeberufe (cfp) blickt auf die Erfahrung und Kompetenz von über 100 Jahren zurück und gehört zu den größten Pflegeschulen in Deutschland In derzeit 17 Klassen werden rund 450 Schülerinnen und Schüler in der dreijährigen generalistischen Ausbildung zur Pflegefachfrau/zum Pflegefachmann und in der einjährigen Ausbildung zur Pflegefachhelferin/zum Pflegefachhelfer ausgebildet Noch bis 2023 gibt es die auslaufenden Klassen in der Gesundheits- und Krankenpflege und der Kinderkrankenpflege Auch die Anpassungskurse zur Anerkennung ausländischer Berufsabschlüsse in der Pflege finden am cfp statt
Das cfp-Team besteht aus knapp 50 Personen Darunter befinden sich überwiegend Lehrkräfte, eine Koordinatorin für die praktische generalistische Ausbildung, eine Schulsozialpädagogin, zwei Kolleginnen im Sekretariat und die Schulleitungen Darüber hinaus unterrichten etwa weitere 50 Dozenten und Dozentinnen am cfp
Träger der Schule ist mit dem Klinikum Nürnberg das größte kommunale Klinikum Bayerns und gleichzeitig eines der größten Krankenhäuser in ganz Deutschland Es ermöglicht den Auszubildenden interessante Praxisphasen und eröffnet vielfältige Zugangsmöglichkeiten in spätere Berufsfelder Wenngleich das Klinikum Nürnberg einen Großteil an Einsatzmöglichkeiten für die Schülerinnen und Schüler ermöglicht, so mussten im Zuge der Einführung der generalistischen Ausbildung nahezu 100 Kooperationen geschlossen werden Ziel der Generalistik ist es, Menschen aller Altersgruppen in allen Versorgungsbereichen zu pflegen Das bedeutet auch, dass während der Ausbildung praktische Erfahrungen in Pflegeheimen sowie der häuslichen Versorgung gesammelt werden

Die Vielfalt der Ausbildung zeigt sich nicht nur in den unterschiedlichen Einsatzmöglichkeiten, sondern auch daran, dass im cfp Menschen aus rund 45 Nationen zusammenarbeiten und lernen Das Selbstverständnis im cfp ist von Toleranz geprägt und somit war es ganz selbstverständlich, dass die Schule seit 2019 der internationalen Bewegung „Schule ohne Rassismus – Schule mit Courage“ angehört Das Centrum für Pflegeberufe möchte sich dadurch gegen Diskriminierung jeglicher Art positionieren, zumal die am cfp ausgebildeten Personen in einem Beruf arbeiten werden, in dem es keine Diskriminierung aufgrund der Religion, der sozialen Herkunft, des Geschlechts, der körperlichen Merkmale oder der sexuellen Orientierung geben darf
Wer allerdings glaubt, dass am cfp nur gepaukt wird, der liegt falsch Über mehrere Jahre stellte die Schule eine Fußballmannschaft und eine Volleyballmannschaft beim
„Pokal des Vorstands“, dem heutigen „Klinikums-Cup“ Einen großen Beitrag zur Schulkultur leisten zudem die Theatergruppe und die cfp-Schülerband Neben Schülerinnen und Schülern vom cfp beteiligen sich hier seit mehreren Jahren Studierende der PMU, ehemalige Azubis und Lehrpersonen
Auch das legendäre Sommerfest oder der Glühweinabend, die maßgeblich von der Schülervertretung vom cfp, den Vertrauenslehrerinnen und -lehrern sowie der Studierendenvertretung der Paracelsus Universität organisiert werden (die Medizinstudierenden verbringen ihr erstes Studienjahr in Räumen des cfp), haben sich zu einem festen Bestandteil etabliert Ganz nach dem Motto „gemeinsam lernen und gemeinsam feiern“ – denn es gibt auch ein interprofessionelles Curriculum, im Rahmen dessen beide Berufsgruppen für bestimmte Themen zusammen ausgebildet werden
Dr Julia SimonDas Klinikum Nürnberg ist
seit 1920 Träger einer der größten Krankenpflegeschulen Deutschlands
seit 1969 ein überregionales Fort- und Weiterbildungszentrum
seit 2014 Standort der Paracelsus Medizinischen Privatuniversität
seit 2021 Gründungspartner der Nürnberg School of Health mit der TH Nürnberg

„Es gibt nur eins, was auf Dauer teurer ist als Bildung: keine Bildung!“ Den Leitspruch des früheren US-Präsidenten John F Kennedy hat sich auch das Klinikum Nürnberg angesichts ständiger Weiterentwicklungen und Innovationen im Gesundheitswesen und den einzelnen Gesundheitsberufen zu eigen gemacht Schließlich kommen in der Patientenversorgung Wissen und Erfahrung eine immer wichtigere Rolle zu


In diesem Sinne startete 1969, dem Jahr der ersten Mondlandung, der erste, damals noch einjährige Lehrgang für Intensivpflege und Anästhesie Das markiert den Beginn der dauerhaft etablierten Fort- und Weiterbildungen
Die neu erarbeiteten Richtlinien der Deutschen Gesellschaft für Anästhesie und Wiederbelebung dienten als Maßstab, um für die damaligen Städtischen Krankenanstalten Nürnberg das Pflegepersonal speziell zu qualifizieren Neben dem Universitätsklinikum Mainz ist Nürnberg 1969 einer der ersten Standorte in Deutschland für diese wegweisende Qualifizierung Über ein halbes Jahrhundert später haben sie nicht nur rund 1200 Kolleginnen und Kollegen des Klinikums absolviert, sondern auch viele Pflegende aus den zehn Verbundkrankenhäuser aus Nordbayern, mit denen das Klinikum Nürnberg nicht nur für diese Qualifikation eng zusammenarbeitet
Seit dem Beginn der ersten Weiterbildung für Intensivpflege und Anästhesie sind im Laufe der Jahrzehnte insgesamt zehn meist mehrjährige Weiterbildungen hinzugekommen, ob zur psychiatrischen Pflege, den Funktionsbereichen, Stationsleitungen oder – ganz aktuell – zur Notfallpflege
1969 ist damit auch das Geburtsjahr des hauseigenen Bildungsinstituts Was als Institut für Fort- und Weiterbildung, kurz IFW, begann, mündete rund 30 Jahre später ins „Centrum für Kommunikation - Information - Bildung“, das mit seinem Kürzel „cekib“ ab 2001 weit über die Grenzen der Metropolregion hinaus als Bildungsmarke im Gesundheitswesen bekannt wurde – vor allem wegen seiner Fernlehrgänge
Mit der Initiative für den ersten Fernlehrgang „Betriebswirtschaftslehre im Krankenhaus“ in Kooperation mit Prof Oliver Schöffski vom FAU-Lehrstuhl für Gesundheitsmanagement bietet das cekib eine zum damaligen Zeitpunkt noch wenig verbreitete Lernform, die das flexible Selbststudium mit dem üblichen Präsenzlernen verbindet Angesichts nur weniger Präsenztage lockt das Fernlernen im cekib bald auch Teilnehmende aus ganz Deutschland, Österreich und der Schweiz nach Nürnberg Die Fernlehrgangspalette erweitert sich rasch und Themen wie „Pain Nurse“ oder „Ethik-Berater“ laufen erfolgreich bis zum heutigen Tag – ein Geschäftsfeld, das auch den wirtschaftlichen Erfolg des cekib begründet
2012 schlägt das Klinikum mit dem cekib ein weiteres strategisches Kapitel auf Mit der ersten Ausbildung der sogenannten „OTA“, der operationstechnischen Assistenz, nimmt das cekib auch die medizinischen Assistenzberufe in den Blick Schon wenige Jahre später folgt die Ausbildung der anästhesietechnischen Assistenz (ATA) sowie die Betreuung der Medizinischen Fachangestellten (MFA) Und ab 2022 kommt mit dem Leitungswechsel in der MTRASchule auch die Ausbildung der medizintechnischen Radiologieassistenz (MTRA) ins cekib Damit ist der für die tägliche Patientenversorgung so wichtige Bereich der medizinischen Assistenzberufe inhaltlich, organisatorisch und räumlich sinnvoll gebündelt
Jitka Schwandt

Ihre Zukunft sieht gut aus: Medizinischtechnische Radiologieassistent*innen werden am Arbeitsmarkt gebraucht Und damit auch am Klinikum Nürnberg: Ob in der Diagnostischen Radiologie, in der Strahlentherapie, in der Nuklearmedizin oder in der Strahlenphysik: Überall sind diese unverzichtbar

Ende der 1980er-Jahre wurde die MTRASchule unter Federführung von Prof Dr Theodor Schmidt, Leiter des Instituts für Medizinische Physik, am Klinikum Nürnberg gegründet Damit reagierte das Klinikum auf den eklatanten Fachkräftemangel in diesem Bereich und begann, seine Mitarbeitenden selbst auszubilden
Der Schulbetrieb wurde 1991 aufgenommen Mit großem Erfolg: Für den ersten Ausbildungsjahrgang bewarben sich 50 Schülerinnen und Schüler, von denen 22 ausgewählt wurden Der Unterricht startete mit nur einem Klassenzimmer Heute stehen für die Hauptfächer Röntgendiagnostik, Strahlentherapie und Nuklearmedizin eigene Übungsräume zur Verfügung Eine großzügige Spende ermöglichte die Einrichtung eines Lehrkubus für Strahlentherapie Er ist mit einem voll funktionsfähigen Linearbeschleuniger ausgestattet – natürlich ohne Strahlung An ihm können die angehenden Fachleute praktisch üben
Die seit 1994 von zwei auf drei Jahre erweiterte Ausbildung an der MTRA-Schule ist heute anspruchsvoller und abwechslungsreicher denn je Sie vermittelt fundierte technische und medizinische Kenntnisse und gibt breite Einblicke in ein sich stetig erweiterndes Berufsbild 2019 wurde die bis dahin rein schulische Ausbildung auf eine betrieblich-schulische Ausbildung umgestellt, um die Anforderungen aus der Praxis noch besser zu berücksichtigen
In den theoretischen Fächern besteht seit vielen Jahren eine enge Zusammenarbeit mit der Beruflichen Schule 8 in Nürnberg, an der auch die Berufsfachschule für medizinisch-technische Labor-Assistenten angegliedert ist Lehrkräfte übernehmen Unterrichtsfächer an der MTRA-Schule und unterstützen die Auszubildenden sehr tatkräftig Der Großteil der nebenberuflichen Lehrkräfte sind Mitarbeiter*innen des Klinikums Nürnberg wie Ärzte, Physiker, MTRA, die ihr Wissen aus dem Klinikalltag mit Begeisterung an die Auszubildenden weitergeben und somit eine aktuelle Wissensvermittlung auf sehr hohem Niveau gewährleisten
Als OTA und ATA mittendrin Unsere Operationstechnischen Assistent*innen (OTA) und Anästhesietechnischen Assistent*innen (ATA) sind im Klinikalltag unverzichtbar Die OTA/ATA-Ausbildung am Klinikum Nürnberg vermittelt fachliche, methodische, soziale und persönliche Kompetenzen für
Bis heute haben an der MTRA-Schule rund 540 Schülerinnen und Schüler erfolgreich ihre Berufsausbildung abgeschlossen Von jedem Jahrgang bleiben einige Auszubildende dem Klinikum Nürnberg treu Ein Großteil der MTRA im Haus hat die Ausbildung an der MTRA-Schule erhalten


Schulleitung und Lehrkräfte der MTRASchule freuen sich darauf, auch in den kommenden Jahren junge Menschen auf diesen technisch und medizinisch anspruchsvollen Beruf vorzubereiten Das Berufsbild der MTRA wird sich in den nächsten Jahren grundlegend ändern und noch einmal deutlich aufgewertet: Aus medizinisch-technischen Radiologie-Assistent*innen werden medizinische Technologinnen und Technologen der Radiologie, die aus dem Assistenzbereich herausgenommen werden und deutlich mehr Verantwortung übertragen bekommen, für die sie mittels Kompetenzfeldern qualifiziert werden Was bleibt ist ein sehr vielseitiges Berufsbild, in dem sowohl der Patientenkontakt als auch der Umgang mit hochkomplexen Geräten weiterhin eine große Rolle spielen werden
Anita Scheibingerdie verantwortliche Mitwirkung in verschiedenen operativen Bereichen, der Notaufnahme, der Endoskopieabteilung sowie in der zentralen Aufbereitungseinheit für Medizinprodukte und in anderen diagnostischen und therapeutischen Funktionsbereichen
School of Health: Hochschulexpertise für die Gesundheitsversorgung

Vier Jahre nach der Initiative des Klinikums und einer intensiven gemeinsamen Vorbereitung ist es im Frühjahr 2021 endlich soweit: Das Klinikum Nürnberg und die Technische Hochschule Nürnberg schlagen ein für Nürnberg und Bayern neues Kapitel ihrer langjährigen Zusammenarbeit in Forschung und Lehre auf Der prominent besetzte Gründungsakt unterstreicht die Bedeutung Im Beisein des bayerischen Ministerpräsidenten Dr Markus Söder sowie der Staatsminister für Wissenschaft, Bernd Sibler, und Gesundheit, Bernd Holetschek, fand im März die pandemiebedingt vorwiegend virtuelle Feierstunde zur Gründung der Nürnberg School of Health (SoH) statt
Prof Dr med Achim Jockwig, Vorstandsvorsitzender des Klinikums Nürnberg: „Wir investieren seit Jahren kontinuierlich und erfolgreich in eigene Bildungs- und Studienangebote Die Gründung der „Nürnberg School of Health“ eröffnet aus unserer Sicht exzellente Perspektiven Wir können für das Klinikum und die Metropolregion die dringend benötigten Fachkräfte selbst qualifizieren und nicht zuletzt den Standort Nürnberg attraktiv halten “
In der neuen Organisationseinheit werden Bachelor- und Masterstudiengänge sowie Weiterbildungen für Gesundheitsberufe angeboten und mit angewandter Forschung und Transfer vereint „TH und Klinikum ergänzen sich dabei an der Schnittstelle von Gesundheit, Technologie und Bildung und bieten so die ideale Verbindung von akademischer Ausbildung und Anwendungskompetenz“, so Prof Dr Niels Oberbeck, Präsident der TH Nürnberg
Diese ist mit rund 13 000 Studierenden sowohl eine der größten Hochschulen für angewandte Wissenschaften als auch eine der forschungsaktivsten Hochschulen ihrer Art in Deutschland „Wir kooperieren seit Jahren eng mit dem Klinikum Nürnberg Die „Nürnberg School of Health“ steht für eine moderne, anwendungsnahe Lehre und die Ausbildung interprofessioneller Kompetenz Zudem legen wir großen Wert auf die interdisziplinäre Vernetzung mit anderen fachnahen Studiengängen der TH Nürnberg“, erklärt Prof Dr Niels Oberbeck
Die Angebote der „Nürnberg School of Health“ sind insbesondere von drei Aspekten durchdrungen, die im Gesundheitswesen der Zukunft immer wichtiger werden: die Qualifikation für eine zunehmend digital geprägte Arbeitswelt, die Vermittlung der primären fachlichen Kompetenz wie auch von interprofessionellen Kompetenzen und die ethische Reflexion sowohl des eigenen Handelns wie des Einsatzes neuer Technologien Nicht zuletzt dieser Anspruch verbindet die beiden Nürnberger Kooperationspartner
Die ersten beiden Studiengänge „Hebammenwissenschaft“ und „Digitales Gesundheitsmanagement“ sind zum Wintersemester 2021/2022 gestartet
Dr Stephan KolbGroße Pläne: Der neue „Gesundheitscampus Nürnberg“

Die Vision ist klar und konkretisiert sich immer mehr: Der neue Gesundheitscampus Nürnberg soll regionales Netzwerk als auch geografischer Ort sein In der Nähe des Klinikums bündelt er im Norden Nürnbergs Bildungsinstitutionen für Gesundheitsberufe mit Forschungslaboren und einem Gründerzentrum Damit wird der Gesundheitscampus Nürnberg zum Magneten für die dringende Nachwuchsgewinnung und zur Keimzelle von Forschung, Entwicklung und Technologietransfer in der Gesundheitsbranche
Ab 2030 können hier die Studierenden der Nürnberg School of Health sowie der Paracelsus Universität und die Auszubildenden der Berufsschulen des Klinikums für ihre Arbeit im Gesundheitswesen ausgebildet werden Alles unter einem Dach – wie es der Wissenschaftsrat bereits 2012 empfohlen hat Damit entwickelt der Gesundheitscampus Nürnberg starke Anziehungskraft für Branche und Stadt
Kommunikation als Spiegel
Aktiv zu kommunizieren, ist heute wichtiger denn je Das Bedürfnis nach Einordnung von Fragen der Gesundheit und der Wunsch, sich schnell darüber zu informieren, haben deutlich zugenommen Die Gesundheit hat einen stärkeren gesellschaftlichen Fokus Die Pandemie hat zusätzlich als Verstärker gewirkt Das hat die Kommunikation des Klinikums Nürnberg deutlich verändert und stellt sie vor neue Herausforderungen
„Nur eines ist sicher - und das ist der Wandel“ heißt es Dies trifft auf Krankenhäuser wie das Klinikum Nürnberg umso mehr zu, als sich die Herausforderungen für kommunale Häuser in den vergangenen Jahren deutlich verändert haben
Auch Kommunikation und Personalgewinnung müssen sich an diese neuen Gegebenheiten anpassen Ein Prozess, der am Klinikum Nürnberg begonnen hat
Ging es früher darum, in einer klassischen Pressemitteilung z B einen neuen Chefarzt oder eine neue OPMethode vorzustellen, ist Unternehmenskommunikation heute sehr viel mehrschichtiger
Analoge wie auch Online- und SocialMedia-Kanäle wie ein hauseigener Blog, Twitter und Facebook werden von der Stabsabteilung Unternehmenskommunikation des Klinikums Nürnberg kontinuierlich mit Nachrichten versorgt Doch nicht nur Medizin, Pflege, Forschung und Lehre werden hier thematisiert, sondern auch Zwischenmenschliches

Mitarbeitende und Patient*innen sind wichtige Mittler und Partner, wenn es darum geht, Informationen verlässlich und glaubwürdig anhand persönlicher Erfahrungen und Lebensgeschichten intern wie extern zu transportieren und verständlich zu machen
Während der Corona-Pandemie war das Klinikum Nürnberg nicht nur ein wichtiger Interviewpartner für zahlreiche Medien, es gab auch Orientierung beim Umgang mit der Infektionskrankheit, etwa durch eine eigene Video-Impfkampagne Für diese schilderten Mitarbeitende aus den Corona-Stationen ihre ganz persönlichen Erfahrungen Ein Novum, das die Chancen von Krankenhauskommunikation im Sinne eines sinnvollen Beitrages zu Public Health deutlich macht
In diesem Jahr feiert das Klinikum Nürnberg seinen 125 Geburtstag Seit seiner Gründung 1897 als Städtisches Krankenhaus ist es eine Gesundheitsmarke, nicht nur in der Hochleistungsmedizin Auch im Ausbildungs- und Wissenschaftsbereich hat das Klinikum Nürnberg einen starken Namen
Die Eigen- wie Außenwahrnehmung soll in den kommenden Jahren noch klarer definiert werden Dazu wurde ein Markenprozess begonnen, dessen Ziel es ist, die Identität des in den vergangenen Jahrzehnten stark gewachsenen Unternehmens zu schärfen Während mehrerer Workshops mit Teams aus verschiedenen Bereichen und Abteilungen trugen die Teilnehmer*innen Besonderheiten zusammen, die das Klinikum Nürnberg auszeichnen
Daraus wurden als Basis für das gemeinsame Wirken und Miteinander der über 7000 Kolleginnen und Kollegen drei zentrale Werte abgeleitet, die das Klinikum Nürnberg im Heute charakterisieren Die grafische Neuausrichtung des Klinikums Nürnberg, die neben einem neuen Logo u a auch einen serviceorientierten Webauftritt beinhaltet, wird dafür der erste sichtbare Baustein sein
Ziel ist es, die etablierte Gesundheitsmarke in den kommenden Jahren entlang dieser Werte noch deutlicher auszurichten und transparenter als bisher zu betonen, was das Klinikum Nürnberg ausmacht
Barbara LayPersonalführung sowie Förderung der Beschäftigten Das setzt eine entsprechende Unternehmenskultur voraus Nur so wird es auch in Zukunft möglich sein, ausreichend qualifiziertes und motiviertes Fachpersonal zur Erfüllung des Versorgungsauftrages eines Maximalversorgers zu generieren
Personalmanagement ist jedoch nicht als ausschließliche Aufgabe der Unternehmensleitung und der Personalabteilung zu sehen, sondern wird von allen Führungskräften getragen, jeden Tag in den jeweiligen organisatorischen Bereichen gelebt, aktiv mitgestaltet und kommuniziert
Der in der öffentlichen Diskussion häufig zitierte Fachkräftemangel und dessen Auswirkungen auf die Krankenhäuser sind auch am Klinikum Nürnberg als einem der größten Arbeitgeber in der Metropolregion, nicht erst seit der Pandemie, deutlich spürbar

Dies erfordert mehr denn je die Positionierung des Klinikums als attraktiver Arbeitgeber, nicht nur im Sinne der Personalgewinnung, sondern auch im Sinne der Bindung der Beschäftigten Umso wichtiger ist das Bewusstsein, worin die Rolle einer zeitgemäß operierenden Personalabteilung liegt
Grundpfeiler eines modernen Personalmanagements ist eine strategische und nachhaltige Planung, welche sich durch den Mut und den Willen zur Veränderung auszeichnet Eine reine „Verwaltung“ des vorhandenen Personals wird den aktuellen Herausforderungen des Arbeitsmarkts im Gesundheitswesen schon lange nicht mehr gerecht Das Personalmanagement der Gegenwart und Zukunft sieht seine Aufgaben daher verstärkt in der Personalplanung,
Ergänzend zu der Unterstützung von Führungskräften aller Kliniken und Verwaltungsabteilungen in operativen Angelegenheiten, werden diese daher durch das Personalmanagement in ein möglichst vernetztes Angebot eingebunden und zu „Botschaftern“ der Personalstrategien gemacht Diese ganzheitliche Herangehensweise ermöglicht es auch, die Wechselwirkungen zwischen ihnen und den Beschäftigten auszutarieren und in eine gemeinsame Richtung zu lenken

Daneben zeigt sich, dass sich die Werte und situativen Lebensbedingungen der jüngeren Nachwuchskräfte häufig maßgeblich von denen der bisherigen Generationen unterscheiden Das spiegelt sich auch in den veränderten Bedürfnissen und Fähigkeiten der Arbeitnehmergenerationen wider
Vor diesem Hintergrund, aber auch mit Blick auf die zunehmende Globalisierung und Digitalisierung, werden zukünftig verstärkt digitale Workflows verwaltungslastige Prozesse ablösen Des Weiteren wird auch im Klinikum Nürnberg die räumliche und zeitliche Entkopplung der Tätigkeit, bspw in Form von Home-Office einen noch höheren Stellenwert einnehmen

Dies hat wesentliche Auswirkungen auf die Arbeitsorganisation und fordert sowohl Mitarbeitende, als auch Arbeitgeber stark Eine Neudefinition von Arbeitsprozessen, neue Kommunikationsformen und eine Veränderung des Führungsverständnisses und der Unternehmenskultur sind notwendig
Das Personalmanagement versteht es als Aufgabe sich zusammen mit der Klinikumsleitung und den Führungskräften diesen Herausforderungen zu stellen, und die Schlüsselthemen anzugehen, von denen wir derzeit glauben, dass sie von Bedeutung sind
Beyhan Calik
Die Schaukel: Kita für das Klinikum Spielen, Toben, Lernen, Kreativsein: 2002 wurde die Kindertagesstätte „Schaukel“ von Beschäftigten des Klinikums Nürnberg gegründet und ist heute ein Tochterunternehmen des Klinikums Nürnberg Mit extra langen Öffnungszeiten, keinen Ferienschließzeiten und einem altersgemischten, teiloffenen pädagogischen Konzept bietet die Einrichtung mit Standorten am Klinikum Nürnberg Nord und am Klinikum Nürnberg Süd Mitarbeitenden Unterstützung bei der Vereinbarkeit von Familie und Beruf Im Jubiläumsjahr wird die Kita am Klinikum Nürnberg Süd neu gebaut Sie wird nicht nur schöner, sondern mit fünf zusätzlichen Kindergartenplätzen auch etwas größer als die bisherige, die Platz macht für den Neubau des Kinderklinikums Nürnberg

125 Jahre Klinikum Nürnberg | 1897 - 2022
Bürgerschaftliches Engagement ist für eine Gesellschaft enorm wichtig und trägt entscheidend zu deren Zusammenhalt bei Am Klinikum Nürnberg werden seit dessen Gründung vor 125 Jahren über Spenden, Stiftungen oder Förderungen Vorhaben umgesetzt, durch die die Behandlung und Lebensqualität unserer Patientinnen und Patienten verbessert werden
Das gilt für die medizinische Versorgung und für besondere Projekte, die über die reguläre Krankenhausfinanzierung nicht zu leisten sind Spenden für das Klinikum sind deshalb Investitionen in das Gemeinwohl, ein Plus über die Standardversorgung hinaus, das allen Patient*innen zugute kommt
Eines haben diese Handlungen gemeinsam: Sie stärken die Gesundheit unserer Region, die Menschen unserer Stadt Und das ist nicht nur vorbildlich, sondern auch hilfreich Denn so gestalten viele seit 125 Jahren mit ihrem Engagement die Medizin am Klinikum Nürnberg mit Einige Stifter, Spender und Förderer, die das Klinikum Nürnberg seit Jahren maßgeblich unterstützen, stellen wir auf den nächsten Seiten vor
Treue Stifter und Förderer
Nicht nur Privatpersonen, auch Unternehmen nehmen ihre soziale Verantwortung wahr und unterstützen das Klinikum Nürnberg und seit 2014 auch den Nürnberger Campus der Paracelsus Medizinischen Privatuniversität
Viele unserer zahlreichen Unterstützerinnen und Unterstützer stehen uns bereits seit Jahrzehnten zur Seite und haben stets unseren medizinischen Auftrag zum Wohle unserer Patientinnen und Patienten gestärkt Bei Ihnen allen möchten wir uns herzlich bedanken!

Stellvertretend seien hier für ihr besonders großzügiges Engagement folgende Förderinnen und Förderer genannt:
Marianne Backer, Eheleute Bradl, Dr Elisabeth Birkner, Ilse Kahlert, Judith Ingeborg Klör, Olga Walburga Lämmermann, Familie Maurer, Hildegard Charlotte Müller-Bornemann, Rudi Reber, Familie Helga und Helmut Rösch, Familie Weißenfels, Kerscher’sche Stiftung, Manfred-Roth-Stiftung, Schöller-Stiftung, Staedtler Stiftung, Stamm-Schmitt-Stiftung
Herzlichen Dank auch allen weiteren Privatpersonen, Firmen und Stiftungen, die uns bedacht haben und mit deren Hilfe wir zahlreiche Vorhaben und ein Plus über die Standardversorgung hinaus umsetzen konnten und können Ihre Zuwendungen sind sehr willkommen und hilfreich

Wer die zierliche, schlanke Dr Elisabeth Birkner heute sieht, kann erst einmal verstehen, was „Onkel Fritz“ seiner zarten Nichte einst sehr bestimmt gesagt hatte: „Elisabeth, ein Medizinstudium kommt überhaupt nicht in Frage Die Chirurgie ist körperlich zu schwer für dich!“ Der Onkel wusste, wovon er sprach, Dr Fritz Erler war schließlich selbst Chirurg und hatte in Nürnberg eine eigene Unfallklinik
Schon in der Volksschule wusste ich, dass ich Medizin studieren will.
Aber der Onkel hatte den Willen und die Beharrlichkeit seiner Nichte unterschätzt „Schon in der Volksschule wusste ich, dass ich Medizin studieren will“, erzählt die heute 96 Jahre alte Elisabeth Birkner Als sie 1944 das Abitur in der Tasche hatte, wurden ihre Pläne vom Krieg durchkreuzt: Alle Universitäten wa-
ren geschlossen Weil sie nicht daheim rumsitzen wollte, entschloss sie sich, in der Spital-Apotheke eine Ausbildung zu machen „Ich konnte das pharmazeutische Vorexamen machen, davon habe ich später in Studium und Beruf sehr profitiert“
Nach dem Krieg öffneten die Universitäten wieder, aber die medizinische Fakultät war überfüllt Elisabeth Birkner musste drei Semester warten, bis sie als Tochter einer Kriegswitwe studieren durfte Eine große Herausforderung waren auch die sogenannten Hörgelder, die Studenten damals bezahlen mussten „Wir hatten – wie alle anderen auch - kein Geld nach dem Krieg “ Aber Mutter und Tochter stemmten den finanziellen Kraftakt, nach einem dreimonatigen Krankenpflegedienst am Städtischen Krankenhaus stand die erste Vorlesung an der Universität in Erlangen an Nur eine Handvoll Kommilitoninnen saß mit Elisabeth Birkner im proppenvollen Hörsaal
Großzügige Stifter: Das Dr Hans Birkner-Haus am Klinikum Nürnberg Standort Nord wurde mit Kunst ausgestattet
Dass Frauen in dem Beruf damals alles andere als willkommen waren, musste Birkner immer wieder erleben: „Nicht selten sagte man mir direkt ins Gesicht, dass bei gleicher Qualifikation ein Mann bevorzugt wird “ Aber die junge Elisabeth ließ sich nicht beirren und biss sich durch
Im Klinikum lernte die Studentin auf der chirurgischen Station den Assistenzarzt Hans Birkner kennen –ihre große Liebe Beide bauten sich eine Existenz auf Elisabeth begann 1951 an der städtischen Frauenklinik ihre Facharztausbildung und ließ sich später als Gynäkologin mit eigener Praxis nieder Ihr Mann machte Karriere in der Chirurgie am „Städtischen“, er wurde Erster Oberarzt, Chefarzt und schließlich Ärztlicher Direktor – 40 Jahre lang wirkte Dr Hans Birkner am Klinikum
Elisabeth Birkner erinnert sich gerne: An die Zwei-Zimmerwohnung auf dem Klinikumsgelände, in die das Ehepaar zog, weil der Mann als erster Oberarzt in der Chirurgie sein musste Oder an die kleine Tür in der Mauer des Krankenhauses, für die die Birkners einen Schlüssel bekamen, als sie später in ein Haus in unmittelbarer Nähe zogen „So konnte mein Mann auch nachts schnell in der Klinik sein Die Tür gibt es noch Heute nutzen sie die PMU-Studenten, wenn sie zum Hörsaal wollen “
Und sie erinnert sich lachend an Einladungen, bei denen ihre Gäste vor verschlossener Tür standen „Es kam gar nicht so selten vor, dass ich abends zu einer Geburt gerufen wurde und mein Mann zeitgleich zu einer OP “ Die Gäste nahmen es gelassen und warteten, bis einer von beiden wieder nach Hause kam „Das wurden oft die lustigsten Abende “
 Karin Winkler
Karin Winkler
Die Augen von Elisabeth Birkner funkeln, wenn sie die Jahre Revue passieren lässt „Das Klinikum war unser Leben“, resümiert sie Gemeinsam hatte das Ehepaar Birkner deshalb beschlossen, eine Stiftung zu gründen, in die ihr Millionen-Vermögen fließt Doch noch bevor es dazu kam, starb Hans Birkner 1992 Elisabeth Birkner hielt an den Plänen fest, 1999 wurde die Dr Hans und Dr Elisabeth Birkner Stiftung – eine
der größten Nürnberger Privat-Stiftungen jüngerer Zeit – genehmigt Die Ausschüttungen kommen dem Klinikum zugute Mit dem Geld werden zum Beispiel die wissenschaftlichen Arbeiten von Ärzten der chirurgischen Kliniken belohnt, Mediziner finanziell unterstützt, die ihre Kenntnisse im In- und Ausland vervollkommnen wollen oder neue medizinischen Geräte oder Einrichtungsgegenstände angeschafft
Dr. hc. Theo Schöller
„Friedl, da müssn mer was tun!“ Wenn die Ehefrau von Theo Schöller morgens diesen Satz zu hören bekam, dann wusste sie sofort: Ihr Ehemann hatte in der Zeitung über etwas gelesen, das Patienten in seiner Heimatstadt Nürnberg die Behandlung oder den Aufenthalt im Krankenhaus leichter machen könnte Und ein paar Telefonate später war es oft schon beschlossene Sache
Das persönliche Interesse von Theo Schöller galt der Medizin.
So bekam das Klinikum Nürnberg zum Beispiel einen Nierensteinzertrümmer, einen sogenannten Lithotripter Zu seinem siebzigsten Geburtstag spendierte der Unternehmer eine halbe Million Mark, damit das Gerät angeschafft werden konnte Die Möglichkeit, dass Patienten von schmerzhaften Nie-

rensteinen befreit werden können, ohne dass ein Chirurg zum Skalpell greifen muss, hatte den „Eiskönig“ beeindruckt Und ein paar Jahre später „trommelte“ er kräftig bei Politik und Wirtschaft, damit Nürnberg eine eigene Herzchirurgie bekommt Mit einer Million Mark brachte er selbst den Löwenanteil für die Anschubfinanzierung auf
„Das persönliche Interesse von Theo Schöller galt schon immer der Medizin Besonders für Patientenangebote, die nicht über die Kassenleistung abdeckt werden, hatten er und seine Frau stets ein offenes Ohr“, berichtet Rainer Hattenberger, Vorstand der Schöller-Stiftungen
Die beispiellose Karriere von Theo Schöller hatte ganz klein angefangen Bei einem Besuch in Berlin hatte er sein erstes Eis am Stil gegessen Diese Idee begeisterte den Nürnberger so sehr, dass er in seiner Heimatstadt mit seinem Bruder 1937 in
Die unterirdischen Versorgungsgänge des Dr Theo Schöller-Hauses wurden von einem Graffiti-Künstler gestaltet

die Herstellung von verpacktem Eis am Stil einstieg Mit dem Fahrrad wurden die Schleckereien - in Thermokisten verpackt - anfangs ausgeliefert Nach Kriegsende kam die Herstellung von Tiefkühlkost dazu, 1957 wurde das Produktsortiment noch um Lebkuchen ergänzt Theo Schöller stieg zu einem der ganz großen Unternehmer in der deutschen Lebensmittelindustrie auf
Um die Unternehmensnachfolge zu regeln, gründete Schöller 1988 die gemeinnützige „Theo und Friedl Schöller Stiftung“, eine der größten Unternehmensstiftungen bundesweit Aus den Erträgen des Stiftungsvermögens wollten Schöller und seine Frau gemeinnützige Zwecke vor allem im Bereich der Medizin, aber auch der Bildung und der Kultur fördern „Das Hauptengagement galt dabei dem Klinikum Nürnberg“, erläutert Rainer Hattenberger Als der damalige Vorstand Klaus
Wambach Anfang der 2000er Jahre mit der Idee eines Zentrums für Altersmedizin auf das Ehepaar Schöller zukam, waren beide sofort mit im Boot und sicherten eine dauerhafte Unterstützung zu
Sie verfolgten bereits interessiert die Planungen für den Neubau, der später den Namen „Dr hc Theo Schöller-Haus“ bekam Durch die Förderung aus der Schöller-Stiftung wurde es zum Beispiel möglich, die Patientenzimmer mit einer besonderen Betonkühlung auszustatten, die durch Kaltwasserleitungen im Mauerwerk gerade im Sommer für ein angenehmes Raumklima sorgt Doch weite Teile der späteren Realisierung und die Einweihung des Neubaus erlebte Theo Schöller nicht mehr, er starb 2004, wenige Tage nach seinem 87 Geburtstag
Karin WinklerFür Friedl Schöller war es keine Frage, das Lebenswerk ihres Mannes fortzuführen Sie übernahm den Vorsitz der Schöller-Stiftungen und rief zusätzlich die Schöller Azubi-Akademie ins Leben, mit der junge Leute auf ihrem Karriereweg unterstützt werden Beim alljährlichen Schöller-Symposium stellen Expertinnen und Experten aktuelle wissenschaftliche Erkenntnisse darüber vor, wie gesundes und zufriedenes Altern
gelingen kann Abgerundet wird es durch die Verleihung des Theo und Friedl Schöller- Preises, dem mit insgesamt 20 000 Euro höchst dotierten Preis, der in Deutschland auf dem Gebiet der Altersforschung vergeben wird
Bei guter Gesundheit erlebte Friedl Schöller noch die Einweihung des Dr hc Theo Schöller Hauses 2014 starb Friedl Schöller


Die Paracelsus Medizinische Privatuniversität Nürnberg (PMU) ist auf einem erfolgreichen Weg Möglich machen dies auch großzügige Kooperationspartner und Förderer
Die Stiftung am Klinikum Nürnberg Stets das Wohl des Klinikums im Blick, die optimale Versorgung der Patientinnen und Patienten über den Standard hinaus, dies waren persönliche Anliegen von Vorstand Klaus Wambach Mit der Gründung der Stiftung Klinikum Nürnberg ist es ihm gelungen, dies über seinen Tod hinaus zu realisieren
Rudi Reber zum Beispiel Dank einer Vermittlung durch den Nürnberger Immobilienunternehmer Richard Minartz unterstützte der 1925 in Erkersreuth bei Selb geborene Oberfranke in Erinnerung an seinen verstorbenen Sohn die PMU Nürnberg und über die Dr Hans und Dr Elisabeth Birkner-Stiftung auch das Klinikum Nürnberg in den Jahren 2019 und 2020 mit über einer Million Euro
„Sie stiften uns nicht nur die finanziellen Mittel – Sie schenken uns Ihr Vertrauen und Ihren Glauben daran, dass wir mit unserer Uni und der patientennahen Forschung am Klinikum Nürnberg auf dem richtigen Weg sind “ bedankte sich Prof Dr Achim Jockwig, Vorstandsvorsitzender des Klinikums Nürnberg Im März 2022 starb Rudi Reber
Die Stiftung unterstützt und ermöglicht Vorhaben, die durch die übliche Krankenhausfinanzierung nicht möglich wären, nämlich zusätzliche Infrastruktur und Ausstattung Mit diesen und solchen Beiträgen erfährt das Klinikum Nürnberg starken Beistand in seinem Versorgungsauftrag und täglichen Einsatz
Jährlich werden hierzu aus der Stiftung Mittel ausgeschüttet, Anschaffungen getätigt und Projekte umgesetzt
Bauen Sie mit am neuen Kinderklinikum!
Für eine bestmögliche medizinische und pflegerische Versorgung von Babys, Kindern und Jugendlichen: Dafür steht das neue Kinderklinikum mit Geburtshilfe, für das 2022 Spatenstich ist
Neben einer herausragenden Medizin und Pflege soll darin eines verwirklicht werden: eine kindgerechte und familienfreundliche Ausstattung, die sich an den Wünschen der kleinen Patienten orientiert Hierfür sind zusätzliche Finanzmittel nötig
Das Klinikum Nürnberg hat prominente Unterstützer gewinnen können, die die Idee des Kinderklinikums in die Welt tragen Neben Schirmherrin Karin Baumüller-Söder werben der ehemalige bayerische Ministerpräsident Dr Günther Beckstein, der ehemalige Vorstandsvorsitzende der DATEV eG, Dieter Kempf, Radiomoderator Florian Kerschner, Generalmusikdirektorin Joana
Mallwitz, Nürnbergs Alt-OB Dr Ulrich Maly, Ex-Fußballprofi Marek Mintál, Sportmoderatorin Katrin Müller-Hohenstein, das frühere Christkind Benigna Munsi, Unternehmerin Constanze Oschmann, Pianistin Hilde Pohl sowie die Theater Mummpitz und Pfütze als Botschafter*innen für das Projekt
Über weitere Unterstützung für das Kinderklinikum mit Geburtshilfe freut sich das Klinikum Nürnberg Herzlichen Dank! Informationen und Spendenadresse unter: www neubau-kinderklinikum de
Botschafter*innen des neuen Kinderklinikums Nürnberg mit Schirmherrin Karin BaumüllerSöder

Ein offenes Ohr, ein sehendes Auge, eine helfende Hand, eine warme Geste – im Klinikum Nürnberg sind Ehrenamtliche in vielen verschiedenen Bereichen im Einsatz - nahe bei den Menschen, bei Patienten und ihren Angehörigen Sie hören zu, sie sehen hin und sie helfen Und manchmal sind sie einfach auch nur da Warum das wichtig ist, erzählen hier Vier von ihnen Besuchsdienst „Oft wollen die Patienten einfach nur reden“
Als Toni Mang im Jahr 2003 erfuhr, dass am Klinikum ein ehrenamtlicher Besuchsdienst aufgebaut werden soll, fühlte sie sich sofort angesprochen „Mein Mann ist im Nordklinikum in der Onkologie gestorben Bei meinen vielen Besuchen habe ich damals festgestellt, dass es Patienten gibt, zu denen niemand kommt“, berichtet sie Toni Mang meldete sich, und nach einem Einführungsgespräch war sie dabei „Ich wurde auf eine Station in der Pneumologie eingeteilt und dort bin ich auch geblieben“, sagt Mang Jeden Mittwochvormittag ist

sie im Haus 14 unterwegs - genauer gesagt war sie dort unterwegs, denn wegen der Corona-Pandemie musste auch der ehrenamtliche Besuchsdienst seit zwei Jahren pausieren
„Meist möchten die Patienten einfach reden Viele vertrauen einer außenstehenden Person wie mir ihre Ängste und Sorgen an, weil sie ihre Angehörigen nicht damit belasten möchten “ Sie selbst muss manchmal schlucken, wenn sie von den Schicksalen erfährt „Aber mir wird dabei oft klar, wie gut es mir eigentlich geht“ Falls die Gespräche zu nahe gehen, können sich die Ehrenamtlichen aus dem Besuchsdienst auch professionelle Unterstützung holen „Aber bisher konnte ich solche Situationen immer selbst gut verarbeiten Es geht einem noch im Kopf rum, aber mit nach Hause nehme ich es nicht“, sagt Mang
Neben Gesprächen bitten Kranke auch mal um eine Besorgung oder einen gemeinsamen Spaziergang Mang hat einer Patientin auch schon mal in einem Waschsalon die Wäsche gewaschen, weil die Frau für den Krankenhausaufenthalt zu wenig eingepackt hatte Ein Mann hat ihr sogar Bankkarte samt PIN anvertraut, damit sie für ihn Geld abhebt Und zweimal hielt sie Sterbenden die Hand, weil es die Angehörigen nicht rechtzeitig in die Klinik schafften: „Das waren sehr einschneidende Erlebnisse, die ich aber nicht missen möchte“, erklärt Mang
Sobald der Besuchsdienst wieder an der Start gehen kann, wird Toni Mang erneut dabei sein, sich zuerst auf Station melden und fragen, ob es Patienten gibt, die sich einen Besuch wünschen oder einfach von Zimmer zu Zimmer gehen und ihre Unterstützung anbieten „Diese Einsätze geben einem viel zurück Die vielen interessanten Menschen, die ich kennenlerne und die Gespräche mit ihnen sind für mich eine Bereicherung “
Für Demenzkranke bedeutet ein Krankenhausaufenthalt eine Ausnahmesituation
Die fremde Umgebung, die vielen unbekannten Gesichter machen ihnen Angst, sie vermissen ihre vertrauten Menschen und wollen wieder zurück nach Hause – eine Herausforderung auch für die Pflegekräfte Die ehrenamtlichen Demenzbetreuer leisten in einer solchen Situation wertvolle Unterstützung
Was die Diagnose Alzheimer oder Demenz für die Betroffenen und deren Angehörige bedeutet, weiß Eva Ulzheimer genau Sie hat sich jahrelang um ihre Mutter gekümmert, die an Alzheimer erkrankt war Sie las in der Zeitung, dass am Klinikum ehrenamtliche Demenzbegleiter ausgebildet werden sollen „Ich wollte mehr wissen über dieses Thema, das damals noch nicht in aller Munde war Deshalb habe ich mich 2011 zu einer Schulung angemeldet“, erinnert sich Ulzheimer

„Ich bin immer freitags um die Mittagszeit auf einer Station im Südklinikum, wo hauptsächlich Sturzpatienten versorgt werden“, erzählt Eva Ulzheimer Diese Patienten sind nicht immer dement, sondern nach einer Operation eine Zeitlang verwirrt – Delir nennen Fachleute diesen Zustand
Ulzheimer erkundigt sich bei den Pflegekräften, ob es Patienten gibt, bei denen sie mal vorbeischauen sollte Mittags ist die Hilfe besonders gefragt, denn die verwirrten Senioren brauchen zum Essen und Trinken oft eine Ermunterung oder Unterstützung „Das Essen oder auch das Wetter sind außerdem
sehr hilfreiche Themen, um in ein Gespräch zu kommen Darüber weiß jeder was zu sagen “ Ob die Geschichten auch stimmen, die Ulzheimer bei den Plaudereien zu hören bekommt, spielt keine Rolle, Hauptsache die Patienten sprechen Wenn jemand einen Ausflug in den Garten machen oder die Kapelle besuchen möchte, dann ermöglich die erfahrene Demenzbegleiterin dies ebenfalls
Hin und wieder erlebt Ulzheimer auch Ablehnung „Ich nehme es nicht persönlich, wenn Patienten sagen, dass sie mich nicht sehen wollen und ich gehen soll “ Und manchmal bleiben die verwirrten Menschen auch einfach stumm Ulzheimer erinnert sich an eine alte Dame, die trotz aller Bemühungen kein Wort sprach „Als ich mich verabschiedet habe, hat sie mir plötzlich zugewinkt Es war also doch etwas bei ihr angekommen Das sind Momente, die mich glücklich machen “
Patientenvertretung Anlaufstelle für Lob und Ärger
Sie sind unabhängig, wollen bei Problemen und Konflikten vermitteln oder mit Informationen weiterhelfen: Die fünf ehrenamtlichen Patientenvertreter – vier Frauen und ein Mann – bieten sich als Anlaufstelle für Patienten und deren Angehörige an, wenn es in dem großen Krankenhausbetrieb irgendwo knirscht Sie halten regelmäßig Sprechstunden und sind telefonisch erreichbar

Mal ärgert sich jemand übers Essen, mal über unfreundliches Personal oder eine
Verschiebung des Operationstermins „Besonders häufig aber sind Kommunikationsprobleme Patienten oder auch Angehörige fühlen sich zum Beispiel nicht ausreichend darüber informiert, wie die Behandlung abläuft oder wie es zuhause mit der Nachsorge weitergeht“, berichtet Gerlinde Mathes, die seit 2016 als Patientenfürsprecherin aktiv ist
Die Zeit für Gespräche mit den Patienten ist im Klinikalltag knapp bemessen, oft scheitert die Kommunikation aber auch an Sprachbarrieren oder der Tatsache, dass aufgeregte, vielleicht auch betagte Menschen nicht alle Informationen in der Kürze der Zeit aufnehmen können Mathes kann hier häufig schon mit dem Verweis auf die Sprechstunden weiterhelfen, die jeder Arzt auf jeder Station nachmittags abhält „Da ist Zeit, um offene Fragen zu klären“
Als erstes Krankenhaus in Bayern hat das Klinikum Nürnberg 1976 die Patientenvertretung geschaffen, um die Rechte der Patienten zu stärken, mögliche Missstände zu erkennen und Strukturen zu verbessern
„Egal ob in der Pflege oder der Medizin, die Mitarbeitenden hier geben alles, um den Patienten zu helfen Niemand will sie ärgern Aber manchmal stimmt bei einem Konflikt einfach die Chemie zwischen den Beteiligten nicht oder es gibt ein Missverständnis“, sagt
Dann geht die Patientenfürsprecherin auch direkt auf Station und thematisiert das Problem – ohne anklagend zu agieren, denn sie kennt bis dahin nur die Sicht des Patienten Chefärzte oder die Pflegedienstleitung kann Mathes – wenn nötig – dabei jederzeit einbeziehen Miteinander reden hilft „Nicht selten wollen Patienten oder Angehörige nur mal Dampf ablassen Ihnen ist schon geholfen, wenn wir einfach zuhören “
Zuhörer in der Not Manchmal ist das Namensschild von Dorothea Zimpel eine Art Türöffner für den Zugang zu einem ihr völlig unbekannten Menschen Denn wenn Patienten den Zusatz „Ehrenamtliche Klinikseelsorge“ lesen, dann öffnen sie sich oft für ein Gespräch Die Betroffenen sind in einer schwierigen Grenzsituation, sie hatten vielleicht einen Unfall oder wurden mit einer belastenden Diagnose konfrontiert Es verändert sich gerade viel in ihrem Leben und sie fragen sich, was diese neue Situation für sie und auch für ihre Familie bedeutet „Ich spüre bei diesen Menschen häufig eine Sehnsucht nach Spiritualität, nach einem Rahmen, der ihnen Sicherheit gibt Und da komme ich ihnen mit meinem Besuch gerade recht“, erzählt Dorothea Zimpel

Die Patienten sprechen ihr gegenüber manchmal Dinge aus, die sie noch nie ausgesprochen haben „Ich bekomme auch ganze Lebensbeichten zu hören Die Patienten empfinden es als befreiend und erleichternd, Dinge, die sie belasten, bei einem anderen abzuladen“, sagt Zimpel Sie hört zu, wertet und beurteilt nicht, was ihr die Menschen anvertrauen Schweigepflicht ist selbstverständlich Auch wenn die Kirche ihr selbst einen Rahmen für ihr Leben gibt, spielt es für die ehrenamtliche Klinik-
seelsorgerin keine Rolle, ob ihre Gesprächspartner Agnostiker, Muslime, Christen oder Zeugen Jehovas sind „Ich verkaufe nicht Gott Es geht allein um den Menschen und seine Not Wir ticken eh alle gleich Ob jemand ein Gespräch oder ein Gebet möchte, ist jedem selbst überlassen“
Zimpel wurde in einem halbjährlichen Kurs von der ökumenischen Klinikseelsorge ausgebildet Seit 2010 besucht sie einmal in der Woche Patienten auf Stationen im Südklinikum Mit ihren ehrenamtlichen Kolleg*innen ist sie eingebunden in das Team der hauptamtlichen Seelsorger*innen
Karin Winkler
Wer die Schaltzentrale für das Baugeschehen des Klinikums Nord aufsucht, betritt auch baulich-historisches Terrain Im solide sanierten Ambiente von Haus 36, einem Gebäude mit in Sandstein gefassten Fenstern und Etagen mit hohen Decken aus dem späten 19 Jahrhundert, wird die architektonische Zukunft der beiden Standorte des Klinikums geplant und projektiert
Scheinbar ungeordnet stapeln sich großformatige Pläne auf den Schreibtischen, PC-Bildschirme zeigen Tabellen und intensiven Schriftverkehr An den Wänden hängen alte Skizzen der von Hochbauamtschef Heinrich Wallraff (Sebastianspital, Labenwolf Gymnasium Nürnberg) vor 125 Jahren konzipierten städtischen „Krankenanstalten“
Die städtebauliche Struktur und die Gebäude zeugen bis heute vom Zeitgeist deren Entstehung In Reih und Glied standen niedrige Pavillons entlang der Mittelachsen, eine Symmetrie, die gute Durchlüftung und viel Licht versprach Den Krankensälen der Pavillonbauten waren Loggien vorgelagert, die heute allesamt als geschlossene Räume genutzt wurden Seinerzeit waren sie wichtiger
Bestandteil der Genesung, denn im industriellen Zeitalter lebten die meisten Familien in lichtarmen Hinterhöfen, auch in Nürnberg
Nichts störte die strenge Ordnung der Gebäude - kein Wunder, denn damals hatte die Stadt erst 172 000 Einwohner Man konnte sprichwört-
lich auf die grüne Wiese bauen und hatte noch reichlich Platzreserven Parkähnliche Gärten gehörten zur historischen Anlage und auch heute wird den Außenanlagen großer Wert bei der Erholung der Patienten beigemessen
Die Zeiten von Baulandreserven sind aber schon lange vergangen Auf seinen fast 17 Hektar Grund steckt das Klinikum Nürnberg Nord im Jahr 2022 - trotz seines 1994 eröffneten zweiten Standortes im Süden der Stadt - in einem engen städtebaulichen Korsett Sich aus ihm zu befreien, gelingt notgedrungen nur mit der sprichwörtlichen Abrissbirne, die inzwischen modernen Abbruch- und Recyclingmethoden gewichen ist
Für das aktuelle Vorhaben im Klinikum Nord, das geplante Zentrum für seelische Gesundheit, sind drei Objekte aus der alten Zeit gefallen Bereits für das Dr Theo-Schöller-Haus, das 2013 eingeweihte Großprojekt in Achse des historischen Eingangsgebäudes, mussten seinerzeit fünf Altbauten weichen
Die Zeitgeschichte lässt sich auch an der Adresse des Klinikums Nord ablesen, denn die Flurstraße wurde zur Professor-ErnstNathan-Straße umgewidmet Und sie lässt sich auch an der Eingrenzung des Klinikums festmachen: Die ursprüngliche Mauereinfriedung wurde an vielen Punkten geöffnet Der Umgang mit dem Erbe der Epochen ist ein weites Spannungsfeld
Wer in der Projektierung von Bauwerken und den zugehörigen Fachabteilungen des Klinikums arbeitet, fühlt sich unweigerlich wie ein moderner Sisyphos Kaum ist ein Projekt endlich fertig, geht es an anderer Stelle wieder weiter Ein modernes Krankenhaus zu betreiben, bedeutet immer wieder bauen, modernisieren, Strukturen anpassen, perspektivisch-strategisch denken, planen und handeln
Das war schon immer so: Gerade einmal fünf kurze Jahre konnten die Bauherren des 1897 in St Johannis eröffneten „neuen allgemeinen Krankenhauses der Stadt Nürnberg“ durchschnaufen Dann waren die 30 Flachdach-Pavillons mit 760 Betten in riesigen Krankensälen den Anforderungen schon nicht mehr gewachsen Es musste erweitert werden Haus 32 kam 1902 als erstes hinzu, der Startschuss zur unaufhaltsamen Expansion inmitten einer ebenso unaufhaltsam wachsenden Kommune
Jede Ära hat dem Erscheinungsbild des Klinikums Nürnberg Nord ihren eigenen stilistischen Stempel aufgedrückt Im Bombenhagel des Zweiten Weltkriegs wurden 70 Prozent der Gebäude zerstört oder beschädigt und mussten unter widrigsten Bedingungen bis 1959 wiederaufgebaut werden Gleichzeitig wurde das Klinikum stark erweitert
Im selben Jahr fiel auch der Beschluss für den markanten Y-Bau mit seinen drei Flügeln, der den endgültigen Bruch mit der Pavillonstruktur und damit eine neue planerische Ära einläutete
Der Rundgang mit den Bauexperten, die beim Verlassen des Haus 36 noch schnell auf die Kacheln an den Wänden des Altbauflurs hinweisen („Von Villeroy & Boch, 1897, diese Qualität bekommen Sie heute gar nicht mehr“), führt zunächst in die Weimarer Republik, in der 1930 die Frauen- und Kinderklinik entstanden ist








Die Pavillonanlage des Städtischen Krankenhauses nach vollendetem Bau 1897

Architekt des eindrucksvollen Baus in Hellgelb, Beige und Grau war der städtische Oberbaurat Robert Erdmannsdörfer, ein Vertreter des sogenannten Neuen Bauens Im äußeren Erscheinungsbild distanzierte es sich schnörkellos und zweckmäßig von der Formensprache des Jugendstils und des Historismus Einige Räume im Inneren jedoch entsprachen wiederum der späten Formensprache dieser Epoche, wurden aber im Bombenhagel des zweiten Weltkrieges zerstört Der sich in Ost-West-Richtung erstreckende ehemalige 252-Betten-Bau mit horizontalen Simsen und Fensterbändern etablierte die Großform auf dem Klinikareal Er steht unter Denkmalschutz und wird heute von der Klinikverwaltung genutzt
Für Manches braucht es einen zweiten Blick Tritt man nahe an die Fassade heran, dort, wo der dunkel patinierte Betonhochbunker an den Torbogen der ehemaligen Isolierstation der Frauenklinik stößt, erkennt man: Die Front ist unmerklich geschwungen, um das Haus perspektivisch kürzer erscheinen zu lassen Eine planerische Raffinesse, die unmerklich wirkt
Auf der gegenüber liegenden Gebäude- und Stirnseite liegen großzügige Vorhöfe und Treppenanlagen; Steinplastiken zeigen die zwölf Sternzei-
chen und Kinderfiguren, um deren angeblich jüdisches Aussehen in der NS-Zeit ein bizarrer Streit entbrannte Mehr Zierrat, so steht es in den Annalen, sei leider nicht möglich gewesen Das Geld war knapp
Die große Geste der Gegenwart befindet sich gegenüber der ehemaligen Frauen- und Kinderklinik Das Dr Theo-Schöller-Haus steht als wuchtiger Riegel dem klassischen Neorenaissance-Bau an der ProfErnst-Nathan-Straße mit Glockenturm, Kapelle, vertäfeltem Sitzungssaal und Krankenhausmuseum gegenüber Er ähnelt dem Bau des Julius Spitals in Würzburg, auch dieser ein Zeichen seiner Zeit
Das eindrucksvolle denkmalgeschützte Gebäude hat seine Rolle als Empfang an den neuen Nachbarn verloren und darf sich – nicht weniger wirkungsvoll - in dessen markanter, hängender Glasfassade zusammen mit der großen Brunnenanlage und Zugangstreppe spiegeln
Eine kühle, grünblau schimmernde Glasfassade in Kombination mit hellen Natursteinelementen, fünf oberirdischen Geschossen, Hubschrauberdachlandeplatz - der Bau wirkt kompakt und transparent zugleich Erst recht, wenn man die haushohe Empfangshalle mit der Cafeteria betritt und den Blick nach oben richtet Farbiges Glas lässt warmes Licht einfallen
Auf der dem Zentralbereich des Klinikums zugewandten Seite ist die Fassade in den Obergeschossen alternierend ausgebuchtet; es handelt sich um Erweiterungen der Patientenzimmer die wie eine moderne Interpretation der Nürnberger Chörlein anmuten
Und im Außenbereich darunter finden sich die Torsos der Sandsteinportale von Haus 4, einem der Gebäude, das dem Neubau weichen musste In dem grünen Zwischenhof steht auf einem der Portale in großen Lettern „Chirurgische Privat-Abteilung“ Ein Tor aus der Vergangenheit in die Zukunft, das Charme hat und damit auch einen Teil der baugeschichtlichen Entwicklung des Klinikums für Patienten und Besucher bewahrt
Dort, wo auf den historischen Fotografien, die an den Wänden im Haus 36 hängen, ein grünes Entree mit einem runden Brunnen zu erkennen ist, hat das architektonisch so heterogene Klinikum somit seine neue Mitte gefunden - und sich gleichzeitig nach außen geöffnet

Weiter im Rundgang: Da steht der Pavillon der Altvorderen nahe beim Protagonisten der 1980er-Jahre Bei Haus 12, dessen postmoderne Chörlein und Glaskuppeln wie verspielte Applikationen wirken
Vorbei am chirurgischen Zentrum von 2003, dem kantig in die Höhe geschossenen Dr Hans-BirknerHaus mit seinen hellgrün schimmernden Fassadenplatten Ihm hat die Dr Hans und Dr Elisabeth Birkner Stiftung auch großzügig „Kunst am Bau“ spendiert
Weiter nach Westen, wo die Magistrale, die die Kliniken von Ost nach West miteinander verbindet, wie eine verglaste Speiseröhre auf die Großküche des Nordklinikums zusteuert Das wirkt futuristisch und steht im größtmöglichen Kontrast zum Psychiatrie-Altbau Haus 31 gleich um die Ecke Er liegt idyllisch auf einem grünen Hügel, wie ein verträumtes Zauberberg-Sanatorium en miniature
Im Untergrund, wo die Architektur keine Rolle mehr spielt, pulsieren die technischen Lebensadern des Klinikums im Verborgenen Ringförmige unterirdische Wege, breit wie Straßen, versorgen wettergeschützt nahezu alle Gebäude mit Allem, was zum Betrieb des Klinikums erforderlich ist Hier kommt es zwar nicht auf Gestaltung an, dafür umso mehr auf exakte Funktionalität; an manchen Stellen musste man den Asphalt glattschleifen, damit die Suppe beim Essenstransport nicht überschwappt Manchmal kommt es eben auf die kleinen Dinge an






Krankenhäuser gehören zu den aufwändigsten und komplexesten Gebäuden unserer Zeit Dabei unterliegt kaum ein Gebäude so sehr einem ständigen Wandel wie ein Krankenhaus
Auf dem Areal des Klinikums Nürnberg Süd entsteht südlich zum bestehenden Gebäude und entlang einer neuen, großzügigen Magistrale der Neubau des Kinderklinikums mit Geburtshilfe und neuem Wirtschaftshof (Bild rechts) Die Projektkosten werden nach aktuellem Stand über 130 Millionen Euro betragen, woran sich der Freistaat Bayern mit weit mehr als 100 Millionen Euro beteiligen wird Der Spatenstich ist noch in 2022 geplant; wenn alles glatt läuft, wird 2026 die Eröffnung gefeiert

Das Klinikum Nürnberg hat bereits in der Vergangenheit auf einen strukturellen Rahmenplan gesetzt Darauf aufbauend wurde in 2016 - ausgehend von einem medizinischen Zukunftsgutachten - eine neue bauliche Zielplanung erstellt Diese bildet die Grundlage für die nächsten großen baulichen Veränderungen
Das Vorhaben ist eines der größten Neubauprojekte rund um die Versorgung von Kindern und Jugendlichen in Süddeutschland und wird Spitzenmedizin und erstklassige Versorgung vom ersten Lebenstag bis ins späte Jugendalter unter einem Dach vereinen – Tür an Tür mit der Geburtshilfe In dem Neubau mit rund 30 000 Quadratmetern Bruttogeschossfläche werden vier Kliniken eng zusammenarbeiten: die Klinik für Neugeborene, Kinder und Jugendliche, die Klinik für Kinderchirurgie und Kinderurologie, die Klinik für Frauenheilkunde mit dem Schwerpunkt Geburtshilfe sowie die Abteilung für Psychosomatik der Klinik für Psychiatrie, Psychosomatik und Psychotherapie im Kindes- und Jugendalter (KJP)
Dies ist aber nur ein Baustein der baulichen Weiterentwicklung des Klinikums Nürnberg Süd Es wird bereits am nächstem Neubaudem Notfallzentrum - gearbeitet In diesem sollen die Notaufnahme, Intensivstationen und der OP-Bereich sowie ein Hubschrauberdachlandeplatz neu errichtet werden Für diesen Neubau haben die Mitarbeiterinnen und Mitarbeiter aus allen involvierten Bereichen ihre Vorstellungen und Konzepte formuliert, die in die weiteren Planungen übernommen werden

Doch nicht nur in Langwasser wird gebaut Auch für den Standort Nürnberg Nord laufen Planungen Hier wird bspw ein Zentrum für seelische Gesundheit entstehen (Bild links), das auf rund 25 000 Quadratmetern Bruttogeschossfläche die Kliniken für Psychiatrie und Psychotherapie, für Psychiatrie, Psychosomatik und Psychotherapie im Kindes- und Jugendalter sowie für Psychosomatische Medizin und Psychotherapie unter einem Dach vereint Mit dem Neubau eröffnet sich für das Klinikum Nürnberg die Chance, die Versorgung von Menschen mit psychischen sowie psychosomatischen Erkrankungen über alle Altersgruppen hinweg
weiter zu entwickeln Die Kosten für eines der größten Bauvorhaben im Bereich der Psychiatrie in Bayern werden voraussichtlich über 90 Mio Euro betragen; auch hier wird sich der Freistaat Bayern mit über 80 Mio Euro beteiligen
Derzeit laufen die Detailplanungen gemeinsam mit den künftigen Nutzern Im neuen Zentrum soll unter anderem eine gemeinsame Notaufnahme der Kinder- und Jugend- sowie der Erwachsenenpsychiatrie entstehen Auch werden die Kliniken dann noch enger diagnostisch und therapeutisch zusammenarbeiten Die Therapiekonzepte werden sich noch stärker an den individuellen Krankengeschichten der Patientinnen und Patienten orientieren und die Behandlungsangebote noch stärker vernetzt
Doch nicht nur die Funktion eines Gebäudes steht im Fokus, auch der Umgang mit Energie und Ressourcen wird betrachtet Schließlich sollen Räume entstehen, in denen Menschen gesund werden und sich gleichzeitig sicher und gut fühlen
Susanne BeyerDie Küchen des Klinikums, die Wäscherei, das Materiallager, die Transportdienste und andere Serviceeinrichtungen sind seit 1999 in der „Klinikum Nürnberg Service-GmbH“ (KNSG) gebündelt Dort kümmern sich mehr als 1100 Mitarbeiterinnen und Mitarbeiter um das Wohl der Patienten, zumeist im Hintergrund, oft auch im Untergrund des Klinikums – von der Küchenhilfe bis zum Logistikmeister, von der Reinigungskraft bis zum Betriebswirt
Wir kochen, putzen, lagern, begleiten, transportieren, waschen und desinfizieren Sie finden uns im Kiosk des Klinikums Süd genau wie vor dem Hochregallager, in der Küche genauso wie auf den Stationen Für die Leserinnen und Leser der Festschrift haben wir ein paar exklusive Einblicke zusammengestellt

Wussten Sie, dass…
für eine Augen-OP rund 52 Instrumente, für eine Herz-OP rund 256 Instrumente benötigt werden? 97 Mitarbeiter*innen sorgen rund um die Uhr für die Aufbereitung aller medizinischen Instrumente
es neben drei Gerichten und immer einem Sondermenü täglich auch rund 140 Kostformen für spezielle Diäten gibt? In unseren Küchen sorgen 150 Mitarbeiterinnen und Mitarbeiter jeden Tag für das passende Gericht

das Klinikum Nord zum großen Teil über einen rund 1,3 Kilometer langen unterirdischen Versorgungsgang beliefert wird? Insgesamt sind täglich 25 Fahrzeuge mit einer Fahrleistung von 1100 km im Einsatz
täglich über 1100 Patienten zu Untersuchungen in die einzelnen Fachkliniken und Untersuchungs- und Behandlungsbereiche gebracht werden? Ob im Bett, im Sitzwagen, im Rollstuhl oder zu Fuß – unser Patiententransportdienst ist 24 Stunden im Einsatz Die Koordination erfolgt über eine Software, die die Disposition steuert – dadurch werden lange Wartezeiten vermieden
für das Wohlbefinden und die Sauberkeit in allen Bereichen pro Woche 59 000 Mopps und 111 000 Reinigungstücher benötigt werden?
täglich rund 16 Tonnen Wäsche bewegt werden? Vom Waschlappen bis zur Bettwäsche, vom Handtuch bis zur OP-Kleidung unser Zentrallager das Klinikum täglich mit rund 1700 Artikeln versorgt – vom 50 Liter Behälter bis zur Knopfzelle? Alle Artikel stehen am Standort Nord in einem Hochregallager bereit Die gefragtesten Artikel sind Einmalhandtücher und Toilettenpapier
die Reinigung nicht ganz so einfach ist, wie vielleicht zu Hause? Um die größtmöglichen Hygienestandards zu ermöglichen wird im Klinikum mit einem 4-Farb-System gearbeitet: Rot: WC-Bereich, Blau: Sanitärund Duschbereich, Grün: Alle Oberflächen, Gelb: Desinfektionsreinigung auch die Zukunft im Klinikum angekommen ist? Seit Januar 2021 desinfizieren wir kritische Bereiche im Klinikum Nürnberg Süd zusätzlich nach der Reinigung noch mit einem Desinfektionsroboter!
Claudia Röschlein






Das Klinikum Nürnberg ist das Krankenhaus der Stadt – seit 125 Jahren Generationen von Kindern wurden hier geboren, Generationen von Mitarbeitenden ausgebildet, Generationen von Politikern begleiteten das Haus in seiner wechselvollen Geschichte Wir haben besondere Menschen gefragt, was sie mit dem Klinikum Nürnberg verbinden
Krankenschwester war schon immer ihr Berufswunsch gewesen 1971 hat Beck ihre Ausbildung am Klinikum begonnen und 1974 mit dem Examen abgeschlossen Sie arbeitete zunächst auf einer Station der inneren Medizin im Nordklinikum, bis 1976 eine Notaufnahme eingerichtet wurde „Das war mein Traumziel in der Krankenpflege Ich habe mich dafür gemeldet und bin genommen worden“, erinnert sie sich
Dienstälteste Mitarbeiterinnen Maria Beck - Gertrud Högl - Erika Heymann-Margis
Da sitzen sie nun bei einer Tasse Kaffee zusammen, drei Mitarbeiterinnen des Klinikums Jede von ihnen bringt stolze 50 Jahre Berufserfahrung in der Krankenpflege mit Und trotzdem denkt keine von ihnen so richtig ans Aufhören - zumindest nicht in nächster Zukunft
„Bist du denn wahnsinnig“, solche Sprüche bekommt Maria Beck schon öfters aus dem Bekanntenkreis zu hören Aber sie winkt nur ab „Mir macht meine Arbeit in der Notaufnahme immer noch Spaß Warum sollte ich nicht weitermachen?“
Bis heute ist Maria Beck dort im Dienst, auch wenn sie nach 45 Berufsjahren zunächst in Rente ging, dann auf 450-Euro-Basis zurückkehrte und inzwischen sogar wieder 60 Stunden im Monat arbeitet Ihre Erfahrung, ihre Routine, ihr kühler Kopf und ihr Organisationstalent sind nach wie vor sehr gefragt Wer ihr zuhört, der spürt: Sie hat „ihre“ Notaufnahme fest im Griff „Wir sind das Aushängeschild des Klinikums, der erste Eindruck eines Patienten entsteht hier“, sagt Beck Im Dezember läuft ihr Vertrag aus „Aber ich weiß noch nicht, ob ich da wirklich aufhören will “
Ihre Tischnachbarinnen können das gut verstehen Gertrud Högl und Erika HeymannMargis haben gemeinsam von 1972 bis 1975 die Ausbildung zur Kinderkrankenschwester am Klinikum gemacht Auch sie sind nach der Rente noch aktiv in ihrem Beruf, auf 450-Euro-Basis versorgen sie zwei oder drei Tage im Monat kranke Babys, Kinder und Jugendliche

Gertrud Högls Herz gehört den Säuglingen, und zwar von Kindheit an: „Als Älteste von neun Kindern hatte ich in der Familie immer ein Baby, um das ich mich gekümmert habe “ Der Berufsweg war damit vorgezeichnet „Diese Arbeit erfüllt mich bis heute, das ist meine Berufung“, sagt Högl
Es gibt für sie nichts Schöneres als den Moment, wenn ein Neugeborenes zum ersten Mal an der Brust der Mutter trinkt, nachdem es nach einer Infektion wieder zu Kräften gekommen ist Auch der Kontakt mit den oft verängstigten Müttern ist ihr wichtig Es
hilft, wenn Gertrud Högl ihnen sagt, dass sie vor allem auf ihr Baby und nicht ständig auf den Überwachungsmonitor achten müssen
„Als der Tag der Rente immer näher rückte, war mir klar, dass ich die Kinder und ihre Eltern sehr vermissen würde“, meint Högl Deshalb übernimmt sie nach wie vor Dienste, bis Februar 2023 will sie auf jeden Fall noch weiter machen
Für Erika Heymann-Margis stand ebenfalls früh fest, dass sie in die Kinderkrankenpflege wollte – auch wenn manche in ihrem Umfeld damals etwas überheblich meinten, da müsse man doch nur mit den Kleinen ein bisschen spielen, sie füttern und wickeln Nach dem Examen arbeitete sie zunächst auf der Säuglingsstation am Kirchenweg im Nordklinikum Später richtete der damalige Chefarzt eine neuropädiatrische Station in der Kinderklinik ein „Dort haben wir uns um größere, behinderte Kinder gekümmert Ich habe gemerkt, das ist wirklich mein Ding“, erzählt Heymann-Margis
Heute arbeitet sie auf einer gemischten Station der Klinik für Neugeborene, Kinder und Jugendliche Station, die 1994 ins Südklinikum umgezogen ist Bis November 2022 will die erfahrene Kinderkrankenschwester auf jeden Fall mit im Boot bleiben
Gemeinsam schwelgen die drei Kolleginnen an diesem Nachmittag noch in vielen Erinnerungen
Roland Cantzler, Ehrenvorsitzender des Bürgervereins St Johannis-Schniegling-Wetzendorf, kann sich noch gut daran erinnern, welchen Wirbel seine erste nähere Begegnung mit den Städtischen Krankenanstalten an der Flurstraße ausgelöst hatte „Es muss so Anfang der 1970er-Jahre gewesen sein, als ein Mitglied des Bürgervereins, ein Diakon, auf mich zukam Er sagte, es müsse unbedingt etwas geschehen“, erzählt der heute 91 Jahre alte Cantzler

Als CSU-Stadtrat und gesundheitspolitischer Sprecher seiner Partei sah er sich zusammen mit einigen Mitstreitern die Situation vor Ort an „Da lagen zehn oder zwölf Patienten in einem Saal Sie hatten keine Kleiderschränke und sie mussten sich ohne Vorhang als Sichtschutz an einer Reihe nebeneinander stehender Waschbecken sozusagen vor Publikum waschen “ Es entbrannte eine heftige Debatte im Stadtrat, auch die Zeitungen griffen das Thema auf „Bei der Eröffnung des Krankenhauses im Jahr 1897 waren die Pavillons, in denen die Kranken versorgt wurden, ein europäisches Vorzeigeprojekt Aber die Bauten waren in die Jahre gekommen, eine Sanierung wurde unausweichlich“, so Cantzler
So kam es dann auch Neben den Plänen für eine Modernisierung begannen auch die Überlegungen für einen Ausbau der Städtischen Krankenanstalten Da aber auf dem Gelände in Johannis nicht genug Platz war, entschied man sich schließlich für einen zweiten Standort in Langwasser „Ich habe in den Mitteilungen des Bürgervereins St
Johannis-Schniegling-Wetzendorf regelmäßig und oft über die Neuerungen im Klinikum berichtet“, sagt Cantzler
Über seine Fraktion brachte er auch einige Anträge ein, die zu Veränderungen führten So regte er etwa an, dass das Klinikum eine Patientenvertretung einrichtet Als er wiederum über den Bürgerverein erfuhr, dass die Apotheke vom Johannis ins neue Südklinikum zieht, machte Cantzler sich dafür stark, dass die alte Apotheke als Krankenhausmuseum erhalten bleibt Er war schließlich mit im Boot, als das Klinikum zusammen mit dem Stadtarchiv und einem Architekten die Idee in die Realität umsetzte
„Ich war mit dem Klinikum schon sehr verbunden und wurde oft als Gast eingeladen, auch als ich nicht mehr Stadtrat war“, sagt Cantzler Klagen von Nachbarn über das Klinikum, etwa über Baulärm, habe es kaum gegeben, so der langjährige Bürgervereinsvorsitzende „Wenn, dann waren das mal Kleinigkeiten, die sich schnell regeln ließen Während meiner Amtszeit mussten wir als Bürgerverein jedenfalls nie beim Klinikum groß intervenieren “
Für seinen Vater Arno Hamburger war das Klinikum eine Herzensangelegenheit Als SPD-Stadtrat und als Mitglied des Verwaltungsrates war er stets auf dem Laufenden darüber, was in dem Kommunalunternehmen – auch hinter den Kulissen - vor sich ging Er pflegte enge Kontakte in den Vorstand, kannte unzählige Ärzte persönlich und versuchte immer zu helfen, wenn das Klinikum seine Unterstützung brauchte, um ein Anliegen zu realisieren
Sein Sohn Jo-Achim Hamburger, der nach dem Tod des Vaters zu dessen Nachfolger als Vorsitzender der Israelitischen Kultusgemeinde gewählt wurde, freut sich, dass die engen Beziehungen zum Klinikum Nürnberg geblieben sind „Ich bin sehr dankbar, dass wir immer ein offenes Ohr finden, wenn wir Hilfe insbesondere für unsere betagten, kränkelnden Gemeindemitglieder brauchen, die sich oft auch mit der Sprache schwer tun“, erklärt Jo-Achim Hamburger „Die Zusammenarbeit ist hervorragend“
Am 30 September 1998 – dem 60 Jahrestag des Entzugs der Approbation jüdischer Ärzte durch die Nationalsozialisten – hat das Klinikum Nord eine neue Adresse bekommen: Die Flurstraße wurde in Prof -Ernst-Nathan-Straße umbenannt Nathan hatte als Dermatologe und anerkannte Kapazität 1923 die Leitung der Hautklinik am städtischen Krankenhaus in Nürnberg übernommen Zehn Jahre später wurde er nach der Machtübernahme der Nationalsozialisten aus antisemitischen Gründen entlassen Mit der Umbenennung der Flurstraße wollte
Nürnberg ein Zeichen setzen und mit Prof Nathans Schicksal stellvertretend an die Opfer einer unmenschlichen NS-Medizin erinnern Jo-Achim Hamburger: „Das war für meinen Vater persönlich, aber auch für die israelitische Kultusgemeinde in Nürnberg ein wichtiges Signal “

Kulturbürgermeisterin Stadt Nürnberg Prof. Dr. Julia Lehner
Diesen heißen Sommer-Sonntag im Juli 1971 wird Prof Dr Julia Lehner, Kulturbürgermeisterin der Stadt Nürnberg, nie vergessen Sie hatte damals als Schwesternhelferin im Klinikum Dienst, als plötzlich Alarmstimmung in der Notaufnahme herrschte „Ärzte kamen, teils noch in kurzem Hosen, direkt aus dem Freibad oder dem heimischen Garten angerannt“, erinnert sie sich
Der Grund für die Hektik: Der bekannte mexikanische Rennfahrer Pedro Rodríguez war bei einem Unfall auf dem Norisring mit seinem Wagen in die Leitplanken katapultiert
worden und musste von Rettungskräften aus seinem brennenden Fahrzeug befreit werden „Ich habe ihn kurz gesehen, als er in der Notaufnahme ankam In einer stundenlangen Operation versuchten die Ärzte, sein Leben zu retten Aber er ist leider verstorben,“ erzählt Julia Lehner
Während ihrer Schulzeit am Sigena-Gymnasium ergab sich die Möglichkeit, beim Roten Kreuz eine Ausbildung zur Schwesterhelferin zu absolvieren „Ich hatte überlegt, Medizin zu studieren, da habe ich dieses Angebot gerne genutzt“, so Lehner Mit der Ausbildung verbunden war ein Praktikum im Klinikum - und daraus entstand eine langjährige Verbindung „Ich habe in den Schulferien und während der Semesterferien immer längere Zeit am Stück am Klinikum als Schwesterhelferin gearbeitet“, berichtet die heutige Kulturbürgermeisterin Oft war sie in der Chirurgie oder in der Neurologie eingesetzt, hat Patientinnen und Patienten gewaschen, gefüttert, umgebettet oder zum Röntgen gefahren Auch Tabletten durfte sie vorrichten, wenn eine Pflegefachkraft dabei war Unvergessen ist für sie auch, dass sie manchmal im Hintergrund bei Operationen dabei sein durfte, weil die Ärzte und Schwestern ihr großes Interesse für Medizin spürten Sie betont: „Das ist bis heute so geblieben, als Laie interessiert mich diese Thematik nach wie vor“
Ihre Einsätze am Klinikum endeten, als es dort zu einem Beschäftigungsstopp für Pflegehelferinnen und –helfern kam Von ihrer Zeit am Klinikum hallte vieles nach: „Mitgenommen habe ich lebensbleibende Eindrücke Zu manchen Patienten entstanden Kontakte, die oft über den Klinikaufenthalt hinaus Bestand hatten “
Altoberbürgermeister Stadt Nürnberg Dr. Ulrich Maly
Die erste Begegnung mit dem Klinikum verlief für Altoberbürgermeister Ulrich Maly sehr kurz: „Ich habe dort nur eine Nacht verbracht, weil meine Mutter nach meiner Geburt schnell wieder nach Hause wollte Der große Bruder hat die Mama gebraucht “
Später hat sich das geändert Als Kämmerer begleitete Maly die Umwandlung zum Kommunalunternehmen, und als Oberbürgermeister - und damit Verwaltungsratsvorsitzender des Klinikums - tauchte er noch tiefer in den Krankenhauskosmos ein Jede gesundheitspolitische Änderung musste auf die Folgen für das Klinikum abgeklopft werden
Wichtig für ihn und die Mitstreiter war die Frage, wie das Klinikum trotz seiner Größe menschlich organisiert werden kann „Geld ist ein Problem Maximalversorger werden von der Gesundheitspolitik immer schlecht behandelt, während es den Rosinenpickern zum Beispiel durch das Vergütungssystem über Fallpauschalen besser geht“, meint er

Für Maly und die Stadt war es dennoch nie ein Thema, das Klinikum sozusagen als Tafelsilber an private Klinikbetreiber zu veräußern „An Angeboten von Kaufinteressenten hat es aber nie gefehlt, bis in die jüngste Zeit Aber wir haben alle Avancen abgelehnt “ Er sei stolz und froh, dass die Stadt so ein medizinisches Schwergewicht hat „Ich halte unser Krankenhaus für unverzichtbar auch für das Grundvertrauen der Menschen in die Leistungsfähigkeit ihrer Stadt “

Die Verbundenheit zum Klinikum ist nach seinem Ausscheiden aus dem Amt des Oberbürgermeisters geblieben: „Ich bin einer der Botschafter für das Kinderklinikum, das ist eines der sehr raren Ehrenämter, die ich angenommen habe “
Familie Lehnhoff Jakob und Jan
630 Gramm und 430 Gramm Das wiegen Jakob und Jan bei ihrer Geburt am 24 Februar 2020 im Nürnberger Südklinikum Zwei kleine Leben, kaum größer als eine Hand Das Team der Geburtshilfe holt die eineiigen Zwillinge in der 24+2 Schwangerschaftswoche per eiligem Kaiserschnitt Die Gebärmutter der Mutter kann die Zwillinge nicht mehr ausreichend versorgen Eines von ein paar Dutzend Mehrlingspaaren jedes Jahr im Nürnberger Klinikum, deren Leben in den ersten Wochen, und im Falle von Jakob und Jan, in den ersten Lebensmonaten, am seidenen Faden und an der ärztlichen Kunst hängt
Gleich nach der Abnabelung werden Jakob und Jan in die Neonatologie gebracht, wo Oberärztin Dr med Katja Knab aus dem Team von Klinikleiter Prof Dr med Christoph Fusch zusammen mit ihren Kolleginnen und Kollegen um das Leben der Zwillinge kämpft
Vier Operationen am Darm muss Jakob über sich ergehen lassen, immer wieder versagt das Organ Erst im Oktober 2020, acht Monate nach der Geburt, kann Familie Lehnhoff ihn zu sich nach Hause holen, zu seinem Zwilling Jan, der seit Juli entlassen ist, und der um vier Jahre älteren Schwester Anni „Es war eine emotionale Achterbahnfahrt, über Monate hinweg“, erzählt Katrin Lehnhoff, die Mutter „Hoffen, Bangen, Freude, Angst, alles “
Das Team der Klinik für Neugeborene, Kinder und Jugendliche habe die Familie unglaublich gut unterstützt

„Alle waren sehr empathisch, und gleichzeitig offen, wir wussten jederzeit, wie es um unsere Zwillinge steht“ Heute, gut zwei Jahre später, sind die beiden Jungen noch immer sehr zart, „doch sie holen auf, jeder auf seine Weise und in seinem Tempo“, sagt Katrin Lehnhoff „Es wird von Tag zu Tag besser“
Weil sich beide Jungen als Kämpfernaturen erwiesen, die unbedingt JA sagten zum Leben, bekamen sie auch die Namen Jakob und Jan Das Ja schwingt auch im Namen von Katja Knab mit, die bis heute mit der Familie im Kontakt steht und sich darüber sehr freut, Namenspatin mit sein dürfen „Jakob und Jan haben mich, haben uns alle hier über Monate herausgefordert und wir sind stolz und glücklich für die Familie, dass sie es geschafft haben“
Wegbegleiterin Brigitte Wambach
„Kam ein Mann mit Blumen und Kuchen, um Frau Mutter zu besuchen…“ Brigitte Wambach kann das Gedicht noch heute auswendig, mit dem ihr späterer Ehemann Klaus das Kennenlernen in Reime gegossen hat Es folgten noch viele andere, aber das erste Gedicht war für sie das Schönste „Das hat mein Herz erobert, ich konnte gar nicht anders, als mich in ihn zu verlieben“, meint Brigitte Wambach und lacht
Der junge Klaus, im Dienst der Stadtverwaltung, hatte seine Mutter im städtischen Krankenhaus besucht Am Krankenbett lief ihm die nette Schwester Brigitte über den Weg Prompt funkte es Jeden Abend stand Klaus Wambach später vor der Pforte des Klinikums, um Brigitte abzuholen Spätestens um 22 Uhr musste sein Schwarm im
Schwesternwohnheim zurück sein – Pfortenschwester Rosemarie kannte kein Erbarmen Wer verliebt ist, kennt keine Hindernisse: Klaus Wambach krabbelte unterhalb der Pforte unbemerkt am „Zerberus“ vorbei Viele Jahre später, Klaus Wambach war inzwischen Vorstand, wurde das Wohnheim abgerissen „Als späte Rache an der Pfortenschwester“, wie Wambach damals mit einem Augenzwinkern erzählte

passiert, geraten Bauverantwortlichen wie Karlheinz Moßner schon mal ins Schwitzen „Im Großen und Ganzen sind wir da aber immer gut klargekommen Vor allem sind wir vor größeren Unfällen auf den Baustellen verschont geblieben,“ meint Moßner rückblickend auf seine „Amtszeit “
Eigentlich könnte man Karlheinz Moßner einen Baulöwen nennen Schließlich hat er die beeindruckende Summe von geschätzt einer halben Milliarde Euro über Jahrzehnte hinweg „verbaut“ Aber Moßner hat diese Investitionen nicht als Privatmann geschultert, sondern als Bereichsleiter Bau und Technik am Klinikum Nürnberg

„Ich war für fast alle Neubauten und Renovierungen im Nordklinikum zuständig, später kamen am Standort in Langwasser noch die Bauten für das Ambulante Reha-Zentrum ARZ, für das Herz-Gefäß-Zentrum, den Kindergarten, die Tagesklinik der Kinder- und Jugendpsychiatrie und für das Parkhaus mit 800 Plätzen hinzu“, zählt Moßner auf, der im Ruhestand lebt Dazu kamen noch sehr aufwändige Renovierungen, wie etwa beim markanten Y-Bau
Architektenwettbewerbe ausschreiben, Förderanträge stellen, Gebäude abreißen, Gewerke vergeben - bis ein Neubauprojekt begonnen werden kann „können schon fünf oder sechs Jahre ins Land ziehen“ Immer wieder durchkreuzen auch unvorhergesehene Ereignisse die Zeitpläne Wenn das dann auch noch kurz vor der Fertigstellung

Als Schwesternschülerin im Klinikum erlebte Brigitte Wellhöfer Anfang der 1970er Jahre vieles, was heute skurril oder gar unvorstellbar erscheint „Wenn die weißen Arztkittel frisch aus der Wäscherei kamen, mussten wir Schülerinnen die Knöpfe anbringen: weiße für die Stationsärzte, silberne für die Oberärzte und goldene für die Chefärzte“, erinnert sie sich 40 Patienten auf einer Station am Sonntagnachmittag alleine als Auszubildende im ersten Jahr zu versorgen, auch das hat Wellhöfer erlebt Oder geteilte Dienste am Wochenende, bei denen es von 5 45 bis 12 Uhr auf Station ging und dann nochmal von 17 bis 20 Uhr „So schwierig die Arbeitsbedingungen auch
heute oft noch in Medizin und Pflege sind, im Vergleich zu damals hat sich doch zum Glück vieles zum Positiven verändert“
WinklerDie meisten Menschen in Nürnberg und der Metropolregion verbinden mit dem Klinikum Nürnberg medizinische Versorgung und Pflege im Krankheitsfall Doch ein so großes Haus wie das Klinikum Nürnberg ist weit mehr Es ist eine kleine Stadt in der Stadt mit zwei Standorten und vielen unterschiedlichen Menschen dort, die sich auf unterschiedlichsten Wegen miteinander und nach außen verbinden, engagieren und vernetzen Dabei sind in den vergangenen Jahrzehnten zahlreiche Projekte und Kooperationen entstanden Einige besondere Initiativen stellen wir Ihnen auf den nächsten Seiten vor
Das gibts nur am Klinikum Narkoseärzte und Pfleger*innen, die abrocken Sie rocken das Klinikum nach Noten: die Anästhesieband NarkotiXX Rock und Pop der 1970er und 1980er-Jahre, Hits von Queen, Peter Gabriel oder AC/DC, aber auch Moderneres von Robbie Williams, Pink oder den Toten Hosen – wenn die Musiker und die beiden Sängerinnen zum Beispiel auf den Mitarbeiterfesten des Klinikums loslegen, dann ist die Tanzfläche im Nu gefüllt
Die Idee für eine Band entstand 2002 auf der Verbrauchermesse Consumenta, wo sich auch das Klinikum präsentierte „Wir von der Anästhesie waren mit von der Partie und erklärten Besuchern zum Beispiel, wie ein Patient intubiert wird“, erinnert sich Dr Axel Hubert, heute Oberarzt und Standortleiter der Klinik für Anästhesie und operative Intensivmedizin am Klinikum Nord Natascha Köstler, Pflegekraft aus der Anästhesie, kam vorbei und erzählte, dass es in Erlangen eine „Narkose-Band“ gibt und man doch so was auch am Klinikum aufziehen könnte Zwei Jahre später waren genug Mitglieder beisammen Ein halbes Jahr später gab die Band NarkotiXX ihre Premiere

bei einem Sommerfest einer Klinik auf der Wiese im Südklinikum „Wir haben so zehn, elf Songs gespielt und kamen gut an“, so Axel Hubert, der inzwischen der Kopf der Band ist und selbst Bass spielt und singt Mehr als vier Auftritte pro Jahr schaffen die „NarkotiXX“ nicht, denn alle arbeiten in Schichtdienst Neben Auftritten bei Mitarbeiterfesten bestreiten sie auch regelmäßig Konzerte bei der Waldweihnacht in Erlangen Die NarkotiXX spielen ohne Gage, bekommen höchstens mal eine kleine Aufwandsentschädigung Ihr Lohn ist der Spaß, den ihre Zuschauer, aber auch sie selbst haben
Das gibts nur am Klinikum Spitzenmedizin trifft Spitzensport
Bei ihm geben sich Spitzensportler die Klinke in die Hand: Privatdozent Dr Markus Geßlein, Leiter der Abteilung Sportorthopädie am Klinikum, kümmert sich um all jene, die ihrem Körper sportliche Höchstleistungen abverlangen Seit 2021 hat Geßlein auch einen Vertrag als Mannschaftsarzt beim 1 FCN Gemeinsam mit Dr Johannes Rüther von der Klinik für Orthopädie und Unfallchirurgie, Dr Bernd Langenstein, Leiter des Instituts für Sportmedizin am Klinikum sowie dem niedergelassenen Orthopäden Prof Werner Krutsch bildet er das „FCN Medical Team“
Die Ärzte sitzen bei allen Spielen im Stadion auf der Bank, sind beim Training dabei oder begleiten die Mannschaft auch ins Trainingslager Denn für die Profis ist es ganz wichtig, dass ihre Beschwerden sofort abgeklärt werden
Das Institut für Sportmedizin von Bernd Langenstein übernimmt die internistische Leistungsdiagnostik, zusammen mit den Orthopäden aus dem Team wird jeder Spieler jährlich vor der Saisonbeginn auf seine Sporttauglichkeit untersucht Auch die Transferuntersuchungen, also die medizinischen Checks bevor ein Spieler neu „eingekauft“ oder ausgeliehen wird, sind Aufgabe des FCN Medical Teams


Neben den FCN-Spielern kümmert sich das Klinikum seit Jahren auch um Sportlerinnen und Sportler samt Olympioniken aus dem Bundesstützpunkt Taekwondo, der in Langwasser angesiedelt ist, um Triathleten vom Landesstützpunkt an der Bertolt-BrechtSchule, um Spieler der Nürnberg Rams oder um die Ringer der Nürnberg Grizzlys, um nur einige zu nennen
Besonders am Herzen liegt Geßlein der Nachwuchs „Wenn Kinder in der Wachstumsphase verletzt und dann nicht adäquat behandelt werden, ist ihnen häufig der Weg zu einer Sportkarriere verbaut Spitzensport braucht Spitzenmedizin “
Das gibts nur am Klinikum Kinder-Uni mit Stethoskop & Co
Manchmal verschwinden die jungen Forscherinnen und Forscher beinahe in den weißen Arztkitteln Oder die Kopfhaube rutscht halb ins Gesicht Aber das tut der Begeisterung der Studierenden an der Kinderuni am Klinikum Nürnberg keinen Abbruch Im Gegenteil, eine angemessene Berufskleidung macht schon was her, wenn die „Minis“ wie selbstverständlich durch die Krankenhausflure wuseln
An einem Tag in den Ferien erfahren 40 Jungs und Mädchen zwischen acht und zwölf Jahren zum Beispiel, wie die Niere als Klärwerk des Körpers funktioniert Nach einer Einführungsvorlesung geht es – in vier Zehner-Gruppen unterteilt und meist von Schwesternschülerinnen begleitet - zu verschiedenen Stationen, wo nicht nur Zuhören, sondern auch Anfassen und Ausprobieren angesagt ist Da wird zum Beispiel gegenseitig der Blutdruck gemessen und profimäßig der Stethoskop-Kopf unter die Mess-Manschette gelegt Fasziniert erleben die Kinder, wie ein Ultraschallgerät die Niere auf einem Bildschirm sichtbar macht Nach einer Stärkung bei Getränken und Snacks lassen die Jungstudenten zum Schluss verschmutztes Wasser durch verschiedene Filter laufen und bekommen dadurch eine Vorstellung, welche Aufgaben die menschliche Niere übernimmt
Schon seit 2005 gibt es am Klinikum ein Angebot, das Kindern einen Einblick in die Medizin gibt und gleichzeitig auch den Ablauf in einem Krankenhaus vorstellt Die KinderAkademie „Kli-Ki“, wie sie zu Beginn hieß, ging später in die Kinder-Uni über „Wir wählen immer ein neues Thema für einen Kinderuni-Tag aus“, berichtet Judith Peltner, Pflegedienstleiterin in der Klinik für Neugeborene, Kinder und Jugendliche Es ging schon ums Herz, ums Gehirn oder auch um die Lunge Weil in der Corona-Pandemie keine „Präsenz-Vorlesungen“ stattfinden konnten, startete die Kinder-Uni auch online durch Oft geben die jungen Absolventen ihr frisch erworbenes Wissen an die Eltern weiter Inklusive Vorträge darüber, wie schädlich Rauchen ist…

Das gibts nur am Klinikum Einen Verein, der Hoffnung zaubert
Damit das Leben gelingt – dieser Satz aus dem Logo des Vereins Klabautermann bringt das Ziel der Arbeit auf den Punkt: Chronisch kranke Kinder und deren Familien nach der Entlassung aus der Kinderklinik oder der Kinderchirurgie am Klinikum zu begleiten und dafür zu sorgen, dass sie alle Hilfe und Unterstützung bekommen, die sie daheim in ihrem neuen, anderen Leben brauchen

Der gemeinnützige Verein wurde 1990 gegründet und kümmert sich um Früh- und Risikogeborene, um Buben und Mädchen nach einem Unfall, um chronische kranke Kinder oder um besondere Kinder, wie Hanne Henke, die Vorsitzende des Fördervereins, behinderte junge Patienten liebevoll nennt

Ein Team aus Krankenschwestern, Sozialpädagogen, Psychologen oder auch Seelsorgern besucht die betroffenen Familien zuhause in deren Alltag Kommen die Eltern mit der Bedienung von medizinischen Geräten wie Sonden oder Sauerstoffgeräten zurecht? Brauchen sie noch Hilfsmittel? Wie sieht es mit der Einstufung in einen Pflegegrad oder einem Behindertenausweis aus? Möchte sich ein Elternteil mal den Kummer von der Seele reden?
Mit Hilfe der Spendenaktion Sternstunden des Bayerischen Rundfunks hat der Klabautermann ein Spielhaus und ein Nachsorgehaus realisieren können Im Spielhaus haben die kleinen Patienten eine Rückzugsmöglichkeit aus dem Krankenhausbetrieb Im Projekt „Jetzt bin ich mal dran“ rücken gesunde Geschwisterkinder in den Mittelpunkt – ob bei Aktionen im Spielhaus oder bei Freizeitaktivitäten Im Nachsorgehaus gibt es zwei Elternwohnungen „Mütter und Väter, die weiter entfernt wohnen, können dort mal in Ruhe duschen oder lesen In kürzester Zeit sind sie aber wieder bei ihren Kindern in der Klinik“, erklärt Henke
Zuletzt konnten bis zu 220 Familien in ganz Mittelfranken pro Jahr von der Begleitung durch den Klabautermann profitieren
Das gibts nur am Klinikum Mitmachsport für Jedermann und Jederfrau

Am Anfang stand eine spontane Idee: Werner Bruns, passionierter Marathon-Läufer und Anästhesie-Pfleger, sowie Stephan Kolb, ambitionierter Freizeit-Läufer und Leiter des Centrums für Kommunikation, Information und Bildung (cekib), trommelten eine Mannschaft aus dem Klinikum zusammen, um gemeinsam am Erlanger Stadtmarathon 2001 teilzunehmen
Prompt belegten einige Läufer vordere Plätze Also folgte der nächste Plan: Vielleicht sollte man zum Beispiel regelmäßige Laufgruppen als Gesundheitsprävention für die Mitarbeiterinnen und Mitarbeiter des Klinikums anbieten Auch dieses Angebot fand schnell großen Zuspruch Und so ergab sich 2003 der nächste Schritt: Der Verein Team Klinikum Nürnberg (TKN) wurde aus der Taufe gehoben
„Wir haben uns gegen einen Betriebssportverein entschieden, denn es sollten zum Beispiel auch Angehörige von Mitarbeitenden mitmachen können Unsere Angebote stehen allen offen“, sagt Werner Bruns, erster TKN-Vorstand und Lauftherapeut Kurze Zeit nach der Gründung entstand die Idee zu einem ersten Silvesterlauf in Nürnberg Inzwischen hat der Verein Team Klinikum Nürnberg an die 500 Mitglieder, die zu 75 Prozent nichts mit Medizin oder Krankenhaus zu tun haben Bewusst erhebt der
Verein niedrige Mitgliedsbeiträge, die sich auch Alleinerziehende etwa aus der Pflege leisten können „Wir verzichten damit auf eine Sportförderung der Stadt, die an eine bestimmt Beitragshöhe geknüpft ist Aber das ist es uns wert“, sagt Bruns
Längst geht es nicht mehr nur um Laufangebote Radfahren, Triathlon, Schwimmen, aber auch Yoga, Rumpfstabilität oder Floorball, eine noch relativ junge Mannschaftssportart, stehen ebenso auf dem vielfältigen Kursprogramm Vermittelt werden die Sportarten von ausgebildeten Trainern Lachend tritt Werner Bruns auch einem offenbar weit verbreiteten „Gerücht“ entgegen „Bei uns im TKN trainieren nicht nur harte Hunde, wir kümmern uns um absolute Anfänger genauso wie um Fortgeschrittene oder Leistungssportler “
Das gibts nur am Klinikum Eine Partnerschaft, die bewegt
Seit 2012 unterstützt der Nürnberger Verein Fi Bassar, übersetzt „Rettet Bassar“, Vorhaben im Bereich Bildung und Gesundheit in der Stadt Bassar im westafrikanischen Togo Das kleine Land mit seinen rund acht Millionen Einwohnern hat zwar einen beachtlichen Wirtschaftsaufschwung erlebt, jedoch kommt dieser bei der Bevölkerung außerhalb der Hauptstadt und auf dem Land nicht spürbar an
Deshalb engagiert sich der Verein durch den Bau verschiedener Schulen, der Förderung der beruflichen Chancen durch Ausbildungspatenschaften und die Verbesserung der Gesundheitsversorgung Dank des engagierten Einsatzes von Vereinsgründerin Rali Guemedji, ihres Teams und der Klinikpartnerschaft mit dem Klinikum Nürnberg, die seit 2017 besteht, konnte auch die medizinische Situation in Bassar in den vergangenen Jahren deutlich verbessert werden
In Zusammenarbeit mit dem Nürnberger Institut für Nachhaltigkeit werden regelmäßig Fördergelder beantragt, Ehrenamtliche organisieren Hilfsgütertransporte und unterstützen vor Ort mit OPs und Schulungen z B im Bereich Hygiene 2021 spendeten unter anderem Mitarbeiterinnen und Mitarbeiter des Klinikums Nürnberg einen Krankenwagen, der seither als einziger Krankentransporter in einem Gebiet mit 125 000 Einwohnern im Einsatz ist
Als nächstes Projekt plant die rührige Initiative den Bau einer neuen Pädiatrie auf dem Gelände des Krankenhauses in Bassar und hofft auf Spenden für dieses neue Herzensprojekt
Info: www fibassar de Karin Winkler

Herausgeber: Klinikum Nürnberg ℅ Prof Ernst Nathan Straße 1 ℅ 90419 Nürnberg
Idee, Konzeption und Redaktionsleitung: Isabel Krieger, Dipl Germanistin-Journalistin
Design und Realisation: Werbeagentur Pegnitzdesign, Torsten Seeliger, Reichenschwand V i S d P : Barbara Lay
Externe Autorinnen und Autoren: Karin Winkler (Leitend), Bernd Windsheimer (Geschichte Für Alle e V ), Claudine Stauber
Autorinnen und Autoren Klinikum: Isabel Krieger, Dr Stephan Kolb, Sabine Stoll, Susanne Beyer, Stephan Zielinski, Prof Dr Bert Reichert, Nadine Heym, Andrea Nätscher, Beyhan Calik, Dr Julia Simon, Anita Scheibinger, Daniela Schindler, Barbara Lay, Alexander Pazicky, Tanya Porter, Beate Neuffer, Claudia Röschlein, Dr Thomas Grüneberg
Fotografie: Giulia Iannicelli (Leitende Fotografin), Rudi Ott, Uwe Niklas, Eduard Weigert, Roland Fengler, Günter Distler, Dorit Schatz, Jasmin Szabo, Isabel Krieger, stock adobe com
Historische Aufnahmen: Verein Geschichte Für Alle e V , Stadtarchiv Nürnberg, Nürnberger Nachrichten, Klinikum Nürnberg, Ernst Bayerlein
Druck: Hofmann Infocom Nürnberg
Auflage: 10 000, Mai 2022
Herzlichen Dank an alle, die in Form von Gesprächen, Informationen, Bildmaterial und Dokumenten zu der Festschrift 125 Jahre Klinikum Nürnberg beigetragen haben Nürnberg, im Mai 2022








